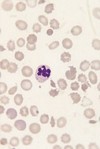

Haematology Flashcards
What is Virchow’s triad?
Vessel wall, blood, flow
What are the consequences of thromboembolism?
Death
Recurrence
Thrombophlebitic syndrome
Pul HTN
Blood in virchow’s triad
Viscosity: Hct, protein/paraprotein
Platelet count
Coagulation system: triggered by TF, generates thrombin, thrombin converts fibrinogen to fibrin (the clot)
Draw the blood coagulation pathway

How is the blood coagulation pathway regulated by thrombin? (draw)

How is the blood coagulation pathway regulated by Protein C? (draw)

What are the procoagulant factors?
Anticoagulant factors?

What is factor 5 Leidin?
Factor V Leiden thrombophilia[1] is a genetic disorder of blood clotting. Factor V Leiden is a variant (mutated form) of human factor V (one of several substances that helps blood clot) that causes an increase in blood clotting (hypercoagulability). In this disorder, the Leiden variant of factor V cannot be inactivated by the anticoagulant protein activated protein C, so clotting is encouraged. (With this mutation, the protein secreted that helps blood not clot is unable to do so, and therefore clotting is more likely) [2] Factor V Leiden is the most common hereditary hypercoagulability (prone to clotting) disorderamongst ethnic Europeans
What is the most common hereditary cause of hypercoagulability in ethnic Europeans?
FVL
Vessel wall in Virchow’s triad
Expresses anticoagulatn molecules: thrombomodulin, endoethlial protein C R, TF pathway inhibotr, heparans
Does not express TF
Secretes antiplatelet factors: prostacyclin, NO
What happens with vessel wall inflammation/injury?
Makes the wall prothrombotic
Can be caused by infection, malignancy, vasculitis, trauma
Effects: downregulation of anticoagulant factors (TM), upregulation of adhesion molecules, expression of TF, reduced production of prostacycline
What are the implications of thrombosis in Cancer?
l In the 12 months after idiopathic thrombosis, approximately 10% of patients will have cancer diagnosed.
lSimple tests, CXR, FBC, CRP, profile, urine will detect ~50% of these.
lMost malignancies presenting with thrombosis have a poor prognosis.
¨RR is ~7 for patients with active cancer
¨~ 20% of all VTE occur in patients with cancer
¨% incidence of VTE in year after cancer diagnosis
NB there is variation with type of cancer and extent of disease
Which cancer has largest effect on incidence of VTE?
Pancreas
How does stasis promote thrombosis?
Accumulation of activated factors
Promotes platelet adhesion
Promotes leukocyte adhesion and transmigration
Hypoxia produces inflammatory effect on endothelium
What are the causes of blood stasis?
Immobility: Sx, paraparesis, travel
Compression: tumour, pregnancy
Viscosity: polycythaemia, paraprotein
Congenital: vascular abnormalities
When does the risk of PE after air travel start?
3-6h
Greatest >12h
Implications of combined thrombotic risks
Thrombotic factors often combine to produce thrombosis, can have synergistic effect
Have powerful interactions which are unpredictable
e.g.
Pregnancy, increased VIII, fibrinogen, Decreased protein S, Flow
Malignancy: TF on tumour, inflam, flow
Sx: trauma, inflam, flow
What are the principles of managing VTE
ST prevention: during periods of high risk
Immediate treatment: preventing extension and embolisation
LT prevention
Anticoagulants
Anticoagulant therapy:
High dose?
Low dose?
High dose: therapeutic
Low dose: prophylactic
What are the traditional/standard anticoagulants?
Heparin: unfractioneated/LMWH/Direct acting anti-Xa and anti-IIa: IMMEDIATE
Warfarin: DELAYED
Administration of different types of heparin?
What are their actions?
Consequence?
Unfractionated: IV
LMWH: sub cut
Pentasacchadie: sub cut
All act by potentiating antithrombin
Provide immediate effect: e.g. for treatment of thrombosis, long term disadvantages include daily injections and risk of osteoporosis
Monitoring of heparin therapy?
LMWH: reliabl pharmacokinetics so not usually required except in renal failure, extemes of weight or risk, unusual conditions.
Monitor using anti-Xa
Unfractionated heparian: unreliable kinetics
Always moinotr therapeutic levels with APTT or anti-Xa
What are the anti-Xa direct acting anticoagulants?
Rivaroxaban, apixaban, edoxaban
What are the direct acting anti-IIa anticoagulants?
Dabigatran
What are the properties of the direct acting anticoagulants?
Oral
Immediate action peaak within 3-4h
Short t1/2
No monitoring
Limited licensed indications thus far
What is the use of Warfarin?
Action?
Therefore
What is the impact?
Given orally
Indirect effect by preventing Vit K recycling.
Therefore delayed onset of action
Levels of procoagulants falls: II, VII, IX, X
protein C and protien S (anticoagulant factors) also fall
Monitoring of Warfarin?
What are the issues with Warfarin therapy?
Implications in pregnancy?
Always essential through measuring INR. Derived from PT
Difficulty as Warfarin has numerous interactions e.g. dietary K, variable absorption, interaction with other drugs
Teratogenic
Action of heparin vs warfarin vs doac
Cofactor for AT vs Vit K antag vs direct enzyme inhibition
Reversal of heparin
warfarin
DOAC?
Protamine
Factor concentrate, vit K
none atm
Pregnancy: heparin
warfarin
DOAC
Heparin: safe
Warfarin: teratogenic
DOAC: no data- avoid
Who receives thromboprophylaxis?
People at risk: Sx, immobility, pregnancy, general medical inpatients
What is used for thromboprophylaxis?
And the features of each Rx?
LMWH: daily, e.g. tinzaparine 4500u/ Clexane 40mg
Rivaroxaban
TED stocking for Sx or if heparin contraindicated?
Bleeding risk assessment for anticoagulant therapy
Patient factors
Patient: bleeding diathesis, platelt count <100, acute CVA in prevous month (eith categrory)
BP >200 / >120
Severe liver disease
severe renal disease
Active bleeding
anticoagulant or antiplatelet therapy
Bleeding risk assessment for anticoagulant therapy
Procedure features
Neuro, spinal, eye Sx
Other with high bleeding risk
LP, spinal/ epi in previous 4 hours
What is essential for treatment of DVT/PE
What is the approach
Immediate anticoagulation
LMWH (175u/kg) + Warfarin (some NOACS e.g. rivaroxaban now lciensed). Stop LMWH when INR in therapeutic range
Continue for 3-6m
Patients with cancer continue LMWH not Warfarin
Elasticated stocking for 2y to prevent postphlebitic syndrome
Duration of LMWH/Warfarin based on cause
1st VTE, known cause:
3m
Duration of LMWH/Warfarin based on cause
Cancer
LMWH 3-6m
Duration of LMWH/Warfarin based on cause
1st VTE unknown cause
3-6m Warfarin, potentially lifelong
Duration of LMWH/Warfarin based on cause
1st VTE in thrombophilic patient
3m Warfarin
?lifelong
Duration of LMWH/Warfarin based on cause
Recurrent VTE
lifelong Warfarin
What may also be indicated following VTE?
TEDS to prevent postphlebitic syndrome
Use of thrombolysis in VTE
Only for life threatening PE or limb threating DVT
Risk fof ICH ~4%
Reduces subsequent post=phlebitic syndrome
PE/DVT risk of recurrence
Some studies suggest higher risk of recurrence with PE but some not
Generally VTE means increased risk of recurrence
Anticoagulation and recurrence after first VTE with minor precipitant (COCP, flights trauma) length of therapy
Generally 3m adequate
What are the inherited risk factors for VTE?
Antithrombin deficiency
Protein C D
Protein S D
Factor V Leiden, resistance to protein C
Prorthrombin
Lupus anticoagulant
Coag excess:
VIII (10%)
11 (2%),
Fibrinogen
What is the most common coagulant excess in inherited VTE?
Factor VIII (10%)
What are the acquired risk factors for VTE?
Age, obesity
Previous DVT, PE
Immobilisation
Major Sx, esp ortho. >30mins, plaster cast immobilisation
Long distance travel
Malignancy, esp pacnreas NB 10% idiopathic VTE due to Ca
Pregnancy, COCP, HRT
Antiphospholipid syndrome
Polycythaemia
Thrombocythaemia
What is antiphospholipid syndrome?
Antiphospholipid syndrome orantiphospholipid antibody syndrome (APS or APLS), or often also Hughes syndrome, is an autoimmune,hypercoagulable state caused by antiphospholipid antibodies. APS provokes blood clots (thrombosis) in both arteries andveins as well as pregnancy-related complications such asmiscarriage, stillbirth, preterm delivery, and severepreeclampsia.
Features of Heparin:
MOA
LMWH administration
Unfractionated administration
Antidote
SEs
Potentiates antibthrombin III which inactivates thrombin and factors 9, 10, 11
Given SC daily, does not require monitoring except late pregnancy and reanl failure
IV loading dose then infusion, monitor APTT
Antidote: protamine sulphate
Side effects: heparin induced thrombocytopaenia, osteoporosis (both more common with UFH)
Indications for target INR of 2.5?
1st episode DVT or PE, AF (2-3)
Cardiomyopathy, symptomatic inherited thrombophilia
Mural thrombus
Cardioversion
Indications for target INR 3.5?
Recurrent DVT or PE, mechanical prosthetic valve (2.5-3.5)
Coronary artery graft thrombosis
Antiphospholipid syndrome
Mx of INR 5-8 no bleeding
Withold doses, reduce maintenance, restart when INR <5
Mx of INR 5-8 minor bleeding
Stop warfarin, VIt K slow IV. Restart when INR <5
Mx INR >8 no bleed/minor bleed
Stop Warfarin
Vit K oral/IV
no bleeding/if risk factors for bleeding
Daily INR monitoring
Mx of major bleeding with raised INR including ICH
Stop warfarin
Give prothrombin complex concentrate
If unavailable give FFP
Also give Vit K IV
What is the relationship between Cancer and anaemia?
Give some examples of anaemia as the manifestation of malignancy
NB
Many causes for cancer associated anaemia
Many cases of anaemia are the first presentation of ca:
Fe deficiency
Anaemia of inflammation (chronic disease)
Leucoerythroblastic anaemia
Haemolytic anaemias: autoimmune, microangiopathic
Ca may also cause 2o polycythaemia e.g. RCC and HCC
Fe deficiency and cancer
Cause
Laboratory findings
Occult blood:
GI cancer: gastric, colonic/rectal
Urinary tract cancers: RCC, bladder
Reduced Ferritin, transferrin saturation
Raised TIBC
Fe deficiency is bleeding until proven otherwise
What is leucoerythoblastic anaemia?
Morphological features
Red and white cell precursor anaemia (variable degree of anaemia)
Morphological features: teardrop RBCs (+ aniso and poikilocytosis), Nucleated RBCs, immature myeloid cells
What does this blood film schow?

Leucoerythroblastic film
Tear drop poikilocytes
Nucleated RBC
Myelocyte
Outline the principle causes of a leucoerythroblastic film


What are the features of myelofibrosis?
Massive splenomegaly
Dry tap on BM aspirate
What are the common laboratory features of haemolytic anaemia of any aetiology?
Anaemia (may be compensated)
Reticulocytosis
Raised UNCONJUGATED bilirubin
Raised LDH
Reduced haptoglobins
What are the 2 pathogenci groups of haemolytic anaemia
Inherited: all due to defects of the red cell
Acquired: defects of the environment in which the red cell finds itself (except Paroxysmal Nocturnal Haemolytic anaemia)
What are the three components of of a red cell and how are they affected by iHA
Membrane
Spherocytosis, elliptocytosis
Hb:
Structural (SCD)
Quantitative (thallassaemias)
Enzymes:
G6PD
What are the only two types of acquired HA
What is the one test that distinguishes between them?
Immune
Non-immune
DAT (Coomb’s test)
What are the causes of immune HA?
Auto-immune: allo-immune/blood transfusion.
Spherocytes, DAT +ve
Associated systemic disorder:
Cancer of the immune system: lymphoma
Disease of hte immune system: SLE
Infection: disturbing the immune system
Features of autoimmune haemolysis
Positive DAT means?
Anaemia
Reticuloytosis
Raised LDH
Positive DAT
Either idiopathic or there is an underlying lymphoma/CLL/systemic autoimmune disease e.g. SLE
What are the two main causes of spherocytes
How can they be distinguished between
They are most commonly found in immunologically-mediated hemolytic anemias and in hereditary spherocytosis, but the former would have a positivedirect Coombs test and the latter would not. The misshapen but otherwise healthy red blood cells are mistaken by the spleen for old or damaged red blood cells and it thus constantly breaks them down, causing a cycle whereby the body destroys its own blood supply (auto-hemolysis).
What does this blood film show?

Spherocytes
What are the causes of acquired haemolytic anaemia: Non-Immune
Infection: Malaria
Micro-angiopathic HA
Red cell fragments
Low platelets
DIC/bleeding
Underlying adenocarcinoma
Features on this film
What does it show?
RBC fragments, thrombocytopenia
MAHA
Micro-angiopathy in malignancy (pathogenesis)
Adenocarcinomas, low grade DIC
Platelet consumption
Fibrin deposition and degradation
Red cell fragmentation
Bleeding
Jaundice/Anaemia/Raised LDH
How would you exclude or diagnose?
Lymphoma with liver involvement
Bilirubin conjugated/DAT negative/CT scan liver deposits/BM involved-infiltrated
Jaundice/Anaemia/Raised LDH
How would you exclude or diagnose?
Lymphoma with nodes compressing the bile duct
Bilirubin conjugated/DAT negative/CT scan nodes around porta-hepatis/BM involved-infiltrated
Jaundice/Anaemia/Raised LDH
How would you exclude or diagnose?
Lymphoma with auto immune haemolytic anaemia
Bilirubin Unconjugated/DAT positive/CT scan no liver deposits
What are the causes of true polycythaemia (raised red cell mass)
2o (raised EPO/inappropriate): HCC, bronchial Ca, RCC
Polycythaemia vera: clonal myeloproliferative disorder involving acquired mutaitons in JAK2
What are the types of WBC and where are they normal?
Mature
Phagocytes: granulocytes, monocytes
Immunocytes: lymphocytes
Immature
Normal in BM in an appropriate%, not normal in PB:
Blasts, promyelocytes, myelocytes
What does CLL involve?
WBC increased mature cells

CLL: Increased WBC mature cells

AML: increased immature cells in PB
What are the causes of neutrohilia?
Corticosteroids
Underlying neoplasia
Tissue inflammation e.g. colitis, pancreatitis
Myeloproliferative/leukaemic disorders
Infection
What are the causes of neutrophilia in infection?
Localised and systemic infections, acute bacterial, fungal and certain viral
What is characteristic of infection with brucella, typhoid and most viruses in terms of FBC
Characteristically do not produce a neutrophilia
What are the characteristics of a reactive neutrophilia?
Presence bands
Toxic granulation
Signs of infection/inflammation
What are the characteristics of a malignant neutrophilia
Neutrophilia basophilia plus immature cells and splenomegaly suggests myeloproliferative (CML)
Features of CML
Neutrophilia basophilia plus immature cells myelocytes, and splenomegaly. Suggest a myeloproliferative (CML)
Neutropenia plus myeloblasts=?
AML

Reactive neutrophilia

CML
What are the causes of a reactive eosinophilia?
Parasitic infestation
Allergic disease e.g. asthma, rheumatoid polyarteritis, pulmonary eosinophilia
Underllying neoplasms esp. Hodgkins, T-cell NHL
Drugs: erythema multiforme
What is a malignant cause of eosinophilia
Chronic eosinophilic leukaemia
Eosinophils part of the clone
FIP1L1-PDGFRa Fusion Gene found in?
Chronic eosinophilic leukaemia

Eosinophilia
Causes of monocytosis
Rare, seen in certain chronic infections and primary haematological disorders
Infections: TB, brucella, typhoid, vidal: CMV, VZV
Sarcoid
Chronic myelomonocytic leukaemia
What are the relevant investigations to interpret a lymphocytosis
Clinical: infection or lhymphoma? Lymphadenopathy or splenomegaly?
FBC: degree of lymphocytosis
Microscopy/morpology: mature vs immature
Flow cytometry: lineage- T or B cells. Stage of differentiation
Molecular genetics
Causes of reactive lymphocytosis
Infection: EBV, CMV, Toxoplasma, Infectious hepatitis, rubella, herpes
Autoimmune
Neoplasia
Sarcoid
Lymphocytosis
>3.5x109/l
What could this be?
- EBV viral infection
- early CLL

CLL

ALL
What is the principle of flow cytometry
Throughout B cell development, cells at differential stages express different surface antibodies.
Flow cytometry separates these cells on the basis of Ab expression
What is multiple myeloma?
Neoplastic proliferaiton of bone marrow plasma cells associated with a monoloncal protein in serum and or urine
Production of monoclonal Igs: paraprotein
IgG most common.
Middle-aged to elderly
Afrocarribean’s have increased incidence
CRAB
Clinical features of MM
Calcium high
Renal failure: plus amyloidosis and nephrotic syndrome
Anaemia (and pancytopenia)
Bone pain: osteoporosis, osteolytic lesions, fractures
+ Hyperviscosity syndrome
What are the features of symptomatic plasma cell myeloma
Monoclonal protein in the serum and or urine
Bone marrow clonal plasma cells or plasmacytoma
CRAB
What are the features of asymptomatic/smouldering myeloma
Monoclonal protein in serum at myeloma levels (>30g/l)
10% or more clonal plasma cells in BM
No related organ or tissue impairment
Px of myeloma
3y with conventional CTx
5y with autlogous stem cell transplation (cure)
Epidemiology of MM
M>F
Black>white
Doesn’t occur in children
70y/o median diagnosis
Increased incidence if first degree relative
Ix in MM
Dense narrow band on electrophoreisis
Rouleaux on blood film (RBC stacking)
Bence-Jones protein in urine
Raised ESR (+++)
>10% plasma cells in BM
Bence-Jones protein
MM
Staining in MM
H&E
Immune-peroxidase stain for CD138
Bony features of MM
Multiple sjulll lesions
Plasmacytoma: malignant plasma cell tumour growing within soft tissue
Osteopenia and wedge fractures of hte vertebrae
Serum protein electrophoresis
IgG 52%
IgA 22%
IgM 12
IgE rare
What is the staging system for MM?
Durie Salmon
What are the crtieria for the staging of Duire Salmon
Hb
Serum Ca
Bone disease
IgG
IgA
Urine light-chain M-component
Stages 1-3
International staging system (ISS):
B2-microglobulin
Albumin
Stage 1 MM
>10g/dl
No bone disease
IgG <50
IgA <30
<4mg urine light chain
<3.5B2 microglobulin
>35 albumin
Stage 3 MM
Hb <8.5
Raised Ca
Multiple lytic lesions in bone
>70g/dl IgG
>50g/l IgA
Urine light chain >12g
Raised B2 microgloublin
Hypoalbuminaemia

Multiple myeloma
What is MGUS?
Monoclonal gammaglobinopathy of unkown significance
<10% plasma cells in marrow
<30h/l monoclonal paraprotein
No CRAB
Incidental finding progressing to MM at 1-2%/year
No therapy needed at this stage
Monitor for transformation
What is smoldering MM?
Monoclonal gammaglobinopathy of unkown significance
>10% plasma cells in marrow
>30h/l monoclonal paraprotein
No CRAB
No therapy needed at this stage
Monitor for transformation
What is Waldenstrom’s Macroglobinaemia?
Lymphoplasmacytoid Lymphoma (PLL)
Elderly men
Low grade NHL: lymphoplasmacytoid cells produce monoclonal serum IgM that infiltrates the LNs and BM
Weight loss, fatigues, hyperviscosity syndrome
Treatment: plasmapheresis for hyperviscosity
Chlorambuicl, cyclophosphamide
What are the features of hyperviscosity syndrome?
Visual problems, confusion, CCF, muscle weakeness
What are the criteria for plasma cell leukaemia?
>2x10^9 plasma cells in peripheral blood
or
>20% of the leukocyte differential count
What are the features of systemic amyloidosis?
Ig light chains= paraprotein. Deposition of abn proteniacious substance in tissues
Diagnosed via cong-red: APPLE GREEN BIREFRINGENCE
Presents with macroglossia, carpal tunnel syndrome, peripheral neuropathy, RF
Treatment with CTx or auto-SCT
Cong red: apple green birefringence
Amyloidosis
What is MP?
6-mercaptopurine
What is VAD?
Vincristine
Doxorubicin
Dexamethasone
What is CTD?
Cyclophosphamide
Thalidomide
Dexamethasone
What is MPT?
Melphalan
Prednisolone
Thalidomide
What is the MOA of thalidomide in MM?
Immunomodulatory: alters expression of adhesion molecules, reduces TNF alpha and increases IL-10 leading to increased cell-mediated immunity
Inibits angiogenesis and promotes apoptosis of endothelial cells in established angiogenesis
Advantages: oral, synergistic effects in combination therapy. Used for relapsed myeloma
Toxic, dose-limiting
Side effects
What are the side effects of thalidomide?
Neuropathy
VTE
Somnolence
Consitpation
What is the MOA for Bortezomib
Inactivates Nf-kB by binding to the beta ring of 20S proteosome
Good activity, high and rapid response
Expensive, toxic
What are the toxic effects of Bortezomib?
Neuropathy
Systemic toxicity
What are some new drugs in the treatment of MM?
Thalidomide
Bortezomib
Lenalidomide
What is the therapy of choice in MM
Alkylating agent +/- prednisolone
Maintenance with IFN alpha
ASCT curative
Bisphosphonates reduce #s and bone pain
Treatment of bone disease in MM
Hypercalcaemia: IV fluids, steroids, bisphosphonates
Bone pain: pamidronate, zoledronic acid and clodronate.
What are the transplant options in MM?
Autologous SCT: treatment of choice for most patients. Collect stem cells and give high dose melphalan
Allogenic SCT: decreased deaths due to lower incidence, of infections and interstitial pneumonitis. Consider in patients under 50 with age matched sibling
What are the principle causes of mortality in pregnancy?
Genital tract sepsis
Eclampsia
VTE
Amniotic fluid embolism
Haemorrhage
Ectopic
What are the haematological demands of pregnancy
Iron: 300mg for fetus. 500mg for increased maternal cell mass. RDA30mg. WHO recommends 60mg/d
Folate: increased requirement due to growth and cell division. Additional 200mcg/d. WHO recommends 400mcg/d
RCOG folate recommendations
Before conception and for >12w gestation
400microg/d
What are the risks of Fe deficiency in pregnancy
IUGR
Prematuiry
PPH
What are the blood count changes in pregnancy?
Mild anaemia: dilutional effect, red cell mass rises 120-130%, plasma volume rises 150%
Macrocytosis: may be normal or due to folate or B12 deficicency
Thrombocytopenia (<150): can be physiological
Causes of thrombocytopenia in pregnancy
Physiological (gestational/incidental thrombocytopenia)
Pre-eclampsia
ITP
MAHA
OAll other causes
Increased platelet size
Plt <150 in pregnancy
Gestational most likely
then ITp
then PE
Plt <100 in pregnanc
Gestational most likely cause
then pre-ecl
then ITP
Plt <70 in pregnancy
ITP = Pre-ecl as most likely cause
Then gestational
Features of gestational thrombocytopenia
10% physiological decrease
Mechanism poorly defined
Either dilutional effect or increased consumption
Platelet count rises 2-5d post-partum
What are the plt cut offs for delivery/epidural
Delivery 50
Epidural 80
What are the features of thrombocytopenia in pre-ecl?
50% of pre-eclamptics get therombocytopenia proportional to severity
Due to increased activation and consumption
Associated with coagulation activation. Incipient DIC, normal PT and APTT.
Usually remits following delivery
Features of ITP in pregnancy
5% of thrombocytopenia in pregnancy. Can precede pregnancy and start early in gestation
Treatment of ITP in pregnancy
IV Ig
Steroids
Anti-D in Rhesus negative
Foetal effects of ITP
Unpredictable when <20
Check cord blood daily
What is MAHA?
Deposition of plt in small BVs.
Thrombocytopenia
Fragmentation and destruction within the vasculature, results in organ damage: Kidney, CNS (placenta)
Blood film in MAHA
Fragments
Low plt
Polychromasia (increased RBCs)
TTP and HUS in pregnancy
More common
Not helped by delivery
Usually earlier than HELLP, usually in 2nd trimester
What is the net effect of coagulation changes in pregnancy?
Procoagulant state:
Increased thrombin generation
Increased fibrin cleavage
Reduced fibrinolysis and interaction with other maternal factors leading to
Increased rate of thrombus
PE in pregnanc
Risk highest in 40-46w gestation/post-partum then 0-13w
Risks in pregnancy for VTE
BMI
FH
Bed rest
Pre-ecl
Operative delivery
Previous VTE
Thrombophilia
Age
Parity
Multiple pregnancy
Other medical problems
Hyperemesis gravidarum/dehdration.
OHSS
Unreltaed surgery
D-dimer in pregnancy
Already elevated
Useless
Complications of thrombophilia in pregnancy
Associated with impaired placental circulation
Results in:
IUGR, recurrent miscarriage, late foetal loss, placental abruption, severe Pre-ecl
Which thrombophilias are associated with pregnancy complications?
Antiphospholipid syndrome: recurrent miscarriage and persistent lupus anticoagulant/anticardiolipin Abs
AT PC and PS deficiency
FVL
High protthombin
Treatment of APLS
Aspirin
Heparin
What is the normal blood loss in
SVD
C-sec
300-500mL
900-1100mL
Def: PPH
>500mL after SVD
>1100mL after C-sec
DIC syndromes in pregnancy
DIC precipitated by amniotic fluid embolism
Placental abruption
Retained dead foetus
Pre-eclampsia
Sepsis
Why does DIC occur in amniotic fluid embolism?
Due to tissue factor in te amniotic fluid
Why is Hbopathy screening performed in pregnancy?
To avoid birthds of children with alpha0 thalassamie which die in utero or from hydrops fetalis
How is thalassaemia screening stratified?
Based on pregnant women FBC indices
FBC indices:
MCH <27: possible thalassameia trait
<25 requires DNA analyiss
Ethnic origin
Options if hbopathy identified in pregnancy?
Proceed
Prenatal Dx at 10-12 CVS
Amniocentesis
Foetal blood sampling
USS
Features of SCA and pregnancy
Painful crises become more frequent, anaemia is exaggerated and transfusions are often required
Also associated with:
Increased risks of hospital admission
Post-partum infection
IU foetal death
IUGR
Prematurity
Perinatal mortality
Pyelonephritis
Low birth weight
PROM
Pre term labour
Pre-ecl
What immune disorders are significant in pregnancy?
HDN Haemolytic disease of newborn
NAITP
What is NAITP?
Neonatal alloimmune thrombocytopenia: gaining of Abs to platelets from the mother’s circulation
Genetic differences lead to Ag expression on the foetal platelets.
Signs and symptoms of anaemia
Weakness
Pale
Tired
Cardiac failure
SOB
Orthopnea
PND
Swollen ankles
Lethargic
Decreased exercise times
Syncope
Palpitations
Tachycarida
Koilonychia (Fe def.)
Glossitis (B12 def)
Jaundice (haemolysis)
Pale mucous membranes
Cardiomegaly
CCF
Koilonychia in anaemia
Fe deficiency
Glossitis in anaemia
B12 deficiency
Jaundice in anaemia
Haemolysis
Causes of microcytic anaemia
Fe deficiency
Anaemia of chronic disease
Thalassaemia
Features of reticulotcytosis
Normal resposne to anaemia- haemolysis, haemorrhage and haematinics
Absent reticulocytosis if inadequate or bone barrow failure or after acute haemorrhage as takes 6 hours.
Pushes MCV up
What does reticulocytosis do to MCV?
Pushes t up
Features of Fe deficiency
Blood film: pencil cells, anisocytosis, poikilocytosis, hypochromic
Low ferritin, low transferrin saturation
Establish source of blood
Blood film: pencil cells, anisocytosis, poikilocytosis, hypochromic
Fe deficiency
Causes of pancytopenia
BM failure
Lymphoma/leukaemia
Aplastic anaemia
RTx, CTx
Myelofibrosis
B12/Folate deficiency
Ix of pancytopenia
Bone marrow aspirate
Blood film
B12 and folate levels
Ix of low platelets
Coagulation screen
Blood film
BM aspirate
ANA/RAPA/Antiplatelet Ab/HIV test
D-dimer
Fibrinogen
Blood cultures/CSF/MSU
LFTs
DIC=
Anaemia and thrombocytopenia
Mx of DIC
Antibiotics
Blood products; RBCs, platelets, croprecipitate, FFP
Regular bloods to assess response to products
Auer rod=
Accumulation of granules in myeloid cells
AML
How is testing of blood performed?
Use known anti-A, anti-B and anti-D reagents to test for ABO and RhD group
Positive test causes agglutination. If the RBCs have agglutinated they are seen at the top of the column
What are the methods for testing blood type?
Column agglutination
Abbreviated testing
Automated blood grouping
Ab screening
Abbreviated blood group testing
Blood added to card or tube and reacts with rapid reagents
Automated blood grouping
Bar coded samples with image analysis, quicker to interpret with no manual steps
What is the purpose of the antibody screen?
Need to identify clinically significant antibodies and transfuse Abs negative for that antigen.
Thisis to prevent delyed haemolytic transfusion reactions.
Can be done using the indirect antiglobulin technique. Test the pateint’s plasma with 2 or 3 RBCs that contain all the important antigens. Screen by incubating pateint’s plasma with screening cells
Cross-matching
Blood label: donor RBCs labelled with ABO + D type. And other Rh Ags and K
Select blood.
What is the IAT?
Patient plasma incubated with donor red cells at 37deg for 30-40mins
This will pick up antibody antigen reactions that could cause extravascular haemolysis. Need to add antiglobulin reagenet
Immediate spin cross matching
Saline, room T, incubate patients plasmawith donor cells for 5 minutes and spin. This will detect ABO incompatibility. IgM anti-A and or IgM anti-B will bind to RBCs, fix complement and cause cell lysis
What is electronic crossmatch
LIMS automatically determines compataibility without serological testing of donor cells against patient plasma
What is MSBOS
Negotiations between surgeons and transufion lab for predictable blood loss from surgery
Group and Save or Group and Crossmatch
Pt details
Indication for transfusion and urgency
Number of RBCs to crossmatch or group and save
Previous transfusions and date
Special requirements: irradiation, CMV negative
Location of patient
Handwrite on blood sample taken.
Methods of autologous blood transfusion
Pre-operative autologous deposit of blood, shelf life 5w, taken at weekly intervals with Fe supplementation.
Cell salvage: use a machine to suck up blood during surgery. Can’t do this if there is malignant or bacterial contaminant. Used in obstetric and vascular/bloody surgery
What is HDN
Person may form red cell Ab through blood transufion or if fetal cells enter woman’s circulation during pregnancy or delivery. Some Ags are more likely to form Abs than other
If maternal Ab level is high, it can destroy fetal red cells if they have corresponding red cell Ag. Leads to HDN (fetal anaemia and jaundice)
Only IgG can cross the placenta.
Anti-D often most responsible.
Other Ab= anti-C, anti-K, IgG ABO
Rhesus D isoimmunisation
1st preg: Rhesus +ve fetus: RhD positive foetal celss cross the placenta causing anti-D Abs to form
2nd pregnancy: Rhesus +ve foetus: moether is sensitised. Maternal anti-D crosses the placenta and coats foetal RhD +ve cells. Leads to their destruction in spleen and liver
What are the clinical features of rhesus disease in foetus
Foetal anaemia and HDFN: anaemia and high bilirubin.
Bilirubin accumulates after birth as it is no longer removed by the placenta
Hydrops foetalis
Kernicterus can result
Features of hydrops fetalis
Accumulation of oedema in at least two foetal compartments, can cause spontaneous abortion and heart failure
Kernicterus=
Bilirubin induced brain dysfunction
What are the methods to prevent rhesus disease
Prevent sensitisation in the first place
Anti-D antiglobuline
RAADP
Prevention of rhesus sensitisation
Transfuse RhD negative childbearing females with RhD negative blood.
Give IM injections of anti-D Ig at times when the mother is at risk of fetomaternal bleed
What is the timelit for anti-D to be given
72h
Doesn’t work if previous sensitisation
What are the different doses of anti-D used
<20/40: 250IU
>20/40: 500iU, larger doses are needed for larger bleeds to a FMH/Kleihauer test is conducted to determine the size of the bleed
Kleihauer-Betke test
Blood test used to measure the fetal Hb transferred from fetus to maternal blood stream and determine severity of bleed.
Acid bath removes adult Hb but not fetal Hb. Staining using Shephard’s method appear rose-pink while adult RBC seen as ghosts.
Percentage of fetal to maternal cells calculated
Kleihauer test, showing fetal red blood cells in rose-pink color, while adult red blood cells are only seen as “ghosts”.
Dosing for FMH
125iU/mL
RAADP
Routine antenatal anti-D prophylaxis for women who are rehsus D negative.
1% of pregnancies have no obvious sensitising event.
Routine anti-D prophylaxis is given in 3rd trimester
500iU at 28 and 34w
or 1500iU at 30w.
Routine management of Abs in pregnancy
Women undergo screen at 11 and 28w to check for RBC Abs
If Abs are present, quantify, check and monitor levels.
High or rising= more likely to affect the foetus
Monitor for HDFN through MCA Doppler USS
Deliver baby early as HDN gets worse in last few weeks fo gestation
in utero Mx of HDFN
Monitor using doppler USS
Deliver early
Intrauterine transfusions can be given
Monitor babies Hb and bilirubin at delivery and for several days after.
Transfuse to decrease bilirubin and increase Hb
Phototherapy
Subsequent pregnancies are usually worse
What other antibodies are implicated in HDN?
Anti-C: less severe.
Anti-kell: causes reticulocytopenia in foetus as well as haemolysis
IgG Anti-A and Anti-B Abs from group O mothers can cause mild HDN but not severe and can be treated with phototherapy
What is the difference between forawrd and reverse grouping?
Øuse known anti-A and anti-B and anti-D reagents against patient’s RBCs = FORWARD GROUP
Øand A and B reagent RBCs against patient’s plasma (contains IgM antibodies) = REVERSE GROUP
Indications for use of platelet as transfusion
Massive transfusion
Prevent bleeding post chemo
Prevent bleeding post surgery
Platelet dysfunction or immune cause
What is an adult treatment dose?
One unit of platelets
Raises platelet count by 30-40
When is a platelet transfusion contraindicated?
Heparin induced TP and TTP
Indications for FFP transfusion
Massive transfusion
DIC with bleeding
Liver disease + Risk
Not used to reverse warfarin
Draw causes of low plt count

Draw ABO blood groups

Draw anti-D doses

What is SHOT?
Serious hazards of transfusion
TRALI=
Transfusion related acute lung injury
TACO=
Transfusion associated circulatory overload
TAD=
Transfusion associated dyspnoea
PTP=
Post-transfusion purpura
How can adverse blood transfusion related events be prevented?
Bedside check
Use a giving set with a filter in the line
Don’t add drugs to blood
Don’t keep blood out of fridge for >30m without transfusion
Do routine obs during hte transfusion
Immediate clinical action in SHOT
Preventative action
ABC
Treat symptoms
Check blood components
Inform transfusion department
Take laboratory sampes
Contact local member of tranfusion team
Complete incident form
Take witness statements
Report to SHOT
Root cause analysis
Features of acute transfusion reaction
May start as rise in temp, pulse or fall in BP
Fever, rigors, flushing, vomiting, dyspnoea, pain at transfusion site, loin and chest pain, urticaria, itching, headache, collapse
Treatment of acute transfusion reaction
Severe: 2222. Take down components
Replace tranfusion with saline to keep the vein open, ABC, haem input
Mild: medical assistance, administer antihistamine or paracetamol (diuretics if fluid overload). Observe patient.
Features of FNHTR
During or soon after hte transfusion, rise in temp of 1 degree, chills and rigors
Slow/stop transfusion
Paracetamol
Caused by Abs against WBCs, less common with leukodepletion
Features of allergic reaction to blood transfusion
Common esp with plasma
Mild urticarial or itchy rash, sometimes with a wheeze. During or after transfusion. Stop or slow transfusion
Antihistamines
Cause: allergen is the donor plasma, so may not recurr dependant on the IgE specificity in the recipient. More common in recipients with hx of atopy
What are the most common reactions with RBCs?
Febrile
Allergy
Unclassified
Mixed allergic and febrile
Hypotensive
Anaphylactic
What are the most common ATR with platelets?
Allergic
Febrile
Anaphylactic
Mixed
Unclassified
Hypotensive
What are the most common ATRs with plasma?
Allergic
Anaphylactic
Febrile
Hypotnesive
Mixed febrile and hypotensive
What are the most common ATRs with mixed components?
Anaphylactic=allergic
Febrile=hypotensive
Then mixed allergic and febrile
Features of Wrong ABO ATR
Sings and symptoms of acute intravascular haemolysis: restlessness, chest/loin pain, fever, vomiting, flushing, collapse, Hburia.
Take samples for FBC, biochemistry, coagulation, repeat cross match and DAT.
Causes: failure of bedside check, wrongly labelled x-match sample, lab error
Features of anaphylaxis ATR
Severe life threatening reaction soon after hte start of the transfusion
Patient will be in hypotensive shock, breathless with wheeze and have laryngeal and facial oedema
Mech: IgE cross linking with mast cells leading to degranulation.
Caused by: previous exposure to Ag and development of an IgE antibodiy. Classically IgA deficiency or IgE Ab is passively transferred by the transfusion
What is the differnce between an anaphylactic and an anaphylactoid reaction?
Anaphylactic is IgE mediated
Features of IgA deficiency
Partial or total deficiency where anti-IgA Abs are more likely to develop.
Can be part of CVID and more commonly associated with infection and autoimmunity. Abs develop in response to sensitising event.
At greater risk of allergic transfusion reactions
Endogenous infection of blood products
Exogenous infection of blood products
Yersinia enterocolitica
Salmonella
E coli
Strep
Staphy
Pseudomonas
Serratia
Prevention of bacetial contamination of blood products
R/v blood product
Donor questioning
Screening of platelets occurs within 36h of donation and are held for further 6h nefore release
What is TRALI
Transfusion associated lung injury.
Acute dyspnoea with hypoxia and bilateral pulmonary infiltrates during or within 6h of tranfusion
Mechanism of TRALI
Donor anti-leucoyte Abs interact with patients WBC Ags which aggregate and stick in pulmonary capillaries
Results in release of neutrophil proteolytic enzymes and toxic oxygen metabolites which cause lung damage
Prevention is through using male donor plasm and avoiding plasma usage e.g. Warfarin reversal is using vit K.
What is TACO
Transfusion associated circulatory overload
Occuring within 6h of tranfusion:
Acute resp distress
Tachycardia
Raised BP
Acute or worsening pulmonary oedema
Evidence of positive fluid balance
Causes of TACO
Lack of attention to fluid balance.
Can be due to cardiac/renal failure or hypoabluminaemia.
Over transfusion
What is the impact of 1 unit of RBCs on recipient Hb?
Increases by 1g/dL
Check Hb after every 2 units
What is TAD?
Tranfusion associated dyspnoea
Respiratory distress within 24h of transfusion that does not meet the criteria of TRALI or TACO or allergic reaction.
What are the Cxs of massive blood transfusions
e.g. one blood volume in one day?
Hypothermia
Hyperkalaemia (as stored RBCs leak K)
Hypocalacaemia (as anticoagulant in each bag binds to Ca)
Air embolism
What are the features of delayed haemolytic transfusion reactions?
Lysis of red cells= raised bilirubin, decreased Hb, increased reticulocytes, Hburia over next few days.
Can occur to Kidd antigens, anti-D, K, Jk
Can cause renal failure
May require further transfusions
Do DAT
What are the intravascular symptoms of haemolytic transfusion reactions?
Extravascular?
Red/brown plasma and urine
Fall in Hb and jaundice
What are some other causes of haemolysis following transfusion?
Bacterial contamination
Mechanical damage
Addition of drugs incompatibile with IV fluids
What viruses are tested for in donor blood?
HBV, HCV, HIV, HTLV but NB window period for infeciton
Syphillis
CMV (removed through leiukodepletion)
Parvovrisu: can affect foetus and patients with haemolytic anaemia
What are the features of TA-GvHD
Rare but alway fatal.
Donor’s blood contains viable lymphocytes that are not recognised by host immune system in susceptible patients.
Donor lymphocytes recognise the Ags on patients gut, liver, skin, bone marrow and mount an immunological response
Causes severe diarrhoea, liver failure, skin desquamation, bone marrow failure
Who is susceptible to TA-GvHD?
Very immunosuppressed: SCT patients, CTx durgs e.g. fludarabine, Hodgkin’s foetus. Donor needs to be HLA matched for intrauterine transfusion. (HLA homozygosity)
Prevention of TA-GvHD
Identify at risk recipients
Irradiate donor blood to leukodeplete
Features of PTP
Purpura= pin prick red/purple blood spots due to very low platelets or vasculitis
Appears 7-10d post transfusion and can cause life-threatening bleeding.
Affects HPA-1a negative patients
Usually resolves in 1-4w
Sped by IV Ig
Need to be given HPA-1a negative platelets
Features of Fe overload in transfusions?
Lots of transfusions (>50) over time can lead to an accumulation of Fe.
This can cause organ damage, to hte liver, heart and endocrine system
Prevented through the use of Fe chelators e.g. desferioxamine once Fe >1000g.
Used in thalassaemia where patients have monthly transfusions
Draw SHOT: immediate and delayed

Draw symptoms of ATR

Draw fever vs allergic ATR

Def: lymphoma
Neoplastic tumour of lymphod tissue
Often found in LNs and BM. May spill into blood
Sometimes found in other lymphoid tssues e.g. spleen, MALT
Rarely found in skin (T-cell), CNS, testes, breast
Risk factors for lymphoma
No identifiable risk factor in majority of cases
Constant antigenic stimulation, infection and immunosuppression are known to contribute
H. pylori and lymphoma
Gastric MALT
Lymphoma
Sjogren’s and lyomha
Parotid lymphoma
Coeliac and lymphoma
small bowel T cell lymhoma
EATL (enteropathy associated T-cell lymphoma)
Viral causes of lyphoma
HTLV1
EBV
HIV
HTLV1 and lyphoma
Infects T cells by vertical/sexual transmission. May develop adults T-cell leukaemia lymphoma
EBV and lymphoma
EBV infects B lymphocytes. Carrier state regulated by healthy T cells.
Iatrogenic suppression of T cells e.g. transplantation regimens, leads to increased risk
HIV coinfection may also lead to deregulation of EBV infected B cells
Why are lymphocytes at risk of malignancy
Prolferative rate
Rely on apoptosis: 90% of lymphocytes die, apoptotsis switched off in germinal centre
Mutations: DNA undergoes deliberate mutations to generate Ig and TcR diversity.
Mutations and Ig in lymphoma
Ig promoter is highly active in B cells, if an intact oncogene is brought close to the Ig promoter, lymphoma may result.
NHL mutations: majority are translocations
What is the generative tissue in the lymphoreticular system
BM and thymus
What is the reactive LR tissue
LNs and spleen: develops immune reaction
What is the acquired LR tissue?
Extranodal lymphoid tissue e.g. skin, stomach, lung, to develop local immune reaction
LN features
Peripherally B cells
Centrally, T cells
Function of the B cell area in the LN
Forms a lymphoid follicle.
In the mantle zone there are naive unstimulated B lymphocytes
In the germinal centre, B cells mix with APC to select them and activate them
Diagnosis of lymphoma:
Morphology
Cytology
Histology
Diagnosis of lymphoma:
Immunophenotyping
T: CD3 and CD5
B: CD20
Examines cell distribution, loss of surface proteins, abnormal expression of proteins and clonality of B cell
Diagnosis of lymphoma:
Molecular pattern
FISH: for translocations
PCR
Diagnostic
Prognostic
Features of NHL
Most common 80-85%
All lymphomas but Hodgkins
>40 subtypes
NHL
presentation
Varies from subtype to subtype:
Painless lymphadenopathy often multilocular
Compression symptoms
B symptoms
No pain after ETOH
No pain after ETOH
NHL
How can NHL e classified
Mature vs immature
Histologically: high grade vs low grade
Lineage: B or T cell
Dx of NHL
Staging
Tissue biopsy, WHO subtype
CT scan, PET scan (in aggressive lymphomas)
BM biopsy
LP if risk of CNS
What are the prognostic markers in NHL
LDH and performance status
What are the high grade aggressive NHLs?
Burkitt’s
T or B cell lymphoblastic leukaemia/lymphoma
Diffuse large B-cell, mantle cell
Treated on acute leukaemia protocols
What are the low grade indolent lymphomas?
Follicular
marginal zone
Small lymphocytic
MALT
Features of Follicular lymphoma
B cell
Indolent
Mostly incurable: median survival 12-15y
t14:18 resulting in overexpression of anti-apoptosis protein Bcl-2
“Follicular pattern” “Nodular appearance”
t14:18 resulting in overexpression of anti-apoptosis protein Bcl-2
Follicular lymphoma
“Follicular pattern” “Nodular appearance”
Follicular lymphoma
Px in follicular lymphoma
Indolent but can transform to a high grade lymphoma
Mx of follicular lymphoma
Watch and wait
Rixucimab CVP
CVP
Cyclophosphamide
Vincristine
Prednisolone
Features of small lymphocytic lymphoma/CLL
Middle aged and elderly found in nodes or blood.
Small lymphocytes, naive or post-germinal centre memory B cells.
CD5 or 23
Indolent but can transform to high grade lymphoma
Featurs of mantle cell lymphoma
Middle-aged, M>F
Aggressive
Disseminated at presentation
Median survival 3-5y
t11:14 translocation.
Cyclin D1 deregulation
Angular nuclei
t11:14 translocation.
Cyclin D1 deregulation
Mantle cell lymphoma
Angular nuclei
Mantle cell lymphoma
Presentation of MALT
May present with dyspepsia or epigastric pain, B symptoms are uncommon
Treatment of MALT
Microbial dependent: remove antigen with tirple therapy. Can lead to remission in 75%
Microbial independent: CTx
Features of MALT
Marginal zone NHL found in middle aged.
Chronic antigen syimtulation:
H pylori-> gastric MALT
Djogrens-> Parotid lymphoma
What are the types of Burkitt’s
Endemic
Sporadic
Immunodeficiency
What is the histology in Burkitt’s
Starry sky
Features of Burkitt’s
Very aggressive
Fast growing
t8:14
c-myc overexpression, rapidly responsive to Rx
Rx in Brukitt’s
CTx: Rituximab + leukaemia protocol or SCT
Features of endemic Burkitt’s
Most common in equatorial Africa
EBV associated
Characteristic jaw involvement and abdominal masses
Features of sporadic Burkitts
Found outside Africa
EBV-associated
Jaw less commonly involved
Features of immunodeficiency Burkitts
Non-EBV associated
HIV/post-transplant patients
Features of Diffuse Large B cell lymphoma
Middle aged and elderly
Aggressive
Richter’s transformation
Other lymphomas occur secondary to DLBCL
“sheets of large lymphoid cells, germinal centre or post germinal centre B cells”
Germinal centre phenotype is a good prognostic factor
“sheets of large lymphoid cells, germinal centre or post germinal centre B cells”
DLBC
What are the components of the international prognostic indec for lymphoma?
Age >60
Serum LDH >normal
Performance status 2-4
Stage III-IV
More than one extranodal site
Rx of DLBC
Rituximab-CHOP
Auto-SCT for relapse
R-CHOP?
R- Rituximab: anti CD20 monoclonal antibody anti-B cell
Cyclophosphamide
Adriamycin
Vincristine
Prednisolone
MOA Rituximab
Anti CD20: anti B cell
Features of peripheral T-cell lymphoma
Middle aged and elderly
Aggressive
Large T cells with associated reactive cell population, especially eosinophils
Large T cells with associated reactive cell population, especially eosinophils
Peripheral T cell lymphoma
Features of adult T cell leukaemia/lymphoma
Carribean and Japan
Associated with HTLV-1 infection
Features of EATL
Associated with longstanding coeliac
Features of cutaenous T cell lymphoma
Associated with mycosis fungoides
Features of anaplastic large cell lymhpoma
Children and young adults
Aggressive
Large epitheloid lymphocytes
t2:5
Alk-1 protein expression (+ve= better Px)
Large epitheloid lymphocytes
Anaplastic large cell lymphoma
t2:5
Alk-1 protein expression (+ve= better Px)
Anaplastic large cell lymphoma
Reed-sternberg cell=
Hodgkins
binucleate/multinucleate owl-eyed cell on background of lyphomcytes and reactive cells=
Reed-Sternberg= HL

Reed-Sternberg cell
Clinical presentation of HL
Asymmetrical painless lymphadenopathy +/- obstructive/mass effect symptoms
Mediastinal mass, cough, respiratory infectoin, SVCO, dysphagia
Constitutional symptoms (incl pruritus)
Alcohol induced pain (rarely)
HL
Pel-Ebstein fever
Cyclical 1-2 weekly fever seen in HL
Epidemiology of HL
M>F
Bimodal age incidence: 20-29 and >60
Most common type of HL?
Nodular sclerosing, good Px causing peak incidence in young women
Ix in HL
CT/PET
Tissue dx: LN or BM biopsy, cell stain with CD15 and CD30
Reed-sternberg cell on a background of lymphocytes and reactive cells
Features of classical HL
Young and middle aged, often involving single LN and supradiaphragmatic
Thought to be germinal/post-germinal centre in origin
EBV and HLA DPB1 associated
Reed-Sternberg and Hodgkins cells
Richter’s transformation
Richter’s syndrome (RS), also known as Richter’s transformation, is a transformation which occurs in about 5-10% of B cell chronic lymphocytic leukemia (CLL)[1] and hairy cell leukemia into a fast-growing diffuse large B cell lymphoma, a variety of non-Hodgkin lymphoma which is refractory to treatment and carries a bad prognosis.[2]There is also a less common variant in which the CLL changes into a Hodgkin’s lymphoma. Rarely, transformations to a form of myeloid leukemia have been observed. These extraordinarily rare transformations carry a very poor prognosis. [3]Richter’s transformation affects about 5% of CLL patients at some point during their lives.[4]
EBV associated and HLA DPB1
Classical HL
Features of nodular lymphocyte predominant HL (NLPDHL)
Isolated lymphadenopathy
Germinal centre B cell
No EBV association
B cell richnodules with scattered L and H cells.
Can transform to high grade B cell lymhpoma
Staging of HL
1: one LN region (including spleen)
2: >2 LN regions on the same side of the diagram
3: >2 LN regions on different side of the diagram
4: Extranodal sites: BM, liver
A: no constitutional symptoms
B: constitutional symptoms

Mx of Hodgkins
Combination CTx used in most cases
RTx often used alongside CTx in large areas.
Intensive CTx and autologous SCT: relapsed patients
ABVD
Used in HL
Adriamycin
Bleomycin
Vinblastine
Decarbazine
Given at 4 weekly intervals
What are the issues for treating HL
Combination CTx and RTx increases the risk of secondary C
Features of Autologous SCT
Patients own SCs
Enbales high dose CTx and RTx to eradicate malignant cells
Frozen SCs then reintroduced into ptient
Used in MM and lymhpoma more than leukaemia
No risk of GvHD
Features of allogenic SCT
HLA-matched donor SCs are harvested
Patients own BM completely eradicated
Donors SCs are introducted
Used more in leukaemia
GvHD, risk of opprotunistic infections, infertility and secondary malignancies
Lymphoma tree

Draw NHL and the LN

Draw normal haematopoeisis

Draw the hierarchy of haematological malignancies

What are the myeloid malignancies?
AML (>20%)
Acute promyelocytic (like AML but more mature cells)
Myelodysplasia
Myeloproliferative
CML (mature cells)
What are the lymphoid malignancies?
Precursor cell: ALL
Mature cell:
CLL
MM
NHL and HL
What are type 1 mutations in haematological malignancies
Involved in cellular proliferation e.g. RtK
Activation of TK leads to expression in mature cells
RBCs: PCV
Platelets: thrombocytopenia
Granulocytes: CML
What is the BCR-ABL mutation seen in?
What type of mutation
CML
Type 1
What are type 2 mutations?
Prevent differentiation
Translocations create fusion genes
What is AML-ETO seen in?
What type of mutation?A
AML
Type 2
What is PML-RARA seen in?
What type of mutation?
APML
Type 2
What is t9:22
Philadelphia chromosome
Seen in CML
What is BCR-ABL
Fusion gene created in CML. Philadelphia chromosome
What is the philadelphia chromosome?
Mutation affecting GM-CSF causing proliferation of the granulocytes
Caused by activating tyrosine kinase mutation
Large numbers of differentiated neutrophils are present in the peripheral blood
Large numbers of differentiated neutrophils in peripheral blood with an increase in myelocytes and increased platelets
CML
Epidemiology of CML
M:F 1.4:1
40-60y/o
Symptoms of CML
Weight loss, lethargy, night sweats, splenomegaly, anaemia, bursing, bleeding and gout
Splenomegaly due to infiltration of cords and red pulp by granulocytes, if massive, infarction may occur
What are the phases of CML?
Bi or triphasic
Chronic phase: 5-6y stabilisation. 80% diagnosed here. <5% of cells in blood are blast cells.
Leucocytosis 500-5000 myeloid cells. Neutrophils and myelocytes no excess of myeloblasts
Bone marrow very hypercellular due to increased numbers of neutrophils and their precurorors
Accelerated phase: 6-12m. 10-19% of peripheral cells are blast cells
Blast crisis: 3-6m surivival. >20% blast cells.

Leucocytosis with mature myeloid cells
CML
Monitoring of CML
FBC and leucocyte count
Cytogenetics: philadelphia chromosome. RT-PCR of the ABL-BCR fusion transcript.
Haematological resposne: complete CHR WBC <10
Cytogenetic response: 0% philadelphia positive
Molecular: reduction in BCR-ABL transcripts.
Molecular most sensitive
Treament of CML
Need to target activated RtK: ABL kinase inhibitor
First line Rx in CML
RtK: Imatinib
93% survival at 60m
Second line Rx in CML
RtKI: dasatanib and nilotinib
Management of failure in CML
Monitor BCR-ABL transcripts, if rising some may respond to 2nd gen.
Failure of TKIs consider allogenic SCT (good survival in CP, extremely poor in blast crisis)
Pathogenesis of AML
Two hit model
T8:21 mutation resulting in AML-ETO fusion protein.
This is a tumour suprresor known as p14ARF
T8:21 mutation
AML
Management of AML
Supportive:red cell transfusions, platelet transfusions. Nurse in isolation, prompt antiboitcs.
Dx of AML
Morphology
Immunophenotyping: lineage and stage of differentation. Examine expression of antigens on cell surface.
Cytogenetics: chromosomal translocations
Molecular genetics: detection of fusion mRNA
Def: Acute Leukaemia
A neoplastic condition characterised by rapid onset, early death if untreated, immature blast cells and BM failure
What lineage of cells is affected in AML
Pluripotenet HSC or granulocyte/monocyte precursor
What lineage of cells is affected in CML
Pluripotent HSC
What lineage of cells is affected in B-ALL
B cell
What lineage of cells is affected in T-ALL
T cells
What lineage of cells is affected in CLL
Terminal B cell
Haematological definition of acute leukaemia
Immature blasts >20% BM cells
What are the clinical features of acute leukaemia
BM function failure: anaemia, thrombocytopenia, neutropenia
Organ infiltration: hepatomegaly, splenomegaly, lymphadenopathy, bone pain, CNS, skin, gum hypertrophy
Aetiology of acute leukaemia
Uinknown
Ionising radiotherapy
Cytotoxic drugs
Benzene
Pre-leukaemic disordres: myelodsplastic syndrome
DS: AML++
Neonates: often develop transient abnormal myelopoeisis
Which population group is affected by ALL?
Children
Children get it ALL
Which population group is affected by AML
Adulthood: risk increases with age
Infants <2
What are the clinical features of ALL
As for leukaemia but
Lymphadenopathy ++++
CNS involvement ++++
Testicular enlargement
Thymic enlargement
What are the clinical features of AML
As for leukaemia but
Lymphadenopathy less common.
What is acute promyelocytic anaemia?
Medical emergency
Prone to DIC
Ix in ALL
High WCC
Lymphocytes/precursors +++
Ix in AML
High WCC
Auer rods and granules
Myeloperoxidase and Sudan Black B stains
Auer rods
AML
T15:17 associated with
Acute promyelocytic leukaemia. Increased risk of DIC
What is classical AML
T15:17
Clinical features of Acute Monocytic leukaemia
CNS disease, skin infiltration, gum infiltration, organomegaly.
What is an issue with very high WCC?
Hyperviscosity.
What has a good prognosis in AML?
T15:!7
T 8:21
Intermediate and poor risk have normal/complex karyotypes and other chromosomal abnormalities
Treatment of AML
Supportive: RBC, platelest, FFP if DIC, antibiotics, long line. Allopurinol, U&Es monitoinrg
CTx:
Danorubicin and cytarabine. Combination therapy, non-overlapping toxicity with synergistic effect. 4-5 courses. remission induced in 2 courses and consolidated in 2-3 courses.
Allo-SCT in young or if poor prognosis.
CTx in AML
Daunorubicin and cytarabine
4-5 courses
Remission induction in first 2
Consolidation in 2-3 courses
When is the Px of ALL worse?
With increasing age
What are the features of B lineage ALL
Starts in bonw marrow, very strong association between genetics and prognosis
Poor prognosis associated with philadelphia chromosome
What are the features of T cells lineage ALL
Starts in thymus which amy become enlarged.
Treatment of ALL
(Ph +ve need imatinib)
Systemic chemotherapy and CNS directed therapy
Lasts 2-3 yeasr
Remission induction cycle
Consolidation and CNS therapy: intrathecal Ctx to treat occult CNS disease for 6-8 treatments. If lymphoblasts in CSF then more frequent and intesnive therapy required.
Intensification
Maintenance therapy
Consider allogenic SCT
Supportive:
Blood products, Abx, allopurinol, fluids, electrolytes (to prevent tumour lysis syndrome).
May require leukapharesis if extreme leukocytosis
CTx treatment of ALL
Systemic CTx and CNS directed therapy lasting 2-3 yeasrs with intrathecal CTx to treat occult CNS disease for 6-8 treatments.
Case 1: 5 yr boy. WCC 180 x 109/L, Hb 93 g/L, platelet 43 x 109/L. Thymic mass
WCC : diagnosis of leukaemia most likely.
o Low Hb and platelet – bone marrow infiltration.
Thymic mass: infiltration by T lymphoblasts.
Pathophysiology of Megaloblastic anaemia
DNA cannot be produced fast enought to allow cell division at the right time resulting in larger RBCs e.g. folate and B12 deficiency.
Associated with bone marrow features like meagloblasts, ovalocytes in the peripheral blood and hypersegmented neutrophils

Megaloblastic anaemia
What results in the production of codocytes/target cells?
Pathologies of the liber spleen which result in increased red cell membrane
What are the mechanisms of macrocytic anaemia
Megaloblastic anaemia
Red cell membrane disorders
Alcohol
Rapid cell turnover and reticulocytosis
Features of macrocytic anaemia caused by rapid red celll turnober and reticulocytosis
Diseases in which there is a high red cell production causes a greater proportion of reticulocytes (which are larger) e.g. COPD: low O2 levels induces production, traumatic loss, rapid haemolysis (G6PDD)
Normal RBC lifespan
120d
What is haemolysis?
Shortened red cell survival
Draw the classiciation of haemolytic anaemias

Causes of intravascular haemolysis
Malaria
G6PD
Mismatch
Cold Ab haemolytic syndromes
Drugs
MAHA: HUS, TTP, PNH
What are the MAHAs?
HUS, TTP, PNH
What are the extravascular causes of HA?
Autoimmune, alloimmune, hereditary and spherocytosis
What are the inherited causes of HA?
Membrane: cytoskeletal proteins, cation permeability
Red cell metabolism
Hb: thalassaemia, SCD, unstable Hb variants
What are the consequences of HA?
Anaemia
Erythroid hyperplasia with increased rate of RBC production and reticulocytes
Increased folate demand
Susceptibility to Parvovirus B19
Cholelithiasis: increased risk if inherited with Gilbert
Increased risk of Fe overload and osteoporosis
Fe overload can lead to hepatic siderosis
What is hepatic siderosis
Hemosiderosis (AmE) or haemosiderosis(BrE) is a form of iron overload disorderresulting in the accumulation ofhemosiderin.
Types include:
Transfusion hemosiderosis[1]
Idiopathic pulmonary hemosiderosis
Transfusional diabetes[2][3]
Hemosiderin deposition in the lungs is often seen after diffuse alveolar hemorrhage, which occurs in diseases such asGoodpasture’s syndrome, granulomatosis with polyangiitis, and idiopathic pulmonary hemosiderosis. Mitral stenosis can also lead to pulmonary hemosiderosis. Hemosiderin collects throughout the body inhemochromatosis. Hemosiderin deposition in the liver is a common feature of hemochromatosis and is the cause of liver failure in the disease. Selective iron deposition in the beta cells of pancreatic islets leads to diabetes[1] [2] due to distribution of transferrin receptor on the beta cells of islets [3] and in the skin leads to hyperpigmentation. Hemosiderin deposition in the brain is seen after bleeds from any source, including chronic subdural hemorrhage, Cerebral arteriovenous malformations,cavernous hemangiomata. Hemosiderin collects in the skin and is slowly removed after bruising; hemosiderin may remain in some conditions such as stasis dermatitis. Hemosiderin in the kidneys has been associated with marked hemolysis and a rare blood disorder called paroxysmal nocturnal hemoglobinuria.
Hemosiderin may deposit in diseases associated with iron overload. These diseases are typically diseases in which chronic blood loss requires frequent blood transfusions, such as sickle cell anemia and thalassemia, though beta thalassemia minor has been associated with hemosiderin deposits in the liver in those with non-alcoholic fatty liver disease independent of any transfusions.[4][5]
Consequences of all haemolytic anaemias
Rasised (unconjugated) bilirubin
Raised urobilinogen
Raised LDH
Reticuylocytosis (raised MCV and polychromasia)
May have gallstone
Consequences of intravascular HA
Raised free plasma Hp
Decreased haptoglobins (bind Hb)
Hburia dark red urine
Methaemalbuminaemia (Hb and albumin in blood)
Consequences of extravascular HA
Splenomegaly
Clinical features of HA
Pallor, jaundice, splenomegaly, pigmenturia, Fhx
What are the inherited membrane defects causing HA
Hereditary spherocytosis
Hereditary elliptocytosis
Southe East Asian Ovalocytosis
Hereditray pyropoikilocytosis
What is the inheritance pattern of HS?
AD
What are the features of hereditary spherocytosis
Ankyrin or spectrrin deficiency
Mechanical abnromality acoompanied by osmotic changes
Susceptibility to parvovirus B19 and develop gallstones
Extravascular haemolysis: splenomegaly.
Spherocytes, increased osmotic fragility, -ve DAT, flow cytometry
Spherocytes, increased osmotic fragility, -ve DAT, flow cytometry
Hereditary spherocytosis
Why does hereditary spherocytosis cause splenomegaly?
Beacuse it is extravascular HA
What is the osmotic fragility test
Hypotonic saline-> lysis.

Hereditary spherocytosis
Treatment of hereditary spherocytosis
Splenectomy
Folic acid
What does a negative Coomb’s test tell you?
That the HA is not immune mediated
What interactions are disrupted in spherocytosis?
Vertical interactions.
What is the most common cause of hereditary spherocytosis
Mutation in Ankyrin
What population commonly affected by HS?
Hereditary spherocytosis is the most common disorder of the red cell membrane and affects 1 in 2,000 people of Northern European ancestry
Minkowski–Chauffard syndrome
Hereditary spherocytosis
Reduced binding of dye eosin-5-maleimide?
Hereditary spherocytosis
Inheritance of elliptocytosis
AD
What is the msot common cause of hereditary ellliptocytosis?
Spectrin mutaiton (alpha)
What are the features of hereditrary elliptocytosis?
Mechanical dysfunction without osmot changes
Severity of disease ranges from hydrops foetalis to asymptomatic
Disruption of horixontal interactions
What is the inheritance of hereditary pyropoikilocytosis?
AR
What are the features of hereditrary pyropoikilocytosis?
AR
Abnormal sensitivity to heat causing haemolysis
Considered a special form of elliptocytosis

Hereditary elliptocytosis

Hereditary pyropoikilocytosis

SEA Ovalocytosis
What are the features of SEA ovalocytosis?
Form of hereditary elliptocytosis most common in Malaysia and papau new guinea.
Confers some protection to M. falciparum
Macro-ovalocytes with one or two slits in 20-50% of the cells.
Heterozygotes asymptomatic, homozygosity presumed lethal
What is the commonest RBC enzyme defect?
G6PD
What are the features of G6PDD
Prevalent in areas of malarial endemicity
Most common RBC enzyme defect- X linked.
Attacks: rapid anaemia and jaundice with bite cells and Heinz bodies (blue deposit= oxidised Hb)
What is the function of G6PD
G6PD catalyses the first step in the pentose phosphate pathway which generates NADPH which is required to maintain intracellular glutathione. GSH is an antioxidant and protexts cellular components
What are the clinical effects of G6PDD
Neonatal jaundice
Acute haemolysis (triggered by oxidants/infection)
Chronic haemolyic anaemia
What is the clinical course of G6pD?
Steady state is asymptomatic
Acute haemolysis occurs due to oxidant stress
What type of HA is G6PD?
Intravascular
What factors may precipitate HA attack in G6PD?
Drugs:
primaquine (antimalarial), sulphonamides, ciprofloxacin, nitrofurantoin (antibiotics), other drugs: dapsone, Vit K. Broad beans (fava beans), moth balls). Acute stressors e.g. infection
Treatment of G6PD
Avoid precipitants
Transfuse if severe
Genetic subtypes give chronic haemolysis for which splenectomy is a good treatment
Heinz bodies
Seen when stained with methylene blue.
Formed by Hb damage by oxidants
G6PD
What population commonly affected by G6PDD?
African, mediterranean, middle eastern
What is the inheritance of pyruvate kinase deficiency?
Autosomal recessive but AD has been observed
What is pyruvate kinase?
Most common enzyme deficiency of the glycolytic pathway.
What are the cliniical features of pyruvate kianse deficiency
HA of varying severity
Can cause severe neonatal jaundice and splneomegaly
Pathophysiological of pyruvate kinase deficiency
ATP depltion
Loss of K through lack of ATP impairing Na/K ATPase and loss of H2O
Dehydrated and rigid cells and destruction of poorly deformable cells.
Spleenctomy to treat
Mx of HAs?
Folic acid supplementaitons
Avodi precipitating factors
RBC transfusion/exchange
Immunisation against BBV
Monitor for chronic cxs
Cholecystectomy for symptomatic gallstones
Splenectomy if indicated
What are the indications for splenectomy in HA?
PK deficiency and some other enzymopathies
HS
Severe elliptocytosis and pyropoikilocytosis, thalassaemia, immune HA
Also if transfusion dependant, grwoth delay, physical limitaiton, Hb <8, hypersplenism
Don’t do under 3y/o but do before 10y/o to maximise prepubertal growth.
Risk of overwhelming sepsis
Features of SCD
AR
Single base mutaiton; GAG-GTG. Glu-> Val at codon 6 on beta chain.
Leads to HbS instead of HbA
What is the pathophysiology of HbS?
GAG->GTG
Glu-Val at codon 6 of beta chain
Which Hb chain does SCD affect?
beta
What are the possible genotypes and their phenotypes in SCD
HbSS: severe
HbAS: sickle cell trait, usually asymptomatic.
Rarer forms:
HbSC: Sickle cell HbC disease.(HbC has defective beta chain)
HbS/beta: Sickle Beta thalassaemia.
Why does sickle cell anaemia manifest at 3-6m?
Coincides with decreasing fetal Hb (HbF)
What is the pathophysiological mechanism for sickling?
Reduced O2 tension leads to HbS polymerisation and subsequent sickling
What are the important features of SCA?
Anaemia 60-80g/L
Splenomegaly
Foalte deficiency
Gallstones
Aplastic crises (parvovirus B19)
What are the vaso-occlusive features of Sickle-cell disease?
SICKLED
Stroke
Infections (hyposplenism, CKD)
Crises
Kidney: papillary necrosis, nephrotic syndrome
Liver: gallstones
Eyes: retinopathy
Dactilitis: impaired growth
Mesenteric iscahemic
Priapism
What are the clinical features of a sickle cell crisis?
Splenic sequestration
Chest and pain
How does the age of onset of SCD affect px
Child: strokes, splenomegaly, splenic crises and dactylitis.
Teens: impaired growth, gallstones, psych, priapism
Adult: hyposplenism, CKD, retinopathy, pulmonary HTN
Dx of SCD
Sickle cells and target cells on blood film
Sickle solubility test
Hb electrophoreisis
Guthrie to test to aid prompt pneuomococcal prophylaxis
Treatment of sickle cell disease
Analgesia for painful crises
Folic ACid
Penicllin V
Pneumovax
HiB vaccine
Hydroxycarbamide
Carotid doppler monitoring in early childhood with prophlyactic exchange transfusion if turbulent carotid flow
Mechanism of hydroxycarbamide in SCD
Promotes production of HbF
What is the pathology of thalassaemias?
Unbalanced Hb synthesis-> unmatched globins precipitate-> haemolysis and ineffective erythropoeisis
What are the features of beta thalassaemia?
Point mutations leading to reduced beta chain synthesis, excess alpha cahins
Raised HbA2 and HbF
What are the signs of beta-thalassaemia?
Skull bossing, maxillary hypertrophy, hairs on end skull XR

In severely affected patients, a widening of the diploic space (medulla) with a thinning of the tables (cortices) occurs, frequently with complete obliteration of the outer table. New bone forms in response to marrow proliferation beneath the periosteum. These bony spicules may be seen radiographically and result in a classic “hair-on-end” appearance. Because it lacks hematopoietic marrow, the occipital bone usually is not involved. (See the image below.)
What are the different types of beta thalassaemia?
Minor
Intermedia
Major
What are the features of beta thalassaemia minor
Heteroztgous
Asmptomatic carrier
Mild anaemia
What are the features of beta thalassaemia intermedia?
Moderate anaemia
Splenomegaly
Bony deformity
Gallstones
What are the features of beta thalassaemia major
Homoxygous
3-6m severe anaemia
FTT
Hepatosplenomegaly
Bony deformity
Severe anaemia
Heart failure
Mx of beta thalassaemia
Blood transfusions
Desferrioxamine
Folic acid
Features of alpha thalasasaemia
Deletions in alpha chain of Hb: reduced synthesis and excess beta chains
Therea re 4 alpha genes, severity depends on number of genes deleted
A thalassaemia trait
1/2 alpha genes deleted
Asymptomatic/ mild anaemia
HbH
3 alpha chains deleted
Moderate anaemia
Splenomegaly
4 alpha chains deleted
Hydrops foetalis- incompatibble with life
What are the two tpyes of autoimmune HAs?
Warm and Cold
What is the most common AIHA?
Warm
What are the features of WAIHA?
37 degress
IgG
Positive Coomb’s
Spherocytes on blood film
What Ig is associated with WAIHA?
IgG
What are the features of cold agglutinin disease?
<37
IgM
Positive Coomb’s
Associated with Raynaud’s
What Ig in cold agglutinin disease?
IgM
What are the causes of WAIHA
Mainly idiopathic
Lymphoma, CLL, SLE, methyldopa
Mx of WAIHA?
Steroids
Splenectomy
Immunosuppression
Mx of cold agglutinin disease?
Treat underlying condition
Avoid the cold
Chlorambucil
What is PCH?
Paroxysmal cold haemoglobinuria
What are the features of PCH?
Hb in the urine usually caused by a viral infection e.g. measles, syphillis, VZV
Donath-Landsteiner Abs-> stick to RBCs in cold, lead to complement mediated haemolysis on reqarming.
Donath-Landsteiner Abs seen in?
Paroxysmal cold haemoglobinuria
What are the features of PNH
Acquired loss of protective surface GPI markers on RBCs (platelets and neutrophil) leads to complement mediated lysis.
This results in a chronic intravascular haemolysis, especially at night.
What are the symptoms of PNH
Morning haemoglobinuria
Thrombosis (+ Budd Chiari syndrome)
Dx of PNH
Immunophenotype shows altered GPI or Ham’s test
What is Ham’s test?
In vitro acid induced lysis
Seen in PNH
What is the treatment of PNH?
Iron/folate supplements
Prophlyactic vaccines/antibodies
Monocloncal abs e.g. eculizumab that prevents complement from binding RBCs
What is the pathology of MAHA
Mechanical RBC destruction: forcedthrough fibrin/plt mesh in damaged vessels leading to schisotcytes
Schistocytes=
Seen in?
RBC fragments
MAHA
What are the causes of MAHA
HUS
TTP
DIC
Pre-ecl
Rx in MAHA
PLEX
What is the pentad of TTP?
MAHA
Renal impairment
Fever
Neurological abnromalities
Thrombocytopenia
What are the features of HUS
Caused by E coli
Toxin damages endothelial cells-> MAHA
Diarrhoea
Renal failure
No neuro problems
Affects children and elderly
What is the commonest leukaemia in te western world?
B Cell CLL
Def: B Cell CLL
Proliferation of mature non-functioning B lymphocytes
Epidoemiology of CLL
Caucasian and black population 20-30x more than Inidian, China, Japan
65-70y/o
40% of all leukaemias in people over 65
1/3rd >?75, 1/3rd< 65 1/3rd in between
Natural history of CLL
Progressive accumulation of mature malignant B lymphocyts
Takes decades and may be a coincidental laboratory finding although can also present acutely
What are the clinical issues with CLL
Proliferation in BM-> failure
Circulation in the nodes and spleen-> lymphadenopathy
Acquisition of further mutations can lead to a transformation to a high grade lymphoma
Can lead to autoimmune problems e.g. HA
Where is CLL primarily seen?
BM
Where is Small lymphocytic lymphoma seen?
LNs
Clinical presentation of CLL
Incidental finding in routine bloods (80%)
Symmetrical painless lymphadenopathy
Splenomegaly
BM failure: anaemia & thrombocytopenia, recurrent infections
B symptoms: fevers, night sweats, weight loss
Associated with autoimmunity: AIHA, ITP
Can progress to a form of lymphoma (DLBC)- Richter’s transformation
What is Richter’s transformation?
Richter’s syndrome (RS), also known as Richter’s transformation, is atransformation which occurs in about 5-10% of B cell chronic lymphocytic leukemia (CLL) and hairy cell leukemia into a fast-growing diffuse large B cell lymphoma, a variety of non-Hodgkin lymphoma which is refractory to treatment and carries a bad Px
Ix in CLL
WCC: persistent lymphocytosis >5: morphology, immunophenotyping, cytogenetics. Composed of small mature lymphocytes
Low serum Ig
Smear cells seen on blood film
Abnormal BM: lymphocytic replacement of normal marrow
May also find immuneparesis and paraptroteins
Smear cell
CLL

CLL
Smear cell are cells that are damaged due to peripheral blood smear
Due to reduced strength of abnormal white cells in CLL
Dx of CLL
Dx: small mature lymphocytes with smear cells
Immunophenotyping
Dx: lymphocytosis >5, smear cells, immunophenotyping: CD5 positive, CLL score
DDx of CLL
CLL/SLL
Mantle cell lymphoma
Good prognositc factors in CLL
Hypermutated IgG
Low Zap-70 expression
13q14 deletion
Bad prognostic factors in CLL
Raised LDH
CD38+ve
11q23 del
Px of CLL
50% of patients die of an unreleated cause
Incurable by CTx
No benefit to early treatment
How can CLL be staged?
Binet and Rai Staging
How is CLL stgaed using Binet
A
B
C
Binet A
<3 lymphoid areas
Binet B
>3 lymphoid areas
Binet C
Hb <10
Plt <100
How is CLL staged using Rai staging
0 - IV
Rai Stage 0
Lymphocytosis only
Low risk
Rai Stage I
Lymphadenopathy
Rai Stage II
Intermediate risk
Hepatosplenomegaly +/- lymphadenopathy
Rai Stage III
High Risk
Hb <11
Rai Stage IV
plt <100
ZAP70/CD38
Detected in CLL by immunophenotyping
Expression correlates with Ig status. Bad prognostic feature
What is the worst prognositc facture in cytogenetics for CLL?
-17p (p53)
Rx in CLL
Supportive treatment
Treatment of complications: immune haemolysis, disease transformation
CTx:
Stage A: conventional not to treat. Indications for treatment include BM failure, major or progressive lymphadenoapthy, progressive lymphocytosis, systemic symptoms, autoimmune cytopenias
CTx in CLL
First line: FCR (fludarbine, cyclophosphamide, rituxmiab)
Oral chlorambucil for slow goa nd no go
17p needs different therapy
2nd line for <60y: consider allograft
What is used for p53 mutated CLL
Campath/alemtuzumab
Auotimmune complications of CLL
AIHA
Autoimmune thrombocytopenia
Neutropenia
Pure red cell aplsia
Mx with steroids
PRCA
Pure red cell aplasia (PRCA) orerythroblastopenia refers to a type ofanemia affecting the precursors to red blood cells but not to white blood cells. In PRCA, the bone marrow ceases to produce red blood cells.
Mx of high grade transformation in CLL
LN biopsy
CHOP-R
Mx of infection risk in CLL
Prophylaxis and treatment of infection
Antibiotics
PCP rpophylaxis for those eceiving FDA or campath
IvIG for those with hypogammaglobulinaemia
Pneumovax and HiB
Def: myelodysplastic syndromes
Biologically heterogeneous group of acquired HSCT disorders
Characterised by:
the development of aclone of marrow stem cells with abnromal maturation resulting in:
functionally defective blood cells and numerical reduction
Cytopenias
Functional abnromaltieies of erythroid, myeloid and megakaryocyte maturation
Increased risk of transformation to AML
Typically a disorder of the elderly
Blasts in myelodysplastic syndromes?
<20
If it were greater than >20 it would be a leukaemia
Clinical features of MDS?
Bm failure and cytopenias: infection, bleeding, fatigue
Hypercellular BM
Defective cells:
RBC: ring sederoblasts
WBC: hyogranulationn, pseudo Pelget Huet anomaly
PLatelets: micromegakaryotcytes, hyoablated nuclei
What is Pelger-Huet anomaly
Neutrophil with bilobed Pelgroid nuclei.
Look identical to those seen in the inherited Pelger-Huet anomaly.
Neutrophil has markedly reduced granulation.

Pelger-Huet Anomaly
Abnormality in neutrophils seen in MDS
What are the abnormal bone marrow morphologies seen in MDS
Pelger Huet abnromaltiy
Dysgranulopoeisis of neutrophils
Myelokathexis of neutrophils and precursors (retention in BM)
Dyserythropoeisis
Dysplastic megakaryocytes
Increased proportion of blast cells
Ringed sideroblasts
What are ringed sideroblasts?
Seen in refractory anaemia
Prussian blue stain of bone marrow shows blue staind haemosiderin deposits in the mitochondria of erythroid precurors forming an apparent ring around the nucleus

Ringed sideroblasts
Seen in refractory anaemia
Prussian blue stain of bone marrow shows blue staind haemosiderin deposits in the mitochondria of erythroid precurors forming an apparent ring around the nucleus

Auer rod
AML

Myelokathexis
Bone marrow smear from a patient with neutropenia due to myelokathexis
How can MDS be classified?
Marrow: dysplasia (? hypercellular)
RAEB-I
RAEB-II
Blood: cytopenias/defective cells
RA +/- RS (RARS)
RCMD
RCMD-RS
MDS 5q-
MDS unclassified
Presentation of RA
Presents with anaemia
Can be with (RARS) or without ringed sideroblasts
What is RCMD?
Refractory cytopenia with multilineage dysplasia
Presents with bicytopenia or pancytopenia
What is RAEB-I
Refractory anaemia with excess blasts
BM blasts 5-10%
RAEB-II
BM blasts 11-20%
What is the presentation of MDS 5q-
Anaemia with normal platelets
What is unclassified MDS
Presents with neutropenia or thrombocytopenia
MDS with fibrosis, childhood MDS etc.
What is RAEB-T
Refractory anaemia with excess blasts in transofmration
Characterised by 21-30% myeloblasts in the marrow
Now considered AML
How can MDS Px be scored?
International prognostic scoring system in MDS
BM blast %
Karyotype
Cytopenia
High risk >2.5
What occurs in myelodysplasia evolution?
Deterioriation of blood counts- indicative of worseing consequence of marrow failure
Development of AML (50% in <1y). AML from MDS has a much poorer prognosis and is not curable
1/3rd die from infection, 1/3rd from bleeding, 1/3rd from leukaemia
Treatment of MDS
Supportive: blood products, EPO, G-CSF, Abx
Biological modifiers: immunoscupressive therapy: lenalidomide, cytosine analgoue
CTx: similar to AML
Can also use hydroxyurea
Allogenic SCT
What is azacytidine?
Cytosine analogue
What is lenalidomide?
Thalidomide derivative. Anti-angiogenic, anti-tumour via apoptosis and anti-osetoclastogenic.
Used in MDS
What causes bone marrow failure
Damage or suppression of stem (all peripheral bloood lines affected)
or progenitor cells (bi or unicytopenias
How can BM failure be classified
Priamry
Secondary
What are some primary causes of BM failure?
Congenital: Faconi’s anaemia
Diamond-Blackfan anaemia
Kostmann’s syndrome
Acquired: idiopathic aplastic anaemia (mutlipotent stem cell)
What are the secondary causes of bone marrow failure?
Marrow infiltration
Haematological: leukaemias etc.
Non-haematological: solid tumours
RTx
Chemicals: benzenes
What drugs can cause bone marrow fialure?
Predicatble: cytotoxic in dose-dependant fashion
Idiosyncratic: phyenlybutazone, gold salts (not dose dependant)
Abx: chloramphenicol, sulphonamide
Carbimazole, thiazides
Def: aplastic anaemia
Inability of BM to produce red blood cells
HSC numbesr are reduced in BM
AA typically refers to just anaemia however these patients can also have a pancytopenia.
Symptoms relate to each cytopaenia
Patients typicallly present with bleeding problems
Can present at any age
With what conditions is aplastic anaemia linked?
Leukaemia, PNH
How can AA be classified?
Primary
Secondary
What are the primary causes of AA
Idiopathic (70%): humoral or T cell attack against multipotent HSC
Inherited: dyskeratosis congenita, FA, Schwaman diamond syndrome
What are the secondary causes of AA?
Due to malignant infiltration
Radiation
Durgs
Viruses
CTx
SLE
Def: severe aplastic anaemia
2/3 of the following peripheral blood features:
<1% reticulocytes (<20x10^9)
Neutrophils (<0.5)
Plt (<20)
BM <20% cellularity
DDx for pancytopenia and hypocellular marrow
Hypoplastic MDS/AML
Hypocellular ALL
Hairy cell leukaemia
Mycobacterial infection (atypical)
Anorexia
ITP
What is NSAA?
Non-severe aplastic anaemia
What is the clinical presentaiton of aplastic anaemia?
Classical triad:
Anaemia: breathlessness fatigue
Leukopenia: infections
Plt: easy brusing/bleeding
Mx of aplastic anaemia
Supportive: blood products, antibitoics, Fe chelation
Marrow recovery drugs: oxymetholone, grwoth factors
Immunosuppressive therapy
SCT: young patietns iw th adonor
Cxs of immunosuppressive therapy in AA?
Relapse of AA
Clonal haematological disorders: MDS and leukaemia.
PNH
What are the inherited BM failure syndromes causing pancytopenias?
Fanconi Anaemia
Dyskeratosis congenita
Schwachman-Diamond syndrome
Familial aplastic anaemia (autosomal and X linked forms)
Myelodysplasia
Non-haematological syndormes e.g. DS, Dubowitz’s
What are the inherited BM failure syndromes causing single cytopenias?
Diamond-Blackfan syndrome
Kostmann’s syndrome
Schwchman diamond syndrome
Reticular dysgenesis
Amegakaryocytic thrombocytopenia with abenst radii
What is the inheritance of Fanconi anaemia
AR
What are the features of Fanconi anaemia
Presents at 5-10yrs
Pancytopenia
Skeletal abnormalities: radii, thumbs, renal malformations, microopthalmia, short stature, skin pigmentation
MDS (30%), AML risk (10% progress)

Fanconi anaemia
Cxs of fanconi anaemia
Aplastic anaemia
Leukaemia
Liver disease
Myelodisplasia
Cancer (epithelial)
What are the features of dyskeratosis congenita
X-linked
Chromosome instability (telomere shortening)
Skin pigmentation
Nail dystrophy
Oral leukoplakia
BM failure
Nail dystrophy
Skin pigmentation
Oral leukoplakia
Triad seen in Dyskeratosis congenita

Dyskeratosis congenita
Features of Schwachman-Diamond syndrome
AR
Primarily neutropenia
Skeletal abnormalities, endocrine and pancreatic dysfunction, hepatic impairment, short stature
AML risk
Features of Diamond-Blackfan syndrome
Pure red cell aplasia: normal WCC and plateltes
Presents at 1y
Dysmorphology
Def: myeloproliferative disorders
A group of conditions characterised by clonal proliferation of one or more haematopoeitic component i.e. increased production of mature cells
Can be Ph+ve i.e. CML
or Ph-ve
What are Ph-ve myeloproliferative conditiosn associated with?
JAK2 mutations
especially PCV
What are the types of myeloproliferative disorders
PCV
Essential thrombocythaemia
Idiopathic myelofibrosis
Idiopathic erythrocytosis
CML
What is the difference between myeloproliferative, myelodysplasia and leukaemia
MPD: proliferation and full differentiation
MDS: ineffective proliferation and differentiation
Leukaemia: proliferation without differentiation
Polycythaemia
Riaed red cell mass
Hb
Red Cell count
PCV
Causes of polycythaemia
Primary:
PCV
Familial polycythaemia
Secondary:
Raised EPO
(disease sates, renal Ca, high altitude, chronic hypoxia)
What is pseudo polycthaemia?
Red cell mass normal but reduced plasma volume e.g. dehydration, burns, vomiting, diarrhoea, cigarette smoking
Features of PCV
Predominant presentation of increasd RBCs
Production independent of normal erthropoeisis
Often a true increase in plasma volume
Increases with age
Point mutations of JAK2 (V617F)
Point mutations of JAK2 (V617F)
PCV
Cxs of PCV
Thrombosis occurs if platelets not reduced
Leukaemia may occur
Myelofibrosis may occur
Clinical features of PCV
Incidental Dx on routine testing
Hyperviscosity/hypervolaemia/hypermetabolism: blurred vision, headaches, light-headedness, stroke, fatigue, dyspnoea
Plethroic: red nose, gout, thrombosis, retinal vein enorgement, erythromelagia
Splenomegaly
Increaseed histamein release: aquagenic pruritus (contact with water0 and peptic ulcers
Ix in PCV
Raised Hb
Hct
May be increased platelets
WCC can be normal or increased
No blast cells
Increased red cell mass and plasma volume
BM: increased ceullarity mainly affecting erythroid cells.
Low serum EPO
JAK2 V617F mutation is dxic.
How can blood volume be measured?
Isotope dilution method
Diagnostic criteria for PCV
Raised RC mass >25%
Hb >18.5g/l in men, 16.5 in women
Absence of other causes of erythrocytosis
BM cellularity
Treatment of PCV
Veensection
Hydroxycarbamide: cytoreductive therapy
Aspirin: keep platelets below 400
Features of idiopathic erythrocytosis
Absence of JAK2 V617F mutation
Isolated erythrocytosis, low EPO
Less likely to turn to myelofibrosis or AML.
Treat with venesection only
Features of esssential thrombocythaemia
Chronic MPD involving megakaryocytic lineage
Sustained plt >600
Incidence is at 55 and 30y
F>M at 55, equal at 30
Clinical presentation of essential thrombocythaemia
Incidental
Thrombosis: arterial or venous, CBA, gangrene etc.
Bleeding: mucous membranes and cutaenous
Headaches, dizziness and visual disturbances
Modest splenomegaly
Dx of essential thrombocythamia
Plt >600
Megakaryocyte abnormalities or clustering on blood film
No evidence of reactive thrombocytosis
No preceding or coincidental myeloproliferative disorder or dysplasia
Megakaryocytes in BM
Mx of essential thrombocythaemia
Aspirin: thrombosis prevention
Anagrelide: reduces fromation of plts from megakaryocytes
Hydroxycarbamide: supress other cells
Alpha IFN in patients <40
Px of essential thrombocythaemia
Normal lifespan may not be changed
Leuakaemic transofrmation in 5%
Myelofibrosis also uncommon
Def: myelofibrosis
A clonal myeloproliferative disease with proliferation mainly of megakaryocytes and granulocytic cells associated with reactive bone marrow fibrosis and extramedullary haematopoiesis
How can myelofibrosis be classified?
Primary: idiopathic
Secondary: following PRV, ET, leukaemia etc.
Clinical presentation of idiopathic myelofibrosis
Elderly
Pancytopenia related symptoms
Extramedullary haematopoeisis- hepatomegaly, massive splenomegaly, WL, fever
Can present with budd-chiari syndrome
Hypermetabolic state: weigtht loss, fatigue, dyspnoea, night sweats, hyperuricaemia.
BM dry tap
Myelofirbrosis
Tear drop poikilocytes, (dacrocyte) leukoerythroblasts
Myelofibrolsis
What are the stages of myelofirgbosis?
Prefibrotic stages: mild blood changes, hypercellular marrow.
Fibrotic stage:
Liver and spleen: splenogmealy and extramedullary haemopoiesis
Blood changes: leucoerythroblastic picture, tear drop poikilocytes, giant platelets, circulating megakaryocytes
BM: dry tap, prominent collagen fibrosis and reticulin. New bone formation and osteosclerosis later
Treatment of myelofibrosis
Anaemia: transfusion (become difficult because of splenomegaly- splenectomy)
Plt
Cytoreductive therapy: hydroxycarbamide
Thaildomide with or without prednisolone
BM transplant (experimental)
What are the bad prognostic signs in myelofibrosis?
Severe anaemia
Thrombocytopenia
Massive splenomegaly
What is the relationship between EPO/TPO and JAK2
Normally stimulate the receptor that is associated with JAK2.
Prevalence of JAK2 mutations in myeloproliferative disorders
PCV 99%
ET 50%
IM 50%
What is the MTD for bone marrow?
Maximum tolerated dose of radiation 1gy12gy
When are there cerebrovascular events following radiation?
>30gy
What are the methods for SCT?
Autologous
Allogenic
Features of autologous BM transplant
Give patient growth factors, collect SC and freeze them.
Thaw and reinfuse after high dose CTx
Indicated in acute leukaemia, lymhpoma, solid tumours, myeloma, CLL
Features of allogenic SCT
Patient is given high dose RTx and CTx and bone marrow or peripheral blood stem cells are transfused from a matched donor
Indicated in acute leukaemia, chronic leukaemia, myeloma, BM failure, congenital immune deficiencies, lymphoma
What are the complications of SCT?
Graft failure
Infections
GvHD
Relapse
Mx of GvHD
Corticosteroids
Cyclosporine
Tacroliums
Mycophenylate mofetil
Monoclonal Abs
Photophersis
Total lymphoid irradiation
What are the different phases following allogenic BMT
Aplastic phase (0-3w): Gram positive and negative bacteria, candida, sV, RSV
GvHD phase (3w-3/6m): CMV, VZV, HHV, aspergillus, candida, adenovirus
Late phase (6m-yeasr): pneuomoccoal, H influenza, VZV
CMV is the prime suspect in transplant patients.
When can the first mutation for ALL occur?
What can happen
Can occur in utero
Pre-leukaemic cells carrying this mutation can spread from one twin to another
What is TAM
Transient abnromal myelopoiesis is a specific type of neonatal leukaemia.
Myeloid leukaemia with major involvement of the megakaryocyic lineage
Remits spontaneously but relapse can occur 1-2 years later in 1/4
WCC
Neutrophil
Lymphocyte
Hb
MCV
In neonate
26.1
15
10
220
120
WCC
Neutrophil
Lymphocyte
Hb
MCV
In 2 year old
10.1
2
7
110
75
WCC
Neutrophil
Lymphocyte
Hb
MCV
In adult
4-11
2-7.5
- 3-4
- 5-16.5 and 13-18
77-95
Hb in children
No gender difference
Why may vit deficiencies manifest in childhood?
Due to rapid growth
Fe deficiency common during growth spurt
FOlica acid deficiency can also occur
What can cause polycythaemia in nneonates?
TTTS
Intrauterine hypoxia
Placental insufficiency
What can cause anaemia in neonate?
TTTS
Foetal to maternal transfusion
Parvovirus infection
Haemorrhage from the cord of placenta
Structure of HbA
a2b2: present in late foetus, infant, child and adult
HbA2
A2D2, present in the infant, child and adult
HbF
A2G2, present in foetus and infant
Normal Hb beta chain gene cluster
Sickle cell trait
Sickle cell disease
Sickle cell c
Sickle cell/beta thal
beta beta
beta betas
betas betas
betas betac
betas betathal
Why does Sickle cell disease differ between children and adult?
Different distribution of red bone marrow: susceptible to infarction
dactylitis, acute chest syndrome, painful crisis, stroke
Infant has funcitoning spleen
splenic sequestration: severe anaemia, schock and death.
Imamture immune system means they are more susceptible to pneumococcus and parvovirus
First exposure to parvovrius will lead to RCA
Infant has higher requirements for folic acid
hyperplastic erythropoeisis requires folic acid
What is splenic sequestration
Acute pooling of a large percentage of circulating red cells in the spleen
Leads to acute splenic enlargement and reduciton in Hb
Clinical effects of poorly treated thalassaemia major
Anaemia: heart failure and growth retardation
Erythropoietic driveL bone expansion, hepatomegaly, splenomegaly.
Fe overload: heart and gonadal failure
What are the types of inherited defects of coagulation?
Haemophilia A
B
Von Willebrand disease
What factor is affected in haemophilia A?
Factor VIII
What factor is affected in haemophilia B?
Factor IX
Presentation of haemophilia
Bleeding after circumcision
Haemarthrosis when starting to walk
Bruises and post-traumatic bleeding
Dx of haemophilia
Umbilical cord bleeding
Heel prick
Haematoma formation after injections
FHx
Coagulation screen
Plt count
Assay of specific coagulation factors
Mx of haemophilia
Dx
Counselling
Treatment of bleeding epsidoes
Use of prophylactic coagulation factors
Presentation of Von Willebrand
Mucosal bleeding, brusies and post-traumatic bleeding
Presentaiton of autoimmune thrombocytopenic purpurae?
Petechiae, bruises, blood blisters in mouth
Ddx: henoch schonlein, NAI, coagulation factor defected
Mx of AITP?
Observation
Corticosteroids
High dose IVIG
IV anti-RhD if Rh-positive
When is AML more common than ALL in children
In those <1y/o
Causes of gangrene
Vascular: peripheral vascular disease
Blood: PCV, cold agglutinin, essential thrombocythaemia
What blood abnormalities are associated with RA?
Anaemia of chronic disease
Fe deficiency due to aspirin or NSAID use
Neutropenia or thrombocytopenia from NSAID use
Felty’s syndrome
Increased ESR
Felty’s syndrome
RA
Splenomegaly
Neutropenia
Child with swollen single joint
Haemophilia
NAI
Osteomyelitis
Septic arthritis
Mx of TTP
PLEX
Draw the process of haemostasis

What are the constituents of the priamry platelet plug
Platelets
VW factor
Vascular endothelium
What are the functions of the endothelium?
Synthesis PGI2
VwF
Plasminogen activators
Thrbomomdoulin
Acts as the main barrier between the blood and the procoagulant subendothelium
What is VW factor?
Glycoprotein made in endothelium and platelts.
Monomers link to form a large multimeric protein
Each vWF monomer has a binding domain for platelets, collagen and factor VIII
What is the lifespan of a platelt?
10d
1/3rd stored in the spleen
Draw the coagulation cascade

Draw the process of platelet adhesion and aggregation

Draw the process of arachidonic acid metabolism

What factors are involved in fibrinolysis
Anthithrombin binds to FXa to form antibthrombin complex
Activity/binding is increased by heparin
Protein C/ Protein S
Plasmin: plasminogen activated via tPA, this breaks down fibrin clot to produce fibrin degradation productions
What acquired defects lead to haemorrhagic disorder?
Liver disease
Vit K deficiency
AI disease e.g. platelet destruction, trauma, DIC, scurvy
What inherited factors lead to haemorrhagic disorders?
Platelet abnormalities
Blood vessel wall abnormalities
Clotting factor deficiencies
Excess fibrinolysis
What differentiates between disorders of platelets and disorders of coagulation factors?
Site of bleeding: skin, mucuous membranes. Coagulation factor is in soft tissues, joints, mmuscles.
Petechiae seen in platelet disorders
Small superficial echymoses, large deep in coagulation
haemarthroses common in coagulation factor
Bleeding after cuts and scratches seen in platelet disorders
Often severe delayed bleeding after surgery in coagulation
What causes the differnece in the characteristics of platelt and coagulation factor disorders
Platelets are involved in priamry haemostasis
Coagulation factors are involved in the formation of fibrin clot
How can platelet disorders be classified?
Decreased number
Defective funciton
ITP
What are somecauses of decreased platelet number?
Decreased produciton
Decreased survival
Increased utilisation
Abnormal distribution
What are some causes of defective platelet function?
Aspirin
Thrombasthenia
What are the feautres of Glanzmann’s thrombasthenia
Rare congenital coagulopathy where platelets lack GIPIIb/IIIa
This means that fibrin crosslinking can occur
Acquired causes of coagulation factor disorders?
DIC, liver diease, Vit K deficiency, warfarin overdose
APTT in haemophilia
Prolonged
Lab features of DIC
Prolonged APTT
PT
TT
Mx of clotting disorders in liver disease
For prolonged PT/PTT: Vit K
For low fibrinogen: cryoprecipitate, fibrinogen concentrate
For DIC: (elevated d-dimer), replacement therapy
Acanthocytse (spur/spike cells)
RBCs showing many spicules
Seen in abetalipoproteinaemia, liver disease, hyposplenism
Basophilic RBC stippling
Accelerated erythropoeisis or defective Hb synthesis. Small dots seen at the periphery (rRNA)
Lead poisoning, megaloblastic anemia, myelodysplasia, liver disease, Hbopathy e.g. thalassaemia
Burr cells (ecinthocyte)
Irregulalry shaped cells
Uricaemia, GI bleeding, stomach carcinoma
Heinz Bodies
Inclusions within RBCs of denatured Hb
G6PD
Chronic liver disease
Howell-Jolly bodies
Basophilic nuclear remnants in RBCs
Post-splenectomy or hyposplenism (e.g. SCD, coeliac, congenital, UC/Crohns, myeloproliferative disease, amyloid)
Megaloblastic anaemia
Hereditary spherocytosis
Leucoerythroblastic anaemia
Marrow infiltration: nucleated RBCs and primitive WBCs in peripheral blood
Marrow infiltration i.e. myelofibrosis, malignancy
Polychromasia
Sign of reticulocytes.
Red blood cells of multiple colours due to differing amounts of Hb in RBC
Premature/inappropriate release from BM
Reticulocytes
Immature RBCs show mesh like network of ribosomal RNA which becomes visislbe with certain stains i.e. methylene blue.
Increased in HA
decreased in AA
Right shift
Hypermature white cells (hypersegmented polymorphs >5 lobes to nucleus)
Megaolblastic anaemia, uraemia, liver disease
Rouleaux formation
Red cells stacked on one another
Chronic inflammation
Paraproteinemia
MM
Stoamtocytes
Central pallor is straight or curved rod-like shape. RBCs appear as smiling faces or fish mouth
Hereditary stomatocytosis, high ETOH, liver disease
Target cells (codocyte)
Bull’s eye appearance in central pallor
Liver disease, hyposplenism, thalassaemia, IDA
Def: anaemia
Men <13.5 Women <11.5
Causes of anaemia
Reduced production
Increased loss
Increased plasma volume
Symptoms and signs of anaemia
Fatigue, dyspnoea, faintness, palpitations, headache, tinnitus, anorexia
Pallor
Hyperdynamic circulation e.g. tachycardia, flow murmurs leading to hert failure (severe anaemia- <8)
Causes of microcytic anaemia
FAST
Fe deficiency
Anaemia of chronic disease
Sideroblastic anemia
Thalassaemia (in the absence of anaemia)
Causes of normocytic anaemia
Acute blood loss
Anaemia of chronic disease
BM failure
Renal failure
Hypothyroidsim
Haemolysis
Pregnancy
Causes of macrocytic anaemia
FATRBC
Fetus (pregnancy)
Antifolates (phenytoin)
Thyroid (hypo)
Reticulocytosis
B12 or folate deficiency
Cirrhosis (ETOH excess of liver disease)
Myelodysplastic syndromes
Signs of IDA
Koilonychia
Atrophic glossitis
Angular cheilosis
Post cricoid webs (Plummer vinson syndrome)
Brittle hair and nails
Blood film in IDA
Microcytic
Hypochormic
Anisocytosis (varying size)
Poikilocytosis (varying shape)
Pencil cells
IDA=
Blood loss until proven otherwise
Causes of IDA
Blood loss
Increased utilisation
Decreased intake
Decreased absoprtion
Intravascular haemolysis
Blood loss in IDA
GI loss
Meckel’s diverticulum
Peptic ulcers, gastritis
Polyps/CRC (most common cause in adults >50)
Menorrhagia
Hookworm infestation
Increased utilisation IDA
Pregnancy
Lactation
Growth in children
Decreased intake IDA
Prematurity
Infants/children/elderly
Loss of Fe each day fetus is not in utero.
Suboptimal diet
Decreased absorption IDA
Coeliac
Post-gastric Sx
Absence in villous surphace of duodenum
Rapid transit: reduced acid which normally helps Fe absoprtion
Intravascular haemolysis IDA
MAHA
PHA
Chornic loss of Hb in urine
Treatment of IDA
Treat cause
Oral Fe
Side effects of oral Fe
Nausea
Abdo discomfort
Diarrhoea
Constipation
Black stools
Pathophysiology of anaemia of chornic disease
Inflammatory cytokines (IFNs, TNF, IL1) reduce EPOR production and thus EPO synthesis in kidneys
Fe metabolism is dysregulated: IL6 and LPS stimulate liver to make hepcidin which decreases Fe absortion from the gut through transferrin inhbition and causes Fe accumulation in macrophages
Causes of ACD
Chronic infection
Vasculitis
RA
Malignancy
Anaemia of chronic disease in renal failure
Not cytokine deficiency but due to EPO deficiency
Ferritin in ACD
High due to sequestered Fe in macrophages unless the patient has coexisting IDA
Sideroblastic anaemia causes
Ineffective erythropoeisis: Fe loading causes haemosiderosis
Causes of sideroblastic anaemia?
Myelodysplastic disorders
Following CTx
Irradiation
ETOH excess
Pb excess
Anti-TB drugs
Myeloproliferative disease
Rx of sideroblastic anaemia
Remove cause
Vitamine B6
NB with ferritin
Acute phase marker
Check CRP with every raised ferritin seen in clinical practice
Causes of macrocytosis
Megaloblastic
Non-megaloblastic
Other haematological disease
Causes of megaloblastic macrocytosis
B12 deficiency
Folate deficiency
Cytotoxic drugs
Causes of non-megaloblastic macrocytosis
ETOH (most common cause of macrocytosis without anaemia)
Reticulocytosis
Liver disease
Hypothyroidsim
Pregnancy
Other haematological disease leading to macrocytosis
Myelodysplasia
Myeloma
Myeloproliferative disorders
Aplastic anaemia
Megaloblastic blood film=
Hypersegmented polymorphs
Leucopenia
Macrocytosis
Anaemia
Thrombcoytopenia
Sources of Vit B1
Meat and dairy products (large body stores)
Causes of B12 deficiency?
Dietary
Malabsorption (stomach- pernicious anaemia, terminal ileum- resection in Crohn’s, bacterial overgrowth, tropical sprue, tapeworms
Clinical features of B12 deficiency?
Mouth: glossitis, angular cheilosis
Neuropsychiatric: irritability, depression, psychosis, dementia
Neurological: paraesthesia, peripheral neuropathy (loss of vibration anjd proprioception first, absent ankle reflex, spastic parpereisis, SACD of SC)
Tests for Pernicious anaemia
Parietal cell Abs
IF Abs
Treatment of B12 deficiency
IM hydroxycobalamin
Dietary sources of folate
Green vegetables
Nuts
Yeast
Liver
Low body stores cannot produce de novo
Causes of folate deficiency
Poor diet
Increased demand
Malabsorption
Drugs: ETOH, anti-epileptics, methotrexate, trimethoprim
Treatment of folic acid deficiency
Give oral folic acid
If cause of anaemia is not known then folic acid must not be given as it will exacerbate the neuropathy of B12 deficiency
What to remember in coagulation pathway INTRINSIC
Next factor starts iwth letter of previous factor
What test examines the intrinsic pathway
What can it monitor?
APTT
Heparin therapy
What test monitors the extrinsic pathway?
What can it be used to monitor?
PT
Warfarin therapy
What test can be used to examine the common pathway?
TT
What are some congenital and acquired vascular defects
Congenital: Osler-Weber-Rendu syndrome, Ehlyer’s danlos
Senile purpura
Infection
Steroids
Scurvy
Osler Weber Rendu
Osler-Weber-Rendu disease (OWRD) is a rare autosomal dominant disorder that affects blood vessels throughout the body (causing vascular dysplasia) and results in a tendency for bleeding. (The condition is also known as hereditary hemorrhagic telangiectasia [HHT]; the two terms are used interchangeably in this article.) The prognosis varies, depending on the severity of symptoms; generally, it is good, as long as bleeding is promptly recognized and adequately controlled.
HHT is manifested by mucocutaneous telangiectases and arteriovenous malformations (AVMs), a potential source of serious morbidity and mortality.[1]Lesions can affect the nasopharynx, central nervous system (CNS), lung, liver, and spleen, as well as the urinary tract, gastrointestinal (GI) tract, conjunctiva, trunk, arms, and fingers.
Mx of Chronic ITP
Seen in adults
Doesn’t resolve spontaenously
Requires IVIG, steroids, splenectomy
Dx of Haemophilia A
Raised APTT, Normal PT, reduced factor VIII assay
Mx of Haemophilia A
Avoid NSAIDs and IM injections
Desmopressin
Factor VIII concentrates which is life long
What is Christmas Disease?
Haemophilia B
Factor 9 deficiency
Dx of vWD
Increased APPT
Increaesd bleeding time
Reduced Factor VIII (vWF is a carrier)
Reduced vWF concentrates
Buses that go down high street ken
27, 9 and 10
Clotting factors requiring vitamin K for synthesis
INR
APTT
TT
Plt
Bleeding time
In heparin
Raised
Raised ++
Raised ++
N
N
INR
APTT
TT
Plt
Bleeding time
in DIC
Raised ++
Raised ++
Raised ++
Redcued
Increased
with raised d-dimer
INR
APTT
TT
Plt
Bleeding time
in liver disease
Raised
Raised
N/raised
N/decreased
N/ raised
Transaminases elevated
INR
APTT
TT
Plt
Bleeding time
In platelet defect
N
N
N
N
Raised
INR
APTT
TT
Plt
Bleeding time
in Vit K deficiency
Raised ++
Raised
N
N
N
INR
APTT
TT
Plt
Bleeding time
In haemophilia
N
Raised ++
N
N
N
INR
APTT
TT
Plt
Bleeding time
in vWF
N
Raised ++
N
N
Raised
The main component involved in stabilising the primary haemostatic plug.
A.
Fibrinogen
B.
Megakaryocyte
C.
Fibrin
D.
Erythrocyte
E.
Tissue plasminogen-activator (t-PA)
F.
Protein C
G.
Antithrombin III
H.
Plasmin
I.
Thromboxane A2
J.
a2 macroglobulin
K.
Cycloxygenase
L.
Platelet
M.
Endothelial cell
Fibrin
A serine protease which assists in the break down of blood clots by binding to the clot and localising agents which break it down.
TpA
A potent inhibitor of plasmin in the blood.
a2 microglobulin
A 25 year old man presents to the Emergency Department a day after attending his dentist for a routine check-up. After treatment at the dentists the previous day, his gums had not stopped bleeding. On investigation, his APTT and bleeding time are prolonged but a normal PT.
A.
Autoimmune thrombocytopenic purpura
B.
Factor VIII deficiency
C.
Christmas disease
D.
Megakaryocyte
E.
Factor XII deficiency
F.
Thromboxane A2
G.
von Willebrand deficiency
H.
Sensitised platelet
I.
Haemophilia
J.
Marfan syndrome
K.
Vitamin K deficiency
L.
Ehlers-Danlos syndrome
M.
Prostacyclin PGI2
vWD
A 16 year old girl presents to the Haematology Outpatients clinic describing a fluctuating history of easy bruising, epistaxis and menorrhagia. On investigation there is a thrombocytopaenia with increased megakaryocytes on BM examination
A.
Autoimmune thrombocytopenic purpura
B.
Factor VIII deficiency
C.
Christmas disease
D.
Megakaryocyte
E.
Factor XII deficiency
F.
Thromboxane A2
G.
von Willebrand deficiency
H.
Sensitised platelet
I.
Haemophilia
J.
Marfan syndrome
K.
Vitamin K deficiency
L.
Ehlers-Danlos syndrome
M.
Prostacyclin PGI2
Response Feedback:
F
AITP
Which protein, important in haemostasis, is vitamin K dependent but is not a serine protease?
Protein S
Which key clotting factor activates both factors V and VIII, and also activates protein C?
Thrombin
Which option is required as a cofactor for protein C activity?
Protein S
A 37 year old mother of 4 children, presents to her GP because of recurrent nose bleeds and feeling tired all the time and heavy periods.
A.
Sickle cell anaemia
B.
Factor V Leiden
C.
Christmas Disease
D.
Warfarin overdose
E.
Henoch – Schönlein Purpura
F.
Bile acid malabsorption
G.
Antiphospholipid antibody syndrome
H.
Malignancy
I.
Disseminated intravascular coagulation
J.
Vitamin K Deficiency
K.
Osler-Weber-Rendu Syndrome
L.
Haemophilia A
M.
Von Willebrand’s Disease
N.
B-Thalassaemia
Osler Wever Rendu
1) A rare autosomal dominant disorder. Alternative name = hereditary haemorrhagic telangiectasia. There is a structural abnormality of the blood vessels, resulting in telangiectases, which are thin walled so are likely to bleed. This leads to haemorrhage and anaemia. It is more common in females, and may not present until later in life. Epistaxis is the commonest presenting symptom. This patient is feeling tired, not just because of her 4 children, but because she also has iron deficiency anaemia.
22 year old Saharawi refugee presents with anaemia, weight loss, loose stools and blood tests reveal an increased PT and slightly increased APTT, with normal thrombin time and platelet count.
A.
Sickle cell anaemia
B.
Factor V Leiden
C.
Christmas Disease
D.
Warfarin overdose
E.
Henoch – Schönlein Purpura
F.
Bile acid malabsorption
G.
Antiphospholipid antibody syndrome
H.
Malignancy
I.
Disseminated intravascular coagulation
J.
Vitamin K Deficiency
K.
Osler-Weber-Rendu Syndrome
L.
Haemophilia A
M.
Von Willebrand’s Disease
N.
B-Thalassaemia
Vit K deficiency
revalence of coeliac disease is highest in Saharawi refugees. This patient has coeliac disease, and as a result of malabsorption is losing weight and has loose stools (steatorrhoea), and vitamin K deficiency. The blood results related to vitamin K deficiency.
A 5 year old boy has the following blood results: normal PT, increased APTT, normal platelet count, decreased VIII:C and decreased vWF.
A.
Sickle cell anaemia
B.
Factor V Leiden
C.
Christmas Disease
D.
Warfarin overdose
E.
Henoch – Schönlein Purpura
F.
Bile acid malabsorption
G.
Antiphospholipid antibody syndrome
H.
Malignancy
I.
Disseminated intravascular coagulation
J.
Vitamin K Deficiency
K.
Osler-Weber-Rendu Syndrome
L.
Haemophilia A
M.
Von Willebrand’s Disease
N.
B-Thalassaemia
The most common hereditary bleeding disorder, affect 1% of the population. vWF is a carrier protein for factor VIII and stabilises it. Mutation is in chromosome 12.
Dangerous combination with no added efficacy and increased GI bleed.
A.
Dalteparin (LMWH)
B.
Aspirin
C.
10mg, 10mg, 5mg, measure on 4th day then every 2 days
D.
APTT
E.
Calciparone
F.
Pentapolysaccharide
G.
Clopidogrel
H.
Warfarin
I.
Prothrombin time (PT)
J.
Clopidogrel and aspirin
K.
5mg, 5mg, 5mg, 5mg, measure on 5th day, 8th day and then every 4 days
L.
Thrombin time (TT)
M.
LMWH and aspirin
N.
Dipyridamole modified release (MR) and aspirin
O.
Unfractionated heparin (UFH)
P.
Streptokinase
Clopidogrel and aspirin
Old model of starting warfarin
A.
Dalteparin (LMWH)
B.
Aspirin
C.
10mg, 10mg, 5mg, measure on 4th day then every 2 days
D.
APTT
E.
Calciparone
F.
Pentapolysaccharide
G.
Clopidogrel
H.
Warfarin
I.
Prothrombin time (PT)
J.
Clopidogrel and aspirin
K.
5mg, 5mg, 5mg, 5mg, measure on 5th day, 8th day and then every 4 days
L.
Thrombin time (TT)
M.
LMWH and aspirin
N.
Dipyridamole modified release (MR) and aspirin
O.
Unfractionated heparin (UFH)
P.
Streptokinase
10mg, 10mg, 5mg, measure on 4th day then every 2 days
Tait model of starting warfarin
5mg, 5mg, 5mg, 5mg, measure on 5th day, 8th day and then every 4 days
Side effects include cutaneous necrosis
A.
Dalteparin (LMWH)
B.
Aspirin
C.
10mg, 10mg, 5mg, measure on 4th day then every 2 days
D.
APTT
E.
Calciparone
F.
Pentapolysaccharide
G.
Clopidogrel
H.
Warfarin
I.
Prothrombin time (PT)
J.
Clopidogrel and aspirin
K.
5mg, 5mg, 5mg, 5mg, measure on 5th day, 8th day and then every 4 days
L.
Thrombin time (TT)
M.
LMWH and aspirin
N.
Dipyridamole modified release (MR) and aspirin
O.
Unfractionated heparin (UFH)
P.
Streptokinase
Warfarin
The drug most likely to cause thrombocytopaenia with paradoxical thrombosis
A.
Dalteparin (LMWH)
B.
Aspirin
C.
10mg, 10mg, 5mg, measure on 4th day then every 2 days
D.
APTT
E.
Calciparone
F.
Pentapolysaccharide
G.
Clopidogrel
H.
Warfarin
I.
Prothrombin time (PT)
J.
Clopidogrel and aspirin
K.
5mg, 5mg, 5mg, 5mg, measure on 5th day, 8th day and then every 4 days
L.
Thrombin time (TT)
M.
LMWH and aspirin
N.
Dipyridamole modified release (MR) and aspirin
O.
Unfractionated heparin (UFH)
P.
Streptokinase
UFH
Indicated as thrombotic prophylaxis in DIC
A.
Dalteparin (LMWH)
B.
Aspirin
C.
10mg, 10mg, 5mg, measure on 4th day then every 2 days
D.
APTT
E.
Calciparone
F.
Pentapolysaccharide
G.
Clopidogrel
H.
Warfarin
I.
Prothrombin time (PT)
J.
Clopidogrel and aspirin
K.
5mg, 5mg, 5mg, 5mg, measure on 5th day, 8th day and then every 4 days
L.
Thrombin time (TT)
M.
LMWH and aspirin
N.
Dipyridamole modified release (MR) and aspirin
O.
Unfractionated heparin (UFH)
P.
Streptokinase
Dalteparin (LMWH)
A 65 year old patient presents with hepatosplenomegaly. He is mildly anaemic and thrombocytompenic. A blood monocyte count of 1.2 x 109/l is observed. Bone marrow aspirate reveals ring sideroblasts at 15% of total blasts. Auer rods are observed.
A.
Refractory Anaemia with Ring Sideroblasts
B.
Acute Myeloid Leukaemia
C.
Chronic Myelomonocytic Anaemia
D.
Refractory Anaemia with excess of Blasts II
E.
Myelodysplastic syndrome,unclassifiable
F.
Refractory Cytopaenia with Multilineage Dysplasia
G.
Refractory anaemia
H.
Aplastic Anaemia
I.
Secondary Sideroblastic Anaemia
J.
Refractory Anaemia with excess of Blasts I
K.
Myelodysplastic syndrome associated with isolated del(5q) chromosome abnormality (5q syndrome)
CML
A 58 year old lady complains of lethargy and “easy bruising”. She presents with purpura. Her FBC reveals Hb 10.5g/dl; WBCs 2.3x109/l and platelets 8x109/l. Blood film reveals <1% Blasts, and marrow aspirate shows 20% dysplasia in erythroid lineage, 60% dysplasia in platelet lineage, 5% dysplasia in granulocyte lineage, and less than 5% blasts.
A.
Refractory Anaemia with Ring Sideroblasts
B.
Acute Myeloid Leukaemia
C.
Chronic Myelomonocytic Anaemia
D.
Refractory Anaemia with excess of Blasts II
E.
Myelodysplastic syndrome,unclassifiable
F.
Refractory Cytopaenia with Multilineage Dysplasia
G.
Refractory anaemia
H.
Aplastic Anaemia
I.
Secondary Sideroblastic Anaemia
J.
Refractory Anaemia with excess of Blasts I
K.
Myelodysplastic syndrome associated with isolated del(5q) chromosome abnormality (5q syndrome)
Re Q3, to count as significant, dysplasia must involve at least 10% of cells in a lineage. To count as RCMD, at least 2 MYELOID lineages must be dysplastic, and there must be bi or pancytopenia in the peripheral blood. (This can include anaemia!)
A 78 year old male patient with recurring infections of the face and maxillary sinuses associated with neutropenia. His bloods are: Hb 9.8 g/dl; WBC 1.3x109/l; Neutrophils 0.3x109/l; platelets 38x109/l.The lab informs you that there are Blasts approximately compromise 17% of bone marrow aspirate
A.
Refractory Anaemia with Ring Sideroblasts
B.
Acute Myeloid Leukaemia
C.
Chronic Myelomonocytic Anaemia
D.
Refractory Anaemia with excess of Blasts II
E.
Myelodysplastic syndrome,unclassifiable
F.
Refractory Cytopaenia with Multilineage Dysplasia
G.
Refractory anaemia
H.
Aplastic Anaemia
I.
Secondary Sideroblastic Anaemia
J.
Refractory Anaemia with excess of Blasts I
K.
Myelodysplastic syndrome associated with isolated del(5q) chromosome abnormality (5q syndrome)
Refractory Anaemia with excess of Blasts II
A 74 year old woman with high-normal platelet count. Bone marrow aspirate shows hyperplasia of hypolobulated micromegakaryocytes. Responds well to lenalidomide.
A.
Secondary aplastic anaemia
B.
5q syndrome
C.
Idiopathic aplastic anaemia
D.
Acute myeloid leukaemia
E.
Inherited aplastic anaemia
F.
Myelofibrosis
G.
Refractory cytopenia with multilineage dysplasia
H.
Juvenile myelomonocytic leukaemia
I.
Refractory anaemia with an excess of blasts
J.
Refractory anaemia
5q syndrome
In this case haemoglobin is normal but there is a reduction in platelets and neutrophils
A.
Secondary aplastic anaemia
B.
5q syndrome
C.
Idiopathic aplastic anaemia
D.
Acute myeloid leukaemia
E.
Inherited aplastic anaemia
F.
Myelofibrosis
G.
Refractory cytopenia with multilineage dysplasia
H.
Juvenile myelomonocytic leukaemia
I.
Refractory anaemia with an excess of blasts
J.
Refractory anaemia
Refractory cytopenia with multilineage dysplasia
A consultant grills you on a ward round: there is a patient with a WBC of 140 x109/L, Hb 12 g/dL, Platelet count 320 x109/L. She complains of tiredness, night sweats, fever and abdominal pain. Her spleen is markedly enlarged. Blood film shows blasts, neutrophils, basophils. How would you treat her?
A.
Pseudopolycythaemia
B.
Splenomegaly
C.
Haematocrit
D.
Hydroxycarbamide
E.
Idiopathic myelofibrosis
F.
Erythropoeitin
G.
Venesection
H.
Chlorambucil
I.
Acute myeloid leukaemia
J.
Chronic myeloid leukaemia
K.
Polycythaemia vera
L.
Imitanib
M.
Essential thrombocythaemia
N.
Melphalan
O.
Tear drop poikilocytes
P.
Microcytosis
Imatinib
You are asked to see a 76 year old man on the wards, who presented with fatigue, dyspnoea, bleeding gums and nightsweats. His abdomen is massively enlarged. You read his notes and find ‘bone marrow aspirate: ‘dry tap’. What would you expect to see on the blood film?
A.
Pseudopolycythaemia
B.
Splenomegaly
C.
Haematocrit
D.
Hydroxycarbamide
E.
Idiopathic myelofibrosis
F.
Erythropoeitin
G.
Venesection
H.
Chlorambucil
I.
Acute myeloid leukaemia
J.
Chronic myeloid leukaemia
K.
Polycythaemia vera
L.
Imitanib
M.
Essential thrombocythaemia
N.
Melphalan
O.
Tear drop poikilocytes
P.
Microcytosis
Tear drop poikilocytes
A 55 year old female has a past medical history of deep vein thrombosis. She also complains of easy bruising. Her platelet count is 770 x109/L, CRP is 4mg/L. You prescribe aspirin.
A.
Pseudopolycythaemia
B.
Splenomegaly
C.
Haematocrit
D.
Hydroxycarbamide
E.
Idiopathic myelofibrosis
F.
Erythropoeitin
G.
Venesection
H.
Chlorambucil
I.
Acute myeloid leukaemia
J.
Chronic myeloid leukaemia
K.
Polycythaemia vera
L.
Imitanib
M.
Essential thrombocythaemia
N.
Melphalan
O.
Tear drop poikilocytes
P.
Microcytosis
Essential thrombocythaemia
A routine medical of 33-year-old footballer reveals: Hb = 9.9g/dl and WCC = 130 x 109/L. His blood film shows whole spectrum of myeloid precursors, including a few blast cells. He admits to having frequent night sweats and blurred vision. There is a presence of Ph chromosome t(9;22) on cytogenetic analysis.
A.
Lung fibrosis
B.
Hairy cell leukaemia
C.
Hypothyroidism
D.
Septicaemia
E.
Acute promyelocytic leukaemia
F.
Chronic myeloid leukaemia
G.
Acute myeloid leukaemia
H.
Chronic lymphocytic leukaemia
I.
Bronchial carcinoma
J.
DIC
K.
Vincristine poisoning
L.
Tumour-lysis syndrome
M.
Richter’s syndrome
N.
Acute lymphoblastic leukaemia
CML
A 5-year-old girl presents with failure to thrive, recurrent fever and bruising. Immunotyping reveals the presence of CD10..
A.
Lung fibrosis
B.
Hairy cell leukaemia
C.
Hypothyroidism
D.
Septicaemia
E.
Acute promyelocytic leukaemia
F.
Chronic myeloid leukaemia
G.
Acute myeloid leukaemia
H.
Chronic lymphocytic leukaemia
I.
Bronchial carcinoma
J.
DIC
K.
Vincristine poisoning
L.
Tumour-lysis syndrome
M.
Richter’s syndrome
N.
Acute lymphoblastic leukaemia
ALL
The commonest adult leukaemia.
CLL
50yr old man presents to his GP complaining of weight loss, tiredness, easy bruising and a painful big toe. On examination his spleen is massively enlarged. Investigation shows a raised serum urate. The peripheral blood film is abnormal, showing proliferation of which type of cell?
A.
Neutrophils
B.
Chromosome 9;22 translocation
C.
Spherocytes
D.
Pelger-Huet cells
E.
Blast cells
F.
Auer rods
G.
Eosinophils
H.
Reticulocytes
I.
Platelets
J.
Chromosome 11q23 deletion
K.
Clonal B lymphocytes
Neutrophils
CML. Increased mass of turning-over cells generates urate
A 70yr old man complains of a year’s history of fatigue, weight loss and recurrent sinusitis. His white cell count is raised with a lymphocytosis of 283x109 /L. Blood film shows features of haemolysis and Coomb’s test is positive. Further investigation show the bone marrow, blood and lymph nodes are infiltrated with which cell population?
A.
Neutrophils
B.
Chromosome 9;22 translocation
C.
Spherocytes
D.
Pelger-Huet cells
E.
Blast cells
F.
Auer rods
G.
Eosinophils
H.
Reticulocytes
I.
Platelets
J.
Chromosome 11q23 deletion
K.
Clonal B lymphocytes
Clonal B lymphocytes
CLL. Only two chronic B cell leukaemia/lymphomas are CD5+: CLL (CD5+ CD23+) and Mantle Cell Lymphoma (CD5+ CD23-). CLL may be assoc. with Coombs positive AIHA and ITP. The combination is called Evans syndrome.
What is a poor prognositc sign in CLL
del 11q23
What differntiates between CML and myelodproliferative disorders and infections
Neutrophil ALP is low in CML
Raised in myeloproliferative disorders and infections
What is the blast threshold in the BM for AML
20%
characterized by less than 5% primitive blood cells (myeloblasts) in the bone marrow and pathological abnormalities primarily seen in red cell precursors
Refractory anemia (RA)
characterized by less than 5% myeloblasts in the bone marrow, but distinguished by the presence of 15% or greater red cell precursors in the marrow being abnormal iron-stuffed cells called ‘ringed sideroblasts’
Refractory anemia with ringed sideroblasts (RARS)
characterized by 5-19% myeloblasts in the marrow
Refractory anemia with excess blasts (RAEB)
haracterized by 20-29% myeloblasts in the marrow (30% blasts is defined as acute myeloid leukemia in FAB classification but 20% in the WHO classification.. …therefore a controversial category and the WHO have abandoned teh RAEB-T category!)
Refractory anemia with excess blasts in transformation (RAEB-T)
characterized by less than 20% myeloblasts in the bone marrow and greater than 1000 * 109/uL monocytes circulating in the peripheral blood. Also something that often comes up in exams: - syndrome, typically seen in older women with normal or high platelet counts and isolated deletions of the long arm of chromosome 5 in bone marrow cells.
Chronic myelomonocytic leukemia (CMML) - not to be confused with chronic myelogenous leukemia or CML
Female Age at diagnosis: 74 years Transfusion-dependent anemia Normal or increased platelet counts along with bone marrow hyperplasia of hypolobulated micromegakaryocytes
q syndrome, there is a low incidence of thrombocytopenia. These patients may actually have thrombocytosis These patietnts have a low incidence of neutropenia, infection, and bleeding and low incidence of transformation into acute leukemi
Treatment of 5q sunydrome
Lenalidomide
A 44 year old with recurrent URTI and haematuria in last 6 months presents to GP. He also has a number of mouth ulcers and blood film demonstrates pancytopenia. What treatment would be appropriate? Options Androgen Anti-thymocyte globulin BMT Blood transfusion Corticosteroids Oral Iron Vitamin B12 ANS:Anti-thymocyte globulin I understand this is AA but I’m not quite sure when you would use the different treatment options e.g. corticosteroids, BMT, androgens….
This is covered very well in the lecture you have been given, but essentially - when supportive measures fail, Immune suppression is especially useful if a matched sibling donor for BMT is not available or if the patient is older than 60 years. Bone MArrow transplantation -HLA-matched sibling-donor BMT is the treatment of choice for a young patient with SAA (controversial but generally accepted for age <60 y). There are no hard and fast rules, and remember that that the cause of aplastic anaemia needs to be elucidated, and treatment may be directed specifically towards the underlying cause.
An 83 year old woman presents to the A+E Departments with severe weakness and shortness of breath on minimal exertion. On examination, masses are felt in both left and right upper quadrants of the abdomen.
Myelofibrosis
If thrombin time is up
there is a fibrinogen problem.
If APTT or PT is up
there is a coagulation factor dysfunction or deficiency.
If bleeding time is up
there is a platelet dysfunction or deficiency.
To diagnose DIC you need
need low platelets, low fibrinogen, raised APTT and PT, raised D-dimers, schistocytes on blood smear, and a compatible clinical setting.
“A 37 year old mother of 4 children, presents to her GP because of recurrent nose bleeds and feeling tired all the time and heavy periods.” Why is this osler weber rendu syndrome and not von willebrand disease?
The key to the question is “mother of 4 children” - vWD would almost certainly have been picked up due to prolonged bleeding during one of these pregnancies/deliveries. OWR is diagnosed by the triad of epistaxis, telangiectasia and a suitable family history. So whilst telangiectasia are not directly mentioned in the question, nosebleeds would suggest OWR as a possibility. As bleeding in OWR is from vascular malformations (caused by mutations in the TGF-B pathway) and not a direct coagulation defect, it would be less likely to be picked up on routine screening in pregnancy. This makes it a better fit in this question than vWD. The only documented associations between OWR and heavy menstrual bleeding are a few case reports suggesting uterine arterio-venous malformations. However this is a very common symptom in the normal population, and many OWR patients will have heavy periods with no relevance to their underlying disease process. The question could be more direct in pointing to OWR, but there is a widely varying phenotype and this is a very possible presentation. In real life you would perform a coagulation screen, take a good family history and you would have the diagnosis.
Why is Warfarin always started under Heparin cover
Warfarin alone initially increases the clotting risk because proteins C and S (the anticoagulant proteins) have shorter half lives and disappear from the blood faster than factors II, VII, IX, X (the procoagulant proteins).
How can Heparin induced thrombcotyopaenia be classified
Types 1 and 2
Type 1 HIT
Dose related effect mediated by platelet aggregation
Type 2 HIT
Unpredictable immune response with antibodies directed against the heparin-platelet factor 4 complex
Large aggregates cause thrombosis
Treatment of HIT T2
Stop heparin and start a direct thrombin inhibiotr e.g. hirudin
Which treatment does HIT more commonly following
UFH
What is the exception to usual rule that Warfarin is more effective than LMWH?
Cancer
Gaucher’s disease
a hereditary disease in which the metabolism and storage of fats is abnormal. It results in bone fragility, neurological disturbance, anaemia, and enlargement of the liver and spleen.
Spur cell hemolytic anemia
Spur cell hemolytic anemia, is a form of hemolytic anemia that results secondary to severe impaired liver function or cirrhosis. Chronic liver disease impairs the liver’s ability to esterify cholesterol, causing free cholesterol to bind to the red cell membrane, increasing its surface area. This condition also creates rough or thorny projections on the erythrocyte named acanthocytes. [
A 10 year old boy presenting with tan-to-grey hyperpigmented patches on his upper trunk, neck and face, nail ridges and leukoplakia.
A.
Dyskeratosis congenita
B.
Hepatitis C infection
C.
Parvovirus B19 infection
D.
Aplastic anaemia
E.
Fanconi anaemia
F.
Myelofibrosis
G.
Drug-induced
H.
Radiation-induced
I.
Acute myeloid leukaemia
J.
Systemic lupus erythematosus
Dyskeratosis congenita is characterised by a triad of Nail dystrophy, leukoplakia and cutaneous manifestations.
A 76 year old man presents to his GP with increasing tiredness, weakness and a long-standing cold. The blood results ordered by the GP showed that the gentleman was anaemic and that increased blast cells were present.
A.
Dyskeratosis congenita
B.
Hepatitis C infection
C.
Parvovirus B19 infection
D.
Aplastic anaemia
E.
Fanconi anaemia
F.
Myelofibrosis
G.
Drug-induced
H.
Radiation-induced
I.
Acute myeloid leukaemia
J.
Systemic lupus erythematosus
AML
An 83 year old woman presents to the A&E Departments with severe weakness and shortness of breath on minimal exertion. On examination, masses are felt in both left and right upper quadrants of the abdomen. Blood film show leukoerythroblastic cells and teardrop poikilocytes.
A.
Dyskeratosis congenita
B.
Hepatitis C infection
C.
Parvovirus B19 infection
D.
Aplastic anaemia
E.
Fanconi anaemia
F.
Myelofibrosis
G.
Drug-induced
H.
Radiation-induced
I.
Acute myeloid leukaemia
J.
Systemic lupus erythematosus
Myelofibrosis
A 19 year old Jewish male presenting with multiple pathological fractures and hypersplenism.
A.
Paroxysmal nocturnal haemoglobinuria
B.
Sepsis
C.
Autoimmune haemolytic anaemia
D.
Pyruvate kinase deficiency
E.
Hereditary spherocytosis
F.
Sickle-cell disease
G.
Cardiac haemolysis
H.
Spur cell anaemia
I.
Drug-induced immune haemolysis
J.
Gaucher’s disease (glucosylceramide lipidosis)
K.
Hereditary elliptocytosis
L.
Haemolytic uraemic syndrome
Gaucher’s
A 26 year old primary school teacher presents with chronic anaemia. She has an increased (unconguated) bilirubin, and has had well controlled systemic lupus erythematosus for 7 years.
A.
Paroxysmal nocturnal haemoglobinuria
B.
Sepsis
C.
Autoimmune haemolytic anaemia
D.
Pyruvate kinase deficiency
E.
Hereditary spherocytosis
F.
Sickle-cell disease
G.
Cardiac haemolysis
H.
Spur cell anaemia
I.
Drug-induced immune haemolysis
J.
Gaucher’s disease (glucosylceramide lipidosis)
K.
Hereditary elliptocytosis
L.
Haemolytic uraemic syndrome
AIHA
A 35 year old women complains of abdominal pain. There is associated pancytopenia, and a Ham’s test is positive.
A.
Paroxysmal nocturnal haemoglobinuria
B.
Sepsis
C.
Autoimmune haemolytic anaemia
D.
Pyruvate kinase deficiency
E.
Hereditary spherocytosis
F.
Sickle-cell disease
G.
Cardiac haemolysis
H.
Spur cell anaemia
I.
Drug-induced immune haemolysis
J.
Gaucher’s disease (glucosylceramide lipidosis)
K.
Hereditary elliptocytosis
L.
Haemolytic uraemic syndrome
PNH
A woman aged 69 with no past medical history except osteoarthritis suffered acute haemolysis after her right hip was replaced. There was no evidence of splenomegaly or lymphadenopathy and both warm and cold antibody tests were negative. When she had the left hip replaced 2 years later she again developed haemolysis soon after the anaesthetic. She was tested for IgG and IgE antibodies to the anaesthetic. Seven months later she had a revision arthroplasty and haemolysed again. Which condition might she have?
A.
Sickle cell anaemia
B.
Paroxysmal cold haemoglobinuria
C.
Primary autoimmune haemolytic anaemia
D.
Paroxysmal nocturnal haemoglobinuria
E.
Cephalosporin-induced haemolytic anaemia
F.
Hereditary elliptocytosis
G.
G6PD deficiency
H.
Autoimmune haemolytic anaemia due to infectious mononucleosis
I.
Hereditary spherocytosis
J.
Disseminated intravascular coagulation
K.
Sepsis
Cephalosporin-induced haemolytic anaemia
In which condition might the sucrose and Ham acid haemolysis tests be positive?
PNH
Mr RX came to Fulham from Thailand last year. He has inflammatory bowel disease and is taking dapsone for his dermatitis herpetiformis. Which of the above conditions would be likely and clinically relevant?
A.
Sickle cell anaemia
B.
Paroxysmal cold haemoglobinuria
C.
Primary autoimmune haemolytic anaemia
D.
Paroxysmal nocturnal haemoglobinuria
E.
Cephalosporin-induced haemolytic anaemia
F.
Hereditary elliptocytosis
G.
G6PD deficiency
H.
Autoimmune haemolytic anaemia due to infectious mononucleosis
I.
Hereditary spherocytosis
J.
Disseminated intravascular coagulation
K.
Sepsis
Dapsone is used to treat dermatitis herpetiformis. Dapsone is known to cause haemolysis in G6PD deficient patients, so it is avoided. G6PD deficiency in commoner in Thai people.
A 29 year old man noticed he had yellow eyes and dark urine. He was always tired, and could not take part in sports as he easily became short of breath. There was no itching, fever or bleeding, and he was not taking any drugs. On examination he was anaemic, jaundiced, afebrile and had no palpable lymphadenopathy, hepatosplenomegaly or rash. His blood tests showed Hb 5.4g/Dl and raised WCC (40 x 109/L), bilirubin (47 µmol/l), aspartate transaminase (90iu/L) and lactate dehydrogenase (5721iu/l). The blood film showed polychromic nucleated red cells and spherocytes and the reticulocyte count was 9%. Direct Coombs’ test revealed IgG and C3 on the red cell surfaces. The serum contained a warm non-specific autoantibody (i.e. it reacted with all the red cells in the test panel). Antinuclear antibodies and rheumatoid factor tests were negative and immunoglobulin levels were normal; there were no paraprotein bands in his serum. He failed to respond to high-dose corticosteroids and had a splenectomy three weeks later.
A.
Sickle cell anaemia
B.
Paroxysmal cold haemoglobinuria
C.
Primary autoimmune haemolytic anaemia
D.
Paroxysmal nocturnal haemoglobinuria
E.
Cephalosporin-induced haemolytic anaemia
F.
Hereditary elliptocytosis
G.
G6PD deficiency
H.
Autoimmune haemolytic anaemia due to infectious mononucleosis
I.
Hereditary spherocytosis
J.
Disseminated intravascular coagulation
K.
Sepsis
Primary AIHA
In which condition might a Donath-Landsteiner be positive?
Paroxysmal cold haemoglobinuria
A 28 year old female presents with fever < 40 C and rigors approx. 1 ½ hours after transfusion. She has two children and previously had a blood transfusion 7 years ago.
Febrile non haemolytic transfusion reaction
Febrile non-haemolytic transfusion reaction (FNHTR) is an immediate reaction, causing fever and rigors. In contrast, delayed haemolytic transfusion reaction (DHTR) manifests days to weeks after a transfusion, acommpanied by a falling haemoglobin and jaundice or haemoglobinuria. Bacterial contamination can present in a similar manner to FNHTR but is differentiated by a much more marked fever; in addition, profound hypotension and tachycardia may occur.
A 44 year old male develops a pyrexia of >40 C and marked hypotension very shortly after receiving a blood transfusion. He has never had a transfusion before and there is no evidence of ABO blood group / rhesus incompatibility.
A.
Anaphylactic reaction
B.
Fluid overload
C.
TRALI
D.
Graft versus host disease
E.
Bacterial contamination
F.
Delayed haemolytic transfusion reaction.
G.
Viral contamination
H.
Allergic reaction
I.
Febrile non haemolytic transfusion reaction
J.
Immediate haemolytic transfusion reaction
K.
Iron overload
Bacterial contamination
n 18 year old boy with sickle cell anaemia is observed to have short stature. Further tests reveal poor cardiac function
A.
Anaphylactic reaction
B.
Fluid overload
C.
TRALI
D.
Graft versus host disease
E.
Bacterial contamination
F.
Delayed haemolytic transfusion reaction.
G.
Viral contamination
H.
Allergic reaction
I.
Febrile non haemolytic transfusion reaction
J.
Immediate haemolytic transfusion reaction
K.
Iron overload
Fe overload
An 18 year old African girl known to suffer from sickle cell anaemia develops a fever, sudden lethargy, pallor and arthralgia two months post-transfusion. Investigations reveal bone marrow red cell aplasia and a positive Paul-Bunnell test.
A.
CMV infection
B.
Post-transfusion purpura (PTP)
C.
Immunological haemolytic reaction
D.
Non-haemolytic reaction
E.
Delayed haemolytic transfusion reaction (DHTR)
F.
Transfusion-related acute lung injury (TRALI)
G.
Allergic reaction to transfusion
H.
Graft vs. Host disease (GvHD)
I.
Iron overload
J.
Reaction to massive transfusion
K.
Air embolism
L.
Transfusion-related fluid overload
M.
B19 parvovirus infection
B19 parvovirus infection
A 32 year old Irish man was noted to have a temperature of 36.9ºC and blood electrolyte results of: urea = 5.2 mmol/L, sodium = 144 mmol/L, potassium = 5.5 mmol/L, calcium = 2.5 mmol/L after receiving 10 units of blood over a 24 hour period.
A.
CMV infection
B.
Post-transfusion purpura (PTP)
C.
Immunological haemolytic reaction
D.
Non-haemolytic reaction
E.
Delayed haemolytic transfusion reaction (DHTR)
F.
Transfusion-related acute lung injury (TRALI)
G.
Allergic reaction to transfusion
H.
Graft vs. Host disease (GvHD)
I.
Iron overload
J.
Reaction to massive transfusion
K.
Air embolism
L.
Transfusion-related fluid overload
M.
B19 parvovirus infectio
Reaction to massive transfusion
A 55 year old British female developed an itchy, diffuse erythematous rash on both arms fifteen minutes after receiving a blood transfusion. This rash responded well to acrivastine.
A.
CMV infection
B.
Post-transfusion purpura (PTP)
C.
Immunological haemolytic reaction
D.
Non-haemolytic reaction
E.
Delayed haemolytic transfusion reaction (DHTR)
F.
Transfusion-related acute lung injury (TRALI)
G.
Allergic reaction to transfusion
H.
Graft vs. Host disease (GvHD)
I.
Iron overload
J.
Reaction to massive transfusion
K.
Air embolism
L.
Transfusion-related fluid overload
M.
B19 parvovirus infection
Allergic reaction to transfusion
Patient develops shortness of breath, dry cough and chills. Donors blood was found to contain anti-leucocyte antibodies with similar specificity to the patient’s white blood cell antigens.
A.
Iron overload
B.
TA-GVHD – Transfusion associated graft versus host disease
C.
Bacterial infection
D.
ABO incompatible
E.
DHTR – Delayed Haemolytic transfusion reaction
F.
IgA deficiency
G.
FNHTR – Febrile non-haemolytic transfusion reaction
H.
TRALI – Transfusion related acute lung injury
I.
Urticarial rash
TRALI
Patient has a severe anaphylactic reaction soon after transfusion. Signs and symptoms include wheeze, raised pulse, low blood pressure and laryngeal oedema.
A.
Iron overload
B.
TA-GVHD – Transfusion associated graft versus host disease
C.
Bacterial infection
D.
ABO incompatible
E.
DHTR – Delayed Haemolytic transfusion reaction
F.
IgA deficiency
G.
FNHTR – Febrile non-haemolytic transfusion reaction
H.
TRALI – Transfusion related acute lung injury
I.
Urticarial rash
IgA deficiency
A 40 year old male patient with known Sickle-Cell anaemia develops mild symptoms of fever and rigors 3 to 4 days after a transfusion.
A.
Transfursion related acute lung injury
B.
CMV infection
C.
Anaphylaxis due to IgA deficiency
D.
Delayed transfusion reaction
E.
Febrile non-haemolytic transfusion reaction
F.
Post-transfusion purpura
G.
Air embolism
H.
Iron overload
I.
ABO incompatible
J.
Graft vs host disease
K.
Urticarial rash
L.
Bacterial infection
Febrile non-haemolytic transfusion reaction
A 24 year old male who was diagnosed with thalassaemia major at 13 months presents to outpatients clinic complaining of malaise and erectile dysfunction.
A.
Delayed haemolytic transfusion reaction (DHTR)
B.
Kleihauer test
C.
Viral contamination of transfusion
D.
Pulmonary embolism
E.
Guthrie test
F.
Bacterial contamination of transfusion
G.
Immediate haemolytic transfusion reaction
H.
Transfusion haemosiderosis
I.
Transfusion-related acute lung injury (TRALI)
J.
Allergic reaction to forein protein in donor blood
Transfusion haemosiderosis
A 25 year old man vomits and becomes restless on receiving a blood transfusion, he also complains of chest and abdominal pain.
A.
TRALI
B.
Post-transfusion purpura
C.
Delayed haemolytic transfusion reaction
D.
Fungal infection
E.
Pulmonary Embolism
F.
Iatrogenic Iron overload
G.
Allergic reaction
H.
Bacterial infection
I.
Viral infection
J.
Immediate haemolytic transfusion reaction
K.
Transfusion-associated graft versus host disease
L.
Massive transfusion reaction
M.
Air Embolism
Immediate haemolytic transfusion reaction
A 60 year old man who has been given a blood transfusion has noticed an itchy rash on his arms and legs.
A.
TRALI
B.
Post-transfusion purpura
C.
Delayed haemolytic transfusion reaction
D.
Fungal infection
E.
Pulmonary Embolism
F.
Iatrogenic Iron overload
G.
Allergic reaction
H.
Bacterial infection
I.
Viral infection
J.
Immediate haemolytic transfusion reaction
K.
Transfusion-associated graft versus host disease
L.
Massive transfusion reaction
M.
Air Embolism
Allergic reaction
Pathophysiology of FNHTR
FNHTR is thought to be caused by the reaction between leukocyte antibodies present in the plasma of a recipient reacting against leukocytes present in transfused (donor) red cells. However, platelet associated FNHTR seems to be related to the presence of pyrogenic cytokines released from leukocytes during the platelet storage. Leukoreduction (i.e. removal of white cells prior to transfusion) of the cellular blood components may effectively reduce the occurrence of FNHTR.
Difference between TRALI and TA-GvD
TRALI occurs if the donor’s plasma contains white cell antibodies incompatible with the recipient’s white cells. TRALI is characterised by chills, fever, dry cough and breathlessness with cardiac failure. TA-GvD is a rare complication in which donor T lymphocytes mount a response against the recipient’s lymphoid tissue. Typical symptoms include fever and erythematous macular papular rash. Other symptoms include cough, abdominal pain, vomiting and profuse diarrhoea.
Which Ab mediates cold autoimmune haemolysis
IgM
What can lead to cold-Ab mediated haemolysis
May be polycolonal and arise as a result of infection e.g. mycoplasma pneumonia or infectious mononucleosis
It can also be monoclonal, secondary to lymphoma
Pathophysiology of cold AIHA
In COLD-antibody mediated haemolysis, the Ab (usually IgM) may be polyclonal and arise as a result of infection (e.g mycoplasma pneumonia or infectious mononucleosis) or may be monoclonal secondary to a lymphoproliferative disorder (e.g. Non-Hodgekins Lymphoma). The red cells become coated with IgM antibodies in the cooler peripheral circulation. Complement is activated at slightly higher temperatures, resulting in intravascular haemolysis. IgM is detectable on the red cells at 4 deg C. At higher temperatures, IgM detaches from the red cell surface but complement can still be detected. Circulating free cold autoantibodies - cold agglutins - are also present in the patients serum. A direct Coombs’ test may be positive for complement (but not for antibodies, as the IgM antibodies elute from the red cell into the serum in vitro). In addition to cold avoidance, other Rx options include drugs such as chlorambucil.
Which Abs are associated with warma AIHA
IgG
With what conditions is warm AIHA associated?
0% of cases are idiopathic, but other associations include autoimmune diseases eg. SLE, or drugs.
Pathophysiology of warm AIHA
WARM autoimmune haemolytic anaemias are associated with IgG antibodies to red blood cells. These antibodies react best at body temperature. 50% of cases are idiopathic, but other associations include autoimmune diseases eg. SLE, or drugs. Red cells are opsonised with either antibody alone, or antibody and complement components, and subsequently removed by splenic macrophages. The patient’s red cells are direct Coombs’ test positive; they promptly agglutinate when mixed with antiglobulin reagent. Rx may be steroids or splenectomy.
How does PRV cause a low ferritin
the Hb, WBC and platelet counts would be raised together with a low ferritin. Ferritin falls because of the increased demand for iron due to increased haematopoesis.
An 18 year old African girl known to suffer from sickle cell anaemia develops a fever, sudden lethargy, pallor and arthralgia two months post-transfusion. Investigations reveal bone marrow red cell aplasia and a positive Paul-Bunnell test.
infection with erythrovirus (parvovirus) B19 may result in a false positive Paul Bunnell test’. PS. The red cell aplasia with haemoglobinopathy gives it away that its Parvovirus B19. Normally, we would mount a reticulocyte response and be assymptomatic (or slapped cheek in children), but sickle cell = reduced red cell lifespan, reticulocytopenia and marrow aplasia = crisis!!
Found in patients with Myeloma with low serum albumin and oedema.
A.
Bence-Jones proteins
B.
Extramedullary tumour deposits
C.
Paraprotein
D.
Amyloid
E.
Inflammation
F.
Osteoblasts
G.
Barry-Jane proteins
H.
Osteoclasts
Amyloid
Misfolded protein deposited in myeloma-associated amyloidosis
A.
Interferon α + ibuprofen
B.
Lenalidomide + low dose dexamethasone
C.
Melphalan + prednisolone
D.
Infliximab + budesonide
E.
Monoclonal gammopathy of undetermined significance (MGUS)
F.
AL amyloid
G.
IgM
H.
Multiple myeloma
I.
Thalidomide + high dose dexamethasone
J.
Bortezomib
K.
Rituximab
L.
Waldenstrom’s macroglobinaemia
M.
AA amyloid
N.
Aβ amyloid
O.
Anaemia & renal failure
AL amyloid
How can treatment of myeloma be categroised
Into those sutiable for auto-SCT and those who are not
Treatment of a patient with MM unsuitable for auto-SCT
Melphalan + Pred + thalidomide= first line
Melphalan + pred + bortezomib= second line ( can’t tolerate thalidomide)
Treatment of MM in patient sutiable for SCT
Use induction chemo:
Lenalidomide + Dex =first line
Bortezomib + dex= second line
Alkylating agents e.g. mephalan are best avoided for induction chemo as they may compromise SC reserve
Asymptomatic, serum monoclonal protein 10g/L, marrow plasma cells 15%, serum Ca 2.3 mmol/L, estimated GFR 30 mL/min, Hb 8 g/dL, lytic vertebral lesions
A.
Primary hyperparathyroidism
B.
Waldenstrom’s macroglobulinaemia
C.
MGUS
D.
Sarcoidosis
E.
Solitary plasmacytoma of bone (SPB)
F.
Metastatic breast cancer
G.
Primary amyloidosis
H.
Secondary hyperparathyroidism
I.
CLL
J.
Multiple myeloma
K.
Smouldering multiple myeloma
MM
Previously fit 35yo Afro Carribean female, sudden onset back pain, no history of trauma, 1 month history polyuria, urine specific gravity raised but dipstick negative for protein (and normal in all other respects), estimated GFR 70mL/min, vertebral fracture and bilateral femoral neck fractures on radiograph
A.
Primary hyperparathyroidism
B.
Waldenstrom’s macroglobulinaemia
C.
MGUS
D.
Sarcoidosis
E.
Solitary plasmacytoma of bone (SPB)
F.
Metastatic breast cancer
G.
Primary amyloidosis
H.
Secondary hyperparathyroidism
I.
CLL
J.
Multiple myeloma
K.
Smouldering multiple myeloma
.
MM
Asymptomatic, serum monoclonal protein 25g/L, marrow plasma cells 5%, serum Ca 2.3 mmol/L, estimated GFR 100mL/min, Hb 12.5 g/dL, skeletal survey normal
A.
Primary hyperparathyroidism
B.
Waldenstrom’s macroglobulinaemia
C.
MGUS
D.
Sarcoidosis
E.
Solitary plasmacytoma of bone (SPB)
F.
Metastatic breast cancer
G.
Primary amyloidosis
H.
Secondary hyperparathyroidism
I.
CLL
J.
Multiple myeloma
K.
Smouldering multiple myeloma
MGUS
Asymptomatic, serum monoclonal protein 30g/L, marrow plasma cells 10%, serum Ca 2.3 mmol/L, estimated GFR 100mL/min, Hb 12.5 g/dL, skeletal survey normal
A.
Primary hyperparathyroidism
B.
Waldenstrom’s macroglobulinaemia
C.
MGUS
D.
Sarcoidosis
E.
Solitary plasmacytoma of bone (SPB)
F.
Metastatic breast cancer
G.
Primary amyloidosis
H.
Secondary hyperparathyroidism
I.
CLL
J.
Multiple myeloma
K.
Smouldering multiple myeloma
Smouldering multiple myeloma
Which paraprotein is most commonly raised in patients with multiple myeloma?
IgG
Which cytokine is an important growth factor in the development of myeloma?
IL-6
Elevated levels imply a poor prognosis in myeloma patients
Beta a2 microglobulin
How is MM staged
Using the international staging system
Uses beta 2 microglobulin and albumin to stage a patient’s disease
Age and cytogenetics are the only other factors that impact on Px
A 65 yr old man presents to his GP with general malaise, weight loss and visual disturbances that he likens to looking through a watery car windscreen. On examination he has peripheral lymph node enlargement. Protein electrophoresis shows an IgM paraprotein.
A.
Metastatic carcinoma
B.
Multiple myeloma
C.
Monoclonal gammopathy of undetermined significance
D.
Chronic lymphocytic leukaemia
E.
Secondary amyloidosis
F.
Waldenstrom’s macroglobulinaemia
G.
Primary amyloidosis
Waldenstrom’s macroglobulinaemia is a malignant disease of B cells which are lymphoplasmacytoid in appearance. These cells secrete IgM paraprotein which gives rise to clinical manifestations. The disease is commonly seen in elderly men. It is an indolent disease with a median survival of 3 to 5 years, but some patients may survive 10 years or longer. It is regarded as a low grade non-Hodgkin’s lymphoma.
A 49-year-old woman presented with a 6-month history of vague aches and pains in her chest. On examination, she was overweight but had no abnormal physical signs. Protein electrophoresis showed a small paraprotein band in the gamma region; this band was an IgG of lambda type. A bone marrow biopsy showed only 12% plasma cells. There was no protein in her urine.
A.
Non-Hodgkin’s lymphoma
B.
Hairy cell leukaemia
C.
Sarcoidosis
D.
Acute leukaemia
E.
Multiple myeloma
F.
Hodgkin’s lymphoma
G.
Bone metastasis
H.
Fractured vertebrae
I.
Sezary syndrome
J.
Benign paraproteinaemia
Benign paraproteinaemia
A 71-year-old man presented with sharp, constant, low back pain, dating from a fall from a ladder 6 weeks earlier. He admitted to vague malaise for over 8 months. He had a raised serum calcium level (3.2mmol/l) but a normal alkaline phosphatase. X-rays of his back showed a small, punched-out lesion in the second lumbar vertebra and a Bone marrow biopsy showed an increased number of atypical plasma cells; these constituted 45% of the nucleated cells found on the film.
A.
Non-Hodgkin’s lymphoma
B.
Hairy cell leukaemia
C.
Sarcoidosis
D.
Acute leukaemia
E.
Multiple myeloma
F.
Hodgkin’s lymphoma
G.
Bone metastasis
H.
Fractured vertebrae
I.
Sezary syndrome
J.
Benign paraproteinaemia
Multiple myeloma
A 43 year old man presents to his GP with concerns over a tender lump on the left side of his abdomen. Investigation showed a normal haemoglobin but a mildly raised white-cell count (13.2 x 109/l). On the blood film these cells were mainly small mononuclear cells resembling lymphocytes. These cells stained positively for tartrate-resistant acid phosphatase.
A.
Non-Hodgkin’s lymphoma
B.
Hairy cell leukaemia
C.
Sarcoidosis
D.
Acute leukaemia
E.
Multiple myeloma
F.
Hodgkin’s lymphoma
G.
Bone metastasis
H.
Fractured vertebrae
I.
Sezary syndrome
J.
Benign paraproteinaemia
Hairy cell leukaemia
A 69 year old man presents with a complaint of right elbow pain. Radiography shows a lytic lesion in the area of the right proximal radius. Biopsy of the lesion reveals a mono-clonal population of plasma cells consistent with a plasmacytoma. A radiographic skeletal bone survey shows other similar lesions.
A.
Non-Hodgkin’s lymphoma
B.
Hairy cell leukaemia
C.
Sarcoidosis
D.
Acute leukaemia
E.
Multiple myeloma
F.
Hodgkin’s lymphoma
G.
Bone metastasis
H.
Fractured vertebrae
I.
Sezary syndrome
J.
Benign paraproteinaemia
MM
Corticosteroid refractory haemolytic anaemia
Splenectomy
Chronic lymphocytic leukaemia
A.
Folate
B.
Thymectomy
C.
Splenectomy
D.
Lenalidomide (Revlimid) and low dose dexamethasone followed by autologous stem cell transplant (SCT)
E.
Anagrelide
F.
Campath (anti CD52, alemtuzumab)
G.
Imatinib
H.
Regular surveillance but no active treatment
I.
Bortezomib (Velcade)
J.
Venesection and aspirin
K.
Hydroxyurea
L.
Rituximab (anti CD20)
M.
Leucovorin (Folinic acid, Formyl tetrahydrofolate)
N.
Treatment with anti lymphocyte globulin
O.
Cyclophosphamide, fludarabine and rituximab
P.
Dexamethasone alone
Q.
Lenalidomide (Revlimid) and low dose dexamethasone followed by allogeneic stem cell transplant (SCT)
R.
Thalidomide and dexamethasone
S.
Melphalan
Cyclophosphamide, fludarabine and rituximab
Chronic myeloid leukaemia (also known as chronic granulocytic leukaemia)
A.
Folate
B.
Thymectomy
C.
Splenectomy
D.
Lenalidomide (Revlimid) and low dose dexamethasone followed by autologous stem cell transplant (SCT)
E.
Anagrelide
F.
Campath (anti CD52, alemtuzumab)
G.
Imatinib
H.
Regular surveillance but no active treatment
I.
Bortezomib (Velcade)
J.
Venesection and aspirin
K.
Hydroxyurea
L.
Rituximab (anti CD20)
M.
Leucovorin (Folinic acid, Formyl tetrahydrofolate)
N.
Treatment with anti lymphocyte globulin
O.
Cyclophosphamide, fludarabine and rituximab
P.
Dexamethasone alone
Q.
Lenalidomide (Revlimid) and low dose dexamethasone followed by allogeneic stem cell transplant (SCT)
R.
Thalidomide and dexamethasone
S.
Melphalan
Imatinib
Multiple myeloma
A.
Folate
B.
Thymectomy
C.
Splenectomy
D.
Lenalidomide (Revlimid) and low dose dexamethasone followed by autologous stem cell transplant (SCT)
E.
Anagrelide
F.
Campath (anti CD52, alemtuzumab)
G.
Imatinib
H.
Regular surveillance but no active treatment
I.
Bortezomib (Velcade)
J.
Venesection and aspirin
K.
Hydroxyurea
L.
Rituximab (anti CD20)
M.
Leucovorin (Folinic acid, Formyl tetrahydrofolate)
N.
Treatment with anti lymphocyte globulin
O.
Cyclophosphamide, fludarabine and rituximab
P.
Dexamethasone alone
Q.
Lenalidomide (Revlimid) and low dose dexamethasone followed by allogeneic stem cell transplant (SCT)
R.
Thalidomide and dexamethasone
S.
Melphalan
Lenalidomide (Revlimid) and low dose dexamethasone followed by autologous stem cell transplant (SCT)
Treatment of MGUS and smouldering myeloma
Regular surveillance but no active treatment
Used in solid organ transplantation, multiple sclerosis, NHL. Depletes lymphocytes. Side effects include ITP and Graves disease.
A.
Folate
B.
Thymectomy
C.
Splenectomy
D.
Lenalidomide (Revlimid) and low dose dexamethasone followed by autologous stem cell transplant (SCT)
E.
Anagrelide
F.
Campath (anti CD52, alemtuzumab)
G.
Imatinib
H.
Regular surveillance but no active treatment
I.
Bortezomib (Velcade)
J.
Venesection and aspirin
K.
Hydroxyurea
L.
Rituximab (anti CD20)
M.
Leucovorin (Folinic acid, Formyl tetrahydrofolate)
N.
Treatment with anti lymphocyte globulin
O.
Cyclophosphamide, fludarabine and rituximab
P.
Dexamethasone alone
Q.
Lenalidomide (Revlimid) and low dose dexamethasone followed by allogeneic stem cell transplant (SCT)
R.
Thalidomide and dexamethasone
S.
Melphalan
Campath (anti CD52, alemtuzumab)
Add-on anti-proteasome drug for myeloma
Bortezomib (Velcade)
Anti-proliferative used in polycythaemia rubra vera and essential thrombocythaemia
Hydroxyurea
Reduces platelet count in thrombocythaemia but causes palpitations, tachycardia, fluid retention
Anagrelide
Standard prophylaxis accompanying a once weekly myelosuppressant when used in rheumatoid arthritis
Folate
Rescue drug after high dose methotrexate is used for gestational trophoblastic disease or intrathecal ALL
Leucovorin (Folinic acid, Formyl tetrahydrofolate)
Used in solid organ transplantation, multiple sclerosis, NHL. Depletes B lymphocytes more than T lymphocytes.
A.
Folate
B.
Thymectomy
C.
Splenectomy
D.
Lenalidomide (Revlimid) and low dose dexamethasone followed by autologous stem cell transplant (SCT)
E.
Anagrelide
F.
Campath (anti CD52, alemtuzumab)
G.
Imatinib
H.
Regular surveillance but no active treatment
I.
Bortezomib (Velcade)
J.
Venesection and aspirin
K.
Hydroxyurea
L.
Rituximab (anti CD20)
M.
Leucovorin (Folinic acid, Formyl tetrahydrofolate)
N.
Treatment with anti lymphocyte globulin
O.
Cyclophosphamide, fludarabine and rituximab
P.
Dexamethasone alone
Q.
Lenalidomide (Revlimid) and low dose dexamethasone followed by allogeneic stem cell transplant (SCT)
R.
Thalidomide and dexamethasone
S.
Melphalan
Rituximab (anti CD20)
Myeloma
A.
Variable B cell
B.
Indolent B cell
C.
Aggressive B cell
D.
Variable T cell
E.
Aggressive T cell
F.
Indolent T cell
Variable B cell
Most easily curable B cell neoplasm
A.
Variable B cell
B.
Indolent B cell
C.
Aggressive B cell
D.
Variable T cell
E.
Aggressive T cell
F.
Indolent T cell
Aggressive B cell
Follicular lymphoma
A.
Variable B cell
B.
Indolent B cell
C.
Aggressive B cell
D.
Variable T cell
E.
Aggressive T cell
F.
Indolent T cell
Indolent B cell
An elderly lady is found to suffer from Epstein-Barr virus. She is late noted to have splenic enlargement.
A.
Multiple Myeloma
B.
Hairy Cell Leukaemia
C.
Radiation Therapy Alone
D.
Aplastic Anaemia
E.
Chronic Lymphocytic Leukaemia
F.
Acute Myeloid Leukaemia
G.
Polycythaemia Rubra Vera
H.
Combination Chemotherapy
I.
ABVD combination chemotherapy + radiotherapy if required
J.
Hodgkins Stage IIA
K.
Myelodysplasia
L.
Hodgkins Disease Stage IB
M.
Burkitts Lymphoma
N.
Primary Amyloidosis
Burkitts Lymphoma
Advanced Hodgkins disease should be treated with…..
A.
Multiple Myeloma
B.
Hairy Cell Leukaemia
C.
Radiation Therapy Alone
D.
Aplastic Anaemia
E.
Chronic Lymphocytic Leukaemia
F.
Acute Myeloid Leukaemia
G.
Polycythaemia Rubra Vera
H.
Combination Chemotherapy
I.
ABVD combination chemotherapy + radiotherapy if required
J.
Hodgkins Stage IIA
K.
Myelodysplasia
L.
Hodgkins Disease Stage IB
M.
Burkitts Lymphoma
N.
Primary Amyloidosis
Combination chemotherapy
Pathological stage IA or IIA disease may be treated with……
A.
Multiple Myeloma
B.
Hairy Cell Leukaemia
C.
Radiation Therapy Alone
D.
Aplastic Anaemia
E.
Chronic Lymphocytic Leukaemia
F.
Acute Myeloid Leukaemia
G.
Polycythaemia Rubra Vera
H.
Combination Chemotherapy
I.
ABVD combination chemotherapy + radiotherapy if required
J.
Hodgkins Stage IIA
K.
Myelodysplasia
L.
Hodgkins Disease Stage IB
M.
Burkitts Lymphoma
N.
Primary Amyloidosis
ABVD combination chemotherapy + radiotherapy if required
is an oncogenic virus and may be associated with Burkitt’s Lymphoma and nasopharygeal carcinoma.
Q5: Treatment for Stage I + II Hodgkin’s Lymphoma used to be combined chemo + radiotherapy, but radiotherapy is dangerous in that it increases risk of secondary malignancies eg breast cancer and end-organ damage eg heart disease leading to deaths by MI, stroke, CHF. Reducing the field treated with radiotherapy reduces but does not eliminate these risks. One large review (DOI 10.1007/s11899-011-0088-8) says ‘Most young patients with non-bulky, localised, early-stage disease do extremely well on chemotherapy alone’. There are a number of trials currently looking at how to better identify the patients for whom the benefits of radiotherapy would out-weigh the risks.
A subtype of Non-Hodgkin lymphoma associated with very aggressive disease.
A.
Night sweats
B.
Hodgkin lymphoma
C.
Aggressive
D.
Follicular lymphoma
E.
Stage IIIB
F.
Stage IIA
G.
Pruritis
H.
Non-Hodgkin lymphoma
I.
Very aggressive
J.
Diffuse large B cell lymphoma
K.
Indolent
L.
Burkitt’s lymphoma
M.
Epstein-Barr virus
N.
Pel-Ebstein fever
Burkitt’s lymphoma
A classical but rare constitutional symptom of Hodgkin lymphoma
A.
Night sweats
B.
Hodgkin lymphoma
C.
Aggressive
D.
Follicular lymphoma
E.
Stage IIIB
F.
Stage IIA
G.
Pruritis
H.
Non-Hodgkin lymphoma
I.
Very aggressive
J.
Diffuse large B cell lymphoma
K.
Indolent
L.
Burkitt’s lymphoma
M.
Epstein-Barr virus
N.
Pel-Ebstein fever
A Pel Ebstein fever is one which has periods of high temperature separated by 15 to 28 day periods of normal temperature. Classically associated with Hodgekins lymphoma. Other differentials include tuberculosis and renal adenocarcinoma. Some physicians believe Pel-Ebstein fever doesn’t actually exist! For more information, see attached file.
A 61 year old lady complains to her GP of morning stiffness and aching in her hips. She also suffers from anorexia, fatigue and occasional night sweats. She is found to have a raised ESR. Of note she has had giant cell arterititis in the past. What is the most likely diagnosis from the list above.
A.
Eosinophils
B.
Anaemia of chronic disease
C.
Microangiopathic haemolytic anaemia
D.
Monocytes
E.
Systemic lupus erythematosis
F.
Rheumatoid arthritis
G.
Polymyalgia rheumatica
H.
Iron deficiency anaemia
I.
Leucoerythroblastic anaemia
J.
Diverticular disease
K.
Neutrophils
Polymyalgia rheumatica
An 81 year old man with known prostatic carcinoma presents to his GP with severe bone pain. Blood tests reveal a mild anaemia and peripheral blood film shows nucleated red blood cells and immature myeloid cells. What are these haematological features collectively known as?
A.
Eosinophils
B.
Anaemia of chronic disease
C.
Microangiopathic haemolytic anaemia
D.
Monocytes
E.
Systemic lupus erythematosis
F.
Rheumatoid arthritis
G.
Polymyalgia rheumatica
H.
Iron deficiency anaemia
I.
Leucoerythroblastic anaemia
J.
Diverticular disease
K.
Neutrophils
Leucoerythroblastic anaemia
A 51 year old man is having work up for palliative surgery due to gastric adenocarcinoma. He is found to be anaemic, with high a reticulocyte count and fragmented red blood cells on blood smear. What is this anaemia known as?
A.
Eosinophils
B.
Anaemia of chronic disease
C.
Microangiopathic haemolytic anaemia
D.
Monocytes
E.
Systemic lupus erythematosis
F.
Rheumatoid arthritis
G.
Polymyalgia rheumatica
H.
Iron deficiency anaemia
I.
Leucoerythroblastic anaemia
J.
Diverticular disease
K.
Neutrophils
Microangiopathic haemolytic anaemia
A 21 year old student recently returning from India complains to his GP of cough, headache and diarrhoea. He is febrile and rose spots are present on his chest. Blood culture reveals salmonella typhi. Which immune cells out of the list are most likely to be raised?
A.
Eosinophils
B.
Anaemia of chronic disease
C.
Microangiopathic haemolytic anaemia
D.
Monocytes
E.
Systemic lupus erythematosis
F.
Rheumatoid arthritis
G.
Polymyalgia rheumatica
H.
Iron deficiency anaemia
I.
Leucoerythroblastic anaemia
J.
Diverticular disease
K.
Neutrophils
Monocytes
A markedly raised haemoglobin in a patient with renal cell carcinoma.
A.
Microangiopathic haemolytic anaemia
B.
Leucoerythroblastic anaemia
C.
Type 1 hypersensitivity reaction
D.
Secondary true polycythaemia
E.
Autoimmune haemolytic anaemia
F.
Rheumatoid arthritis
G.
Polycythaemia vera
H.
Parasitic infestation
I.
Brucella infection
J.
Acute fungal infection
Secondary true polycythaemia
Monocytosis but with a normal neutrophil count.
A.
Microangiopathic haemolytic anaemia
B.
Leucoerythroblastic anaemia
C.
Type 1 hypersensitivity reaction
D.
Secondary true polycythaemia
E.
Autoimmune haemolytic anaemia
F.
Rheumatoid arthritis
G.
Polycythaemia vera
H.
Parasitic infestation
I.
Brucella infection
J.
Acute fungal infection
Brucella infection
A markedly raised haemoglobin in a patient with splenomegaly
A.
Microangiopathic haemolytic anaemia
B.
Leucoerythroblastic anaemia
C.
Type 1 hypersensitivity reaction
D.
Secondary true polycythaemia
E.
Autoimmune haemolytic anaemia
F.
Rheumatoid arthritis
G.
Polycythaemia vera
H.
Parasitic infestation
I.
Brucella infection
J.
Acute fungal infection
Polycythaemia vera
Neutrophilia with visible toxic granulation and vacuoles on the blood film. The monocyte count is normal.
A.
Microangiopathic haemolytic anaemia
B.
Leucoerythroblastic anaemia
C.
Type 1 hypersensitivity reaction
D.
Secondary true polycythaemia
E.
Autoimmune haemolytic anaemia
F.
Rheumatoid arthritis
G.
Polycythaemia vera
H.
Parasitic infestation
I.
Brucella infection
J.
Acute fungal infection
Acute fungal infection
Sezary syndrome
Sézary syndrome is an aggressive form of a type of blood cancer called cutaneous T-cell lymphoma. Cutaneous T-cell lymphomas occur when certain white blood cells, called T cells, become cancerous; these cancers characteristically affect the skin, causing different types of skin lesions
Prolonged APTT
Normal PT
Normal bleeding time
normal vWF
Haemophilia
Prolonged APTT
Prolonged bleedeing time
Low vWF (normal in VWD2- functional abnormality)
Factor VIII levels may also be low
vWD
A young boy is referred to you because of prolonged bleeding following circumcision. You also note some bleeding of the gums. Coagulation tests reveal a normal PT but a raised APTT and an increased Bleeding Time. Analysis of clotting factors reveals a low Factor VIII.
vWD
A 9 month old boy presents to A&E with excessive bleeding following circumcision. Laboratory investigations reveal a prolonged activated partial thromblastin time (APTT), normal prothrombin time (PT) and a factor VIII level which is 10% of normal. Bleeding time is normal. What is the likely diagnosis?
Haemophilia A
A 65-year-old man is referred to the haematology department by his GP after
initially presenting with tiredness, palpitations, petechiae and recent pneumonia.
His blood tests reveal Hb 9.8 (13–18 g/dL), MCV 128 (76–96 fL), reticulocyte
count 18 (25–100 × 109/L), 1.2 (2–7.5 × 109/L) and platelet count 125
(150–400 × 109/L).
B β-Thalassaemia
C Anaemia of chronic disease
D Blood loss
E Alcohol
F Vitamin B12 deficiency
G Renal failure
H Aplastic anaemia
I Lead poisoning
Aplastic anaemia (H) is caused by failure of the bone marrow resulting
in a pancytopenia and hypocellular bone marrow. Eighty per cent
of cases are idiopathic, although 10 per cent are primary (dyskeratosis
congenita and Fanconi anaemia) and 10 per cent are secondary (viruses,
SLE, drugs and radiation). The pathological process involves CD8+/
HLA-DR+ T cell destruction of bone marrow resulting in fatty changes.
Investigations will reveal reduced Hb, reticulocytes, neutrophils, platelets
and bone marrow cellularity as well as a raised MCV. Macrocytosis
results from the release of fetal haemoglobin in an attempt to compensate
for reduced red cell production.
Microcytic hypochromic anaemia
Rouleaux formation
Raised ferritin
Reduced serum Fe and TIBC
ACD
Normocytic anaemia
Blood loss can cause this due to the reduced number of circulating RBCs
Basphillic stippling
Microcytic anaemia
Suggestive of Pb poisoning
Causes of warm type AIHA
IgG mediated and occurs at 37 deg
Lymphoproliferative diseases
Autoimmune diseases
Causes of cold type AIHA
IgM mediated and occurs at less than 4
Mycoplasma or EBV infection
Rare stem cell disorder resulting in intravascular haemolysis, Hburia and thrombophilia
PNH
Causes of anisocytosis
IDA most common
Thalassaemia
Megaloblastic anaemia
Sideroblastic anaemia all causative too
Dacrocytes
Tear drop cells caused by myelofibrosis
Blood film will demonstrate leuko-erythroblasts,
tear-drop cells and circulating megakaryocytes.
Myelofibrosis
Occurs due to extra-medullary haematopoeisis
Remember dry tap on BM aspirate with splenomegaly
Causes of Heinz bodies
Most commonly caused by erythrocyte enzyme deficiencies i.e.
G6PDD
NADPHD
Chronic liver disease and alpha thalassaemia
Rouleaux formation
Occurs in high plasma protein states e.g. MM
Target cells
Erythrocytes with a central area of staining, ring of pallor and an outer ring of staining.
Formed in thalassaemia, asplenia and liver disease
Pappenheimer bodies
Granules of iron found within erythrocytes
Pb poisoning
Sideroblastic anaemia
Haemolytic anaemia
A Immune thrombocytopenic
purpura
B Idiopathic thrombotic
thrombocytopenic purpura
C Disseminated intravascular
coagulation
D Glanzmann’s thrombasthenia
E Von Willebrand disease
F Haemophilia A
G Haemophilia B
H Hereditary haemorrhagic
telangiectasia
I Bernard–Soulier syndrome
A 4-year-old girl is seen by her GP due to recent onset petechiae on her feet
and bleeding of her gums when she brushes her teeth. The child’s platelet count
is found to be 12 500 per μL. The GP prescribes prednisolone and reassures the
child’s mother that the bleeding will resolve.
Immune thrombocytopenic purpura (ITP; A) may follow either an acute or
chronic disease process. Acute ITP most commonly occurs in children, usually
occurring 2 weeks after a viral illness. It is a type 2 hypersensitivity
reaction, with IgG binding to virus-coated platelets. The fall in platelets is
very low (less than 20 × 109/L) but is a self-limiting condition (few weeks).
Chronic ITP is gradual in onset with no history of previous viral infection.
It is also a type 2 hypersensitivity reaction with IgG targeting GLP-2b/3a.
Pentad in TTP
MAHA
Renal failure
Thrombocytopenia
Fever
Neurological signs
Pathophysiology of TTP
Mutation in ADAM-ST13 gene coding for a protease that cleaves vWD allows for the formation of vWF multimers enabling platelet thrombi to form, causing organ damage
TTP, as with other microangiopathic hemolytic anemias (MAHAs), is caused by spontaneous aggregation of platelets and activation of coagulation in the small blood vessels. Platelets are consumed in the aggregation process, and bind vWF. These platelet-vWF complexes form small blood clots which circulate in the blood vessels and cause shearing of red blood cells, resulting in their rupture.[3]
Roughly, the two forms of TTP are idiopathic and secondary TTP. A special case is the inherited deficiency of ADAMTS13, known as the Upshaw-Schülman syndrome
Investigations will reveal a high/
normal APTT, low factor 8 levels, low ristocetin cofactor activity, poor
ristocetin aggregation and normal PTT,
vWD
A Factor V Leiden
B Antiphospholipid syndrome
C Malignancy
D Protein S deficiency
E Antithrombin deficiency
F Prothrombin G20210A mutation
G Oral contraceptive pill
H Buerger’s disease
I Chronic liver disease
1 A 35-year-old Caucasian man presents to accident and emergency with deep
pain and swelling in his left calf. His past medical history reveals history of
recurrent DVTs. The patient’s notes reveal a letter from his haematologist who
had diagnosed a condition caused by a substitution mutation.
Prothrombin G20210A (F) is an inherited thrombophilia caused by the
substitution of guanine with adenine at the 20210 position of the prothrombin
gene. Physiologically, prothrombin promotes clotting after
a blood vessel has been damaged. The G20210A causes the amplification
of prothrombin production thereby increasing the risk of clotting,
and causing a predisposition to deep vein thrombosis and pulmonary
embolism.
The prevalence of the mutation is approximately 5 per cent
in the Caucasian population, the race with the greatest preponderance.
5 A 37-year-old man presents to accident and emergency with shortness of
breath and severe pleuritic chest pain. A CTPA reveals the diagnosis of pulmonary
embolism. The patient’s haematological records state the patient has a
condition that leads to the persistence of factors 5a and 8a causing increased
risk of venous thrombosis.
Protein S deficiency (D) is associated with the impaired degradation of
factors Va and VIIIa. Protein S and protein C are physiological anticoagulants.
Deficiency of protein S leads to persistence of factors 5a and
8a in the circulation and hence patients have a susceptibility to venous
thrombosis. Three types of protein S deficiency exist: type I (quantitative
defect) and types II and III (qualitative defect). Since protein S is a
vitamin K dependent anticoagulant, warfarin treatment and liver disease
may also lead to venous thrombosis in rare cases (the majority of cases
show increased bleeding).
Why does pancreatic cancer predispose to thrombosis
Because tumour cells express tissue factor
4 A 56-year-old man is given a blood transfusion following severe blood loss
after a hip replacement operation. Three hours after the transfusion, the patient
develops shortness of breath, a dry cough and a fever of 39°C.
A Immediate haemolytic transfusion
reaction
B Febrile non-haemolytic reaction
C Iron overload
D IgA deficiency
E Transfusion related lung injury
F Bacterial infection
G Delayed haemolytic transfusion
reaction
H Fluid overload
I Graft versus host disease
Transfusion-related lung injury (TRALI; E) is characterized by acute
non-cardiogenic pulmonary oedema that occurs within 6 hours following
blood transfusion. The pathogenesis of TRALI involves the presence
of anti-white blood cell antibodies in the donor blood that attack host
leukocytes; sensitizing events in donors include previous blood transfusion
or transplantation. Clinical features of TRALI are dry cough, dyspnoea
and fever.
Which ABO incompatibility causes the most severe IHTR
Group O patient infused with group A blood
What is delayed TR also known as
Non-ABo reacition
A Acute lymphoblastic leukaemia
B Acute promyelocytic leukaemia
C Chronic myeloid leukaemia
D Chronic lymphocytic leukaemia
E Hairy cell leukaemia
F T-cell prolymphocytic leukaemia
G Large granular lymphocytic
leukaemia
H Adult T-cell leukaemia
I Acute myeloid leukaemia
2 A 41-year-old man is referred to a haematologist by his general practitioner
after several recent chest infections and tiredness. On examination, bruises
are seen on his lower limbs as well as splenomegaly. Initial blood tests reveal a
pancytopenia. Further testing demonstrates the presence of tumour cells that
express tartrate-resistant acid phosphatase
Hairy cell leukaemia (HCL; E) is a haematological malignancy of
B lymphocytes and a subtype of chronic lymphocytic leukaemia. It
most commonly occurs in middle-aged men. The cancer derives its
name from the fine hair-like projections that are seen on tumour cells
on microscopy. Cell surface markers include CD25 (IL-2 receptor) and
CD11c (adhesion molecule). Diagnosis can be confirmed by the presence
of tartrate-resistant acid phosphatase (TRAP) on cytochemical analysis.
Clinical features relate to invasion of the spleen (splenomegaly), liver
(hepatomegaly) and bone marrow (pancytopenia).
Characteristic clover leaf appearance of nuclei
Adult T cell leukaemia
caused by a translocation mutation forming
PML-RAR leading to proliferation of promyelocytes.
Acute promyelocytic leukaemia (APML; B) is the M3 subtype of acute
myeloid leukaemia
The most common causative mutation is an inversion in chromosome
14: inv 14(q11;q32).
T-cell prolymphocytic leukaemia (T-PLL; F) is an aggressive T-cell leukaemia
characterized by the presence
of large lymphocytes in the blood stream and bone marrow that
contain azurophilic granules.
Large granular lymphocytic leukaemia
binucleate/multinucleate cells with abundant
cytoplasm, inclusion-like nucleoli and surrounded by eosinophils
Reed–Sternberg cells
A 60-year-old man presents to his GP with malaise, night sweats and weight
loss. On examination the patient is found to have generalized lymphadenopathy
and hepatomegaly. Cytogenetic investigation a few weeks later by a haematologist
reveals a translocation between chromosomes 11 and 14, which has caused
overexpression of the BCL-2 protein
A Diffuse large B-cell lymphoma
B Burkitt lymphoma
C Follicular lymphoma
D Small lymphocytic leukaemia
E Mantle cell lymphoma
F Peripheral T-cell lymphoma
G Mycosis fungoides
H Angiocentric lymphoma
I Hodgkin’s lymphoma
Mantle cell lymphoma (MCL; E) is an aggressive B-cell lymphoma primarily
affecting elderly men. The most common cause is a translocation
between chromosomes 11 and 14, involving the BCL-1 locus and
Ig heavy chain locus, therefore leading to over-expression of cyclin D1.
Over-expression of cyclin D1 leads to dysregulation of the cell cycle.
Clinically, generalized lymphadenopathy, as well as bone marrow and
liver infiltration, are common. Hodgkin’s lymphoma can be split into
classical and lymphocyte predominant nodular (LPN) subtypes.
A Diffuse large B-cell lymphoma
B Burkitt lymphoma
C Follicular lymphoma
D Small lymphocytic leukaemia
E Mantle cell lymphoma
F Peripheral T-cell lymphoma
G Mycosis fungoides
H Angiocentric lymphoma
I Hodgkin’s lymphoma
A 40-year-old woman is referred to a haematologist after she is found to have
generalized, painless lymphadenopathy. A report on tumour cell morphology
states the presence of both centrocytes and centroblasts.
Follicular lymphoma (C) is caused most commonly by a translocation
between chromosomes 14 and 18, leading to over-expression of the
BCL-2 protein. Over-expression of BCL-2 causes inhibition of apoptosis,
promoting the survival of tumour cells. Tumour cells in follicular
lymphoma are characterized by centrocytes (small B cells with irregular
nuclei and reduced cytoplasm) and centroblasts (larger B cells with
multiple nuclei). Clinical features include painless, generalized lymphadenopathy.
Follicular lymphoma usually presents in middle-aged patients
and has a non-aggressive course but is difficult to cure.
A Diffuse large B-cell lymphoma
B Burkitt lymphoma
C Follicular lymphoma
D Small lymphocytic leukaemia
E Mantle cell lymphoma
F Peripheral T-cell lymphoma
G Mycosis fungoides
H Angiocentric lymphoma
I Hodgkin’s lymphoma
62-year-old HIV-positive man presents to a haematologist with a 3-month
history of weight loss and tiredness. On examination, the patient has a mass on
his neck which the patient states has been rapidly growing. Staining of biopsy
tissue demonstrates the present of large B cells which are positive for EBV.
Diffuse large B-cell lymphoma (DLBL; A) is a haematological malignancy
most commonly affecting the elderly, characterized by large lymphocytes
which have a diffuse pattern of growth. Common chromosomal abnormalities
which contribute to the development of DLBL include the t(14;18)
translocation which is characteristic of follicular lymphoma; this suggests
that follicular lymphoma may undergo a degree of transformation to cause
DLBL in such circumstances. Tumour cells that have follicular lymphoma
morphology may be present at other sites. Two subtypes of DLBL have been
described, both of which are associated with immunodeficiency: immunodeficiency-
associated large B-cell lymphoma (linked to latent EBV infection)
and body cavity-based large cell lymphoma (linked to HHV8 infection).
indistinguishable from chronic
lymphocytic leukaemia (CLL) in terms of genetics and morphology but
more commonly presents with greater peripheral blood lymphocytosis
than CLL.
Small lymphocytic lymphoma
presents in adulthood as cutaneous masses
most commonly in the nasal area. Tumour cells will express NK-cell
markers and commonly may be infected with EBV.
Angiocentric lymphoma
A 72-year-old man presents with a 1-month history of fever, night sweats and
weight loss. Blood tests reveal a monocyte count of 1400/mm3 in the peripheral
blood and a bone marrow biopsy demonstrates that myeloblasts constitute 16
per cent of his bone marrow.
A Essential thrombocythaemia
B Myelofibrosis
C Chronic myelo-monocytic
leukaemia
D Refractory anaemia with excess
blasts
E Polycythaemia rubravera
F Refractory anaemia with ringed
sideroblasts
G Refractory anaemia
H 5q-Syndrome
I Multiple myeloma
Chronic myelo-monocytic leukaemia (CMML; C) is a myelodysplastic/
myeloproliferative disease which most commonly affects the elderly
population, defined by a monocytosis of >1000/mm3 and increased
number of monocytes in the bone marrow. Myeloblasts make up <5
per cent of the peripheral blood and <20 per cent of the bone marrow.
Eosinophilia may be present in CMML associated with a t(5;12) translocation.
The Philadelphia chromosome BCR/ABL fusion gene is not
responsible for causing CMML. Commonly, patients will present with
fever, fatigue, night sweats; on examination hepatomegaly and/or more
commonly splenomegaly may be present.
Features include hypo-lobulated megakaryocytes and an increased/
normal platelet count.
5q-Syndrome (H) is caused by deletion of the long arm of chromosome
5.
is defined by fewer than 5 per cent myeloblasts
present in the bone marrow.
Refractory anaemia
is a myelodysplastic
disease characterized by fewer than 5 per cent myeloblasts in the bone
marrow, but greater than 15 per cent erythrocyte precursors stuffed with
iron in their mitochondria.
Refractory anaemia with ringed sideroblasts
Refractory anaemia with excess blasts (D)
is a myelodysplastic disease
that may be classified into type 1 (5–9 per cent myeloblasts in the bone
marrow) or type 2 (10–19 per cent myeloblasts in the bone marrow).
Pathophysiology in ACD
Il-6 produced by macrophages induced hepcidin production by the liver which has the effect of retaining Fe in macrophages and decreases export from enterocytes (thus reducing plasma iron levels)
What conditions can cause a monocytosis
Sarcoidosis
Brucellosis, typohid, VZV
CMML
Features of FHTR
Febrile haemolytic transfusion reactions (A) typically occur less than
24 hours after the transfusion. These reactions are thought to be due to
antibodies in the patient reacting with white cell antigens in the donor
blood, or due to cytokines which build up in the blood products during
storage. These reactions usually only warrant slowing the transfusion,
and giving an anti-pyretic if needed.
Pencil cells
Type of elliptocyte that occur in IDA, thalassaemia and PK deficiency
Howell-Jolly bodies
Target cells
Occasional nucleated RBCs
Lymphocytosis
Macrocytosis
Acanthocytes
Hyposeplnism
Target cells
the 3 Hs
Hepatic pathology
Hyposplenism
Hbopathies
spiculated red cells that are found in hyposplenism,
α-β-lipoproteinaemia, chronic liver disease and α-thalassaemia trait
Acanthocytes
The PIIES
Haematological diseases in which splenectomy may be of benefit
Thalassaemias
Pyrukvate kinase
Immune haemolytic anaemia
Idiopathic thyrombocytopenic purpura
Elliptocytosis
Spherocytosis (hereditary)
HbA
a2
b2
HbA2
a2
d2
HbF
a2
g2
HbC
these patients may have a mild splenomegaly and haemolytic
anaemia. Haemoglobin C is similar to haemoglobin S in that it comprises
two normal alpha chains and two variant beta chains in which lysine
has replaced glutamic acid at position 6.
Pathogenesis of aplastic crises in parvovirus infection and SCD
The virus affects erythropoiesis by invading erythrocyte precursors and
destroying them. Infants and children with sickle cell disease initially
have no immunity to parvovirus B19, and their first exposure can lead
to pure red cell aplasia. In a normal individual the virus blocks red
cell production for 2 or 3 days with little consequence, but it can be
life threatening in sickle cell patients in whom the red cell life span is
already shortened. This can lead to profound anaemia over the course
of just a few days, and a dramatic drop in the reticulocyte count. Serum
IgM antibodies to parvovirus B19 can confirm the diagnosis, and blood
transfusion may be required.
A 26-year-old pregnant woman is found to have an Hb of 9.5 g/dL on a routine
blood test, with an MCV of 70. Serum electrophoresis reveals an Hb A2 of
3.9 per cent and Hb A of 96.1 per cent. Her ferritin levels are normal. The most
likely diagnosis is:
A Iron deficiency anaemia
B Cooley’s anaemia
C b-Thalassaemia intermedia
D b-Thalassaemia minor
E a-Thalassaemia
b-Thalassaemias are a group of genetic haemoglobinopathies that
essentially
result in reduced or absent formation of the beta chains of
haemoglobin leading to anaemia of varying degrees of severity. They are
prevalent in the Middle East, Central, South and South East Asia, Southern
China and around the Mediterranean. There are three main forms:
thalassaemia major, thalassaemia intermedia and thalassaemia minor.
In b-thalassaemia minor (D) only one of the b-globulin alleles is mutated,
so these individuals usually only have a well-tolerated microcytic anaemia
(Hb >9 g/dL) which is clinically asymptomatic. They might be picked
up on a routine blood test, with a low MCH and significantly low MCV
(<80 fL). They also have an increase in the fraction of Hb A2, as in this
case. In most people the fraction of Hb A2 (α2δ2) will be 1.5–3.5 per
cent, but in b-thalassaemia minor the proportion of Hb A2 is >3.5–4 per
cent to compensate for the reduced amount of normal haemoglobin, and
they might have a slight increase in Hb F. It can worsen in pregnancy, as
in this case
Cooley’s anaemia=
Beta thalassaemia major
Cold LID
Cold AIHA
Lymphoproliferative disease e.g. CLL, lymphomas
Infections: mycoplasma, EVC
Don’t know i.e. idiopathic
Treatment of cold AIHA
Avoiding cold conditions
Chlorambucil
Treat underlying cause
Treatment of warm AIHA
Steroids
Ig
Splenectomy
Presentation of PNH
Pancytopenia
New thrombus
HA
Paroxysmal nocturnal haemoglobinuria (B) is another rare acquired disease,
but one that is potentially life threatening. The resulting defect in
the red cell membrane leads to intravascular haemolysis. The disease has
three aspects: the most common way for it to present is with a haemolytic
anaemia, which may cause haemoglobinuria, especially overnight.
The second aspect is thrombophilia, which can present with visceral
thrombosis (e.g. CNS, pulmonary, mesenteric). The third aspect is deficient
haematopoiesis which can cause a pancytopenia with aplastic anaemia.
A 34-year-old woman with known Addison’s disease is brought to the GP by her
husband, as he is concerned that she keeps falling over at night. On examination
the GP notes that she has conjunctival pallor. A thorough neurological examination
reveals absent knee jerks, absent ankle jerks and extensor plantars bilaterally. Which
of the following is the most sensitive test for the condition she has developed?
A Anti-intrinsic factor antibodies
B Anti-endomysial cell antibodies
C Anti-smooth muscle antibodies
D Anti-parietal cell antibodies
E Anti-voltage gated calcium channel antibodies
Intrinsic factor antibodies (A) can be found in approximately 50 per
cent of patients, and are specific for pernicious anaemia but not as
sensitive as anti-parietal cell antibodies (D) which are found in >90
per cent of patients.
This woman has developed pernicious anaemia leading to vitamin B12
deficiency. It can be associated with other autoimmune conditions, such
as Addison’s disease or thyroid disease. Specifically, she has developed
a condition called subacute combined degeneration of the cord (SACD)
which has led to symmetrical loss of dorsal columns (resulting in loss
of touch and proprioception leading to ataxia, and LMN signs) and corticospinal
tract loss (leading to UMN signs), with sparing of pain and
temperature sensation (which is carried by spinothalamic tracts). The
ataxia and loss of joint position sense have resulted in her falling at
night, which may be exacerbated by optic atrophy – another manifestation
of vitamin B12 deficiency.
Remember that vitamin B12 is found in meat, fish and dairy products.
More common causes of vitamin B12 deficiency can be related to diet
(e.g. vegans) or to malabsorption. It is absorbed in the terminal ileum
after binding to intrinsic factor produced by the parietal cells in the
stomach. Causes of malabsorption can therefore be related to the stomach
(e.g. post gastrectomy, pernicious anaemia), or due to the terminal ileum
(e.g. Crohn’s, resection of the terminal ileum, bacterial overgrowth).
Pernicious anaemia is caused by an autoimmune atrophic gastritis when
autoantibodies are produced against parietal cells and intrinsic factor
itself. The lack of B12 impairs DNA synthesis in red blood cells, leading
to the production of large, megaloblastic erythrocytes.
- Low haemoglobin
- High MCV
- Low platelets and WCC if severe
- Hypersegmented neutrophils
- Megaloblasts in the bone marrow
- Cabot rings in RBCs
B12 deficiency
Causes of macrocytosis
- Megaloblastic: folate and B12 deef
- Non-megaloblastic RALPH
- Other haematological disorders e.g. myelodysplasia, aplastic anaemia, myeloma, myeloproliferative disorders
RALPH
Non-megaloblastic causes of macrocytic anaemia
Reticulocytosis
Alcohol
Liver disease
Pregnancy
Hypothyroidism
Drugs causing aplastic anaemia
All the Cs
Cytotoxics
Carbamezepine
Chloramphenicol
Anticonvulsants- phenytoin
A 50-year-old diabetic man sees his GP complaining of generalized tiredness and
a painful right knee. He is found on examination to have five finger breadths of
hepatomegaly. An X-ray of his right knee is reported as showing chondrocalcinosis.
His blood tests are likely to reveal:
A Raised MCV
B Raised total iron binding capacity
C Reduced serum ferritin
D Reduced iron level
E Raised transferrin saturation
This man has hereditary haemachromatosis, an inherited disorder of
iron metabolism. It is particularly common in those of Celtic descent,
and the gene responsible for the majority of cases is the HFE gene on
chromosome 6.
Increased iron absorption leads to deposition to multiple organs including:
• the liver (hepatomegaly, deranged LFTs)
• joints (arthralgia, chondrocalcinosis)
• pancreas (diabetes)
• heart (dilated cardiomyopathy)
• pituitary gland (hypogonadism and impotence)
• adrenals (adrenal insufficiency)
• skin (slate grey skin pigmentation)
Blood tests can show deranged LFTs as in this case, as well as a raised
serum ferritin, raised serum iron, reduced or normal total iron binding
capacity and raised transferrin saturation (E) (>80 per cent).
Low Fe
High TIBC/transferrin
Low transferrin saturation
Low ferritin
IDA
High Fe
Low or normal TIBC/transferrin
Low Transferrin saturation
High ferritin
Haemochormatosis
Low Fe
Low TIBC/Transferrin
Low transferrin saturation
High ferritin
ACD
High iron
Low TIBC/transferrin
High transferrin saturation
High ferritin
Chronic haemolysis
A 67-year-old woman presented with polyuria and polydipsia on a background
of ongoing bone pain. Her blood tests revealed a high calcium, and a serum
electrophoresis was sent. Her serum paraprotein was 25 g/L and a bone marrow
biopsy revealed 6 per cent clonal plasma cells. The most likely diagnosis is:
A Plasma cell dyscrasia
B Monoclonal gammopathy of undetermined significance
C Smouldering myeloma
D Multiple myeloma
E Hypercalcaemia with no evidence of underlying malignancy
Symptomatic myeloma (D):
Clonal plasma cells on bone marrow biopsy
• Paraprotein in either serum or urine
• Evidence of end-organ damage attributed to the plasma cell
disorder, commonly remembered using the acronym ‘CRAB’
(Calcium – high, Renal insufficiency, Anaemia and Bone lesions)
Symptomatic myeloma (D):
- Serum paraprotein >30 g/L AND/OR
- Clonal plasma cells >10 per cent on bone marrow biopsy AND
- NO myeloma-related organ or tissue impairment
Asymptomatic (smouldering) myeloma (C):
- Serum paraprotein <30 g/L AND
- Clonal plasma cells <10 per cent on bone marrow biopsy AND
- NO myeloma-related organ or tissue impairment
Monoclonal gammopathy of undetermined significance (MGUS)
A 39-year-old motorcyclist is admitted following a road traffic accident complicated
by severe burns. Several days later he is due to go home, when oozing
is noted from his cannula site and he has several nose bleeds. Repeat blood
tests reveal an Hb of 12.2 g/dL, WCC of 11.2 × 109/L, and platelets of 28 × 109/L.
A coagulation screen shows a prolonged APTT and PT. He also has a reduced
fibrinogen and raised D-dimers. The most likely diagnosis is:
A Liver failure
B Disseminated intravascular coagulation
C Thrombotic thrombocytopenic purpura
D Aplastic anaemia
E Heparin induced thrombocytopenia
This man has developed disseminated intravascular coagulation (DIC)
(B) following his severe burns. DIC is widespread pathological activation
of the clotting cascade in response to various insults. The cascade
is activated in various ways: one mechanism is the release of a transmembrane
glycoprotein called ‘tissue factor’ in response to cytokines or
vascular damage. This results in fibrin formation, which can eventually
cause occlusion of small and medium sized vessels and lead to organ
failure. At the same time, depletion of platelets and coagulation proteins
can result in bleeding (as in this case).
Causes of DIC
I’M STONeD
Immunological e.g. severe allergic reactions
Miscellaneous e.g. aortic aneurysm, liver disease
Sepsis
Trauma
Obstetric e.g. amniotic fluid embolism, placental abruption
Neoplastic
Drugs and toxins
Blood tests will typically reveal a thrombocytopenia,
raised PT and APTT, decreased fibrinogen and increased
D dimers.
DIC
MARCH with low plt
TTP
MAHA
A fever
Renal failure
Fluctuating CNS signs
Haematuria/proteinuria
Low platelet count
caused by the spirochaete Leptospira interrogans, and is spread by
infected rat urine. Although it can cause an abrupt onset of renal failure
and a fever, it would not typically result in thrombocytopenia or features
of MAHA.
Weil’s disease














A 56-year-old woman with known cirrhosis presents with falls. On examination
she is clinically jaundiced and rectal examination reveals malaena. Blood tests
reveal an INR of 2.2. She is diagnosed with decompensated chronic liver disease.
Which of the following is not a vitamin K dependent clotting factor?
A Thrombin
B Factor VII
C Factor VIII
D Protein C
E Factor X
C
What are the vitamin K dependant clotting factors?
II
VII
IX
X
Protein C S and Z
How does Warfarin influence clotting facotr production
Still produced but they lack efficacy due to an inability to interact with calcium or platelet facotr 3
What are the phases of the exrinsic pathway
Initiation phase:
Factor VIIa activates downstream factors Ix and X
Amplification phase:
Xa/Va activates prothrombin to thrombin which then activates XI, VIII and V resulting in the prothrombinase complex
This explodes with thrombin generating activity to produce fibrin rapidly and stabilise the platelet clot= propagation phase
Patients with chronic abdominal pain, weight loss, raised ESR with
a known abdominal aneurysm should prompt the thought of
an inflammatory
aneurysm subtype.
In these patients the inflammatory process
sometimes encases the nearby ureters causing obstruction and eventually
hydronephrosis.
A 62-year-old man presents with shortness of breath. This has been gradually
getting worse for the last few years and is associated with chronic productive
cough. He is a heavy smoker. His chest X-ray reveals a hyperexpanded chest
with no other abnormalities. His bloods tests are normal except for a raised haemoglobin
and raised haematocrit. What is the most likely cause for this?
A Polycythaemia rubra vera
B Idiopathic erythrocytosis
C Secondary polycythaemia
D Gaisbock’s disease
E Combined polycythaemia
Combined polycythaemia (E), also known as smoker’s polycythaemia,
has multiple aetiological factors. Cigarettes contain high concentrations
of carbon monoxide gas which bind avidly to haemoglobin, thus
displacing oxygen. This leads to increased erythropoietin (EPO) secretion
from the hypoxic renal interstitium. EPO promotes erythrocyteproliferation
and differentiation and prevents their apoptosis in the bone
marrow, thus increasing red cell mass. Smoking is also a significant risk
factor for chronic obstructive pulmonary disease, which is what this
man suffers from. The obstructed airways reduce oxygen delivery to
the alveoli and pulmonary vessels they supply thus causing a reduction
of oxygen supply furthering the hypoxia. Finally, smokers also have
an associated reduced plasma volume, thus increasing the relative concentration
of haemoglobin. This is therefore ‘combined’ because of the
presence of both increased red cell mass and reduced plasma volume.
Gaisbock’s disease
Haemoglobin may be raised with relative deficiency of plasma (i.e. relative or apparent polycythaemia, historically known as Gaisbock’s disease (D)).
the label given to those with polycythaemia secondary to JAK2 mutation,
but not with the V617F exon 14 mutation, e.g. exon 12 mutations.
Idiopathic erythrocytosis (B)
What is important to note re a positive diptick for blood?
May represent Hburia or myoglobinuria
an acquired clonal stem
cell disorder characterized by an abnormal erythrocyte sensitivity to
the lytic complement pathway. There is a deficiency of glucosyl phosphatidyl
inositol (GPI) linked proteins namely CD55 (decay-accelerating
factor) and CD59 (membrane inhibitor or reactive lysis).
Paroxysmal nocturnal haemoglobinuria
Causes of MAHA
Mechanical destruction of RBCs
E.g. Heart valve
DIC
TTP
HUS
What differentiates between apparent and true polycythaemia
Red cell count is measured as the number of
erythrocytes in a quantum of plasma, whereas red cell mass is determined
by isotope studies quoted as mL/kg. It is a measure of absolute
red cell mass and is therefore not affected if someone is dehydrated, for
example, where the relative plasma volume is reduced giving a falsely
high red cell concentration. There are many situations where the red cell
concentration and red cell mass do not parallel each other, e.g. vomiting,
diarrhoea or overuse of diuretics. If a patient has increased red cell
concentration this may therefore be absolute or relative – the latter
being secondary to reduced plasma volume thus making the polycythaemia
secondary to haemoconcentration. Absolute polycythaemia may
be primary or secondary.
von Willebrand’s disease is characterized by abnormal platelet aggregation when
they are exposed to:
A Streptomycin
B Aspirin
C Fibrinogen
D Collagen
E Ristocetin
von Willebrand’s disease (vWD) is characterized by a quantitive or qualititative defect in von Willebrand factor (vWF). Ristocetin, an antibiotic no longer used clinically, causes vWF to bind the platelet receptor glycoprotein Ib (GlpIb) through an unknown mechanism. If ristocetin is added to platelets with defective vWF or defective GlpIb (called Bernard–Soulier syndrome) then platelet aggregation does not occur. It will occur, however, with other pro-aggregative factors including collagen (D) and fibrinogen (C). If vWF or GlpIb is absent, aggregation does not occur with collagen as there is no molecular link between collagen and the platelet. However, this is the case with all patients with vWF.
Inherited platelet defects
Glanzmann’s thrombasthenia (an inherited lack of GlpIIb/IIIa)
where fibrinogen cannot cross-link platelets during the initial platelet
aggregative stage of thrombosis. Understanding these receptors and
their importance in platelet aggregation has led to the development of
powerful antiplatelet medications including adciximab, eptifibatide and
tirofiban. Other inherited platelet diseases include storage pool diseases,
e.g. grey platelet syndrome, Quebec platelet disorder, Hermansky–Pudlak
syndrome and Chediak–Higashi syndrome. These refer to defects of the
alpha and dense granules in the platelet which are released to promote
platelet aggregation.
What is the mechanism through which DS may increase the chance of AML
Dosage affect due to chromosome 21 duplication
associated with translocation and
dysregulation of the c-myc gene on chromosome 8 including t(8;14),
t(2;8) and t(8;22).
Burkitt’s lymphoma
Histologically, a nodular growth pattern with
a mixture of centrocytes and centroblasts is characteristic. The proportion
of centroblasts found determines the tumour grade which has therapeutic
implications. These cells are CD10 and BCL-6 positive in the majority. It
is usually indolent but can transform into a high grade lymphoma
Follicular lymphoma
arises mainly at extranodal sites due to
chronic antigenic stimulation and malignant transformation. It is a
B-cell NHL arising from marginal cells in the lymph node. There are
clinically three subtypes: extranodal marginal zone B-cell lymphoma of
mucosa associated lymphoid tissue (MALT); nodal marginal zone B-cell
lymphoma; and splenic marginal zone B-cell lymphoma
Marginal zone lymphoma
usually affects elderly men presenting with lymphadenopathy and constitutional
‘B’ symptoms (weight loss, fever, drenching night sweats) in
one-third. It is the most common histological subtype of NHL. The diagnosis
is usually made with an excisional biopsy demonstrating pan-B
cell markers, e.g. CD20, and CD79a. Histologically, there is effacement
of normal architecture by sheets of atypical lymphoid cells. The cell of
origin is the centrob
DLBL
It typically affects middleaged
men with lymphadenopathy and gastrointestinal tract involvement
including spleen and Waldeyer’s ring. It usually presents with advanced
disease and involves any region of the GI tract occasionally presenting
as multiple intestinal polyps. Nuclear staining for cyclin D1 is present
in 95 per cent of cases and is strongly associated with the t(11;14)
(q13;q32) mutation – a translocation between cyclin D1 locus and
immunoglobulin heavy chain locus. This
Mantle cell lymphoma
This cell is known as the lymphocytic and histiocytic cell
or L&H variant. Sometimes these cells are referred to as ‘popcorn’ cells
because their nucleus resembles an exploded popcorn kernel. This subtype
of HL accounts for 5 per cent of cases and has a bimodal age distribution
– children and adults between the ages of 30 and 40.
Nodular lymphocytic HL
(Non-classical)
is characterized by at least a partially
nodular grown pattern, with fibrous bands separating nodules.
Nodular sclerosing classical HL
heterogeneous group with a diffuse
or vaguely nodular growth patter without band-forming sclerosis.
Mixed cellularity HL
most commonly has a nodular growth pattern. In
this subtype, cells resembling L&H variants may be present making the
distinction from non-classical lymphoma more difficult. The background
infiltrate consists predominantly of lymphocytes, with rare eosinophils
or neutrophils.
Lymphocyte rich HL
subtype has a diffuse growth
pattern and appears hypocellular with a lack of inflammatory cells. This
subtype has a poor prognosis.
HL lymhpocyte depleted
Why can women be affected in G6PD?
Unlike some other X-linked conditions,
women can be affected due to the random nature of X chromosome
inactivation (lyonization) which leads to some cells being vulnerable
to oxidative stress.
Haptoglobin in intravascular and extravascular haemolysis
Haptoglobin circulates in the plasma and avidly binds to
free haemoglobin to be later removed by the reticuloendothelial system.
It is therefore reduced in intravascular haemolysis only. Extravascular
haemolysis occurs mainly in the spleen where free haemoglobin is not
released into the circulation and therefore haptoglobin levels are generally
unchanged.
A 35-year-old Asian woman presents with tiredness. The full blood count shows:
Haemoglobin: 10.1 g/dL (11.5–16.5)
Platelet count: 160 × 109 (150–400 × 109)
White cell count: 6.6 × 109 (4–11 × 109)
Mean cell volume: 62 fL (80–96 fL)
Hb A2: 6.3 per cent (2–3 per cent)
Which of the following is the most likely diagnosis?
A Sickle cell disease
B Acute myeloid leukaemia
C b-Thalassaemia major
D b-Thalassaemia trait
E Hereditary spherocytosis
This woman presents with microcytic anaemia, the most common cause
of which is iron deficiency. However, the mean cell volume is disproportionally
reduced compared with the degree of anaemia indicating there
might be a haemoglobinopathy present. The presence of increased Hb A2
confirms the diagnosis of b-thalassaemia trait.
raised RDW with increased MCHC is very suggestive of this condition.
Hereditary psherocytosis
A 62-year-old man presents with bruising and tiredness. Examination reveals
moderate splenomegly and his a reveal a normocytic anaemia with blood tests
platelet count of 900 × 109/L, neutrophilia, basophilia, numerous myelocytes and
4 per cent myeloblasts. The neutrophils have low leukocyte alkaline phosphatase
levels. Which of the following is likely to be present in this patient?
A t(9;22)
B t (8;14)
C BCR-Abl fusion gene only
D V617F point mutation in JAK2
E 5q-Syndrome
This patient exhibits features of chronic myeloid leukaemia as evidenced
by raised myeloid lineage cells including neutrophils, myelocytes
and basophils. The neutrophils are morphologically normal but
cytochemically different – a laboratory test sometimes used to differentiate
between reactive or leukaemoid neutrophilia and CML is the
leukocyte alkaline phosphatase. It is normal or high in the former, but
characteristically low in CML. Absolute basophilia is a universal finding
in CML, with absolute eosinophilia found in 90 per cent of cases.
A raised platelet count is also common in CML; a low platelet count,
however, should make one reconsider the diagnosis, e.g. myelodysplastic
syndromes
Which of the following patients has the worse prognosis?
A 25-year-old man with inguinal lymphadenopathy
B 25-year-old woman with mediastinal and inguinal lymphadenopathy
C 25-year-old woman with mediastinal and inguinal lymphadenopathy and
night sweats
D 25-year-old woman with mediastinal and inguinal lymphadenopathy with
5 per cent weight loss in last 6 months
E 25-year-old man with cervical and mediastinal lymphadenopathy
This question relies on the candidate’s knowledge and understanding of
the Ann Arbor staging system. This clinical staging system is relatively
intuitive – stages are between I and IV either in the absence or presence
of ‘B symptoms’. A simplified version of the classification is as follows:
• Stage I: involvement of a single lymph node region
• Stage II: involvement of two or more lymph node regions on the
same side of the diaphragm
• Stage III: involvement of lymph nodes on both sides of the
diaphragm
• Stage IV: extranodal spread (not spleen however, this is taken as a
lymph node)
The definition of B symptoms includes significant unexplained fever,
night sweats or unexplained weight loss of over 10 per cent during
6 months prior to diagnosis
Patient A would therefore be classified as Ia, patient B as
IIa, patient C as IIIb, patient D as IIIa, technically as she does not quite
fulfil the 10 per cent loss in 6 months and finally patient E as stage
IIa. Note that in Hodgkin’s lymphoma, the disease always spreads contiguously
whereas in non-Hodgkin’s lymphoma this is not always the
case.
A patient presents with acute promyelocytic leukaemia. What is the most likely
mechanism of underlying leukaemogenesis?
A Telomere shortening
B Aberrant fusion of two genes
C Impaired protein degredation
D Over-expression of cellular oncogene
E Post-translational modification
B Acute promyelocytic leukaemia is interesting for a number of reasons.
There is a reciprocal translocation between the long arms of chromosomes
15 and 17 giving the PML-RARA fusion gene (B).
This links the
retinoic acid receptor alpha (RARA) gene on chromosome 17 with the
promyelocytic leukaemia (PML) gene on chromosome 15. RARA is a
member of a family of retinoin-binding transcription factors that regulate
gene expression. It heterodimerizes with retinoid X receptor (RXR)
and binds to retinoic acid response elements to influence gene transcription.
In the absence of retinoic acid, the RARA/RXR dimer interacts
with another protein (nuclear corepressor) to repress gene transcription.
Therefore, addition of retinoic acid stimulates gene transcription. In
the setting of promyelocytic leukaemia, retinoic acid induces myeloid
differentiation
which is abnormally halted thus providing remission
by encouraging cell differentiation rather than cell death. The second
reason
this type of leukaemia is interesting is its association with disseminated
intravascular coagulopathy. The pathogenesis is not completely
understood but recognizing it early is important as treatment
with retinoic acid plus supportive therapy can lead to rapid improvement
in the coagulopathy.
A 16-year-old girl with mild von Willebrand’s disease is scheduled for a dental
extraction. She has had one previously where she required two units of blood
transfused. What is the most appropriate treatment for this patient prior to
surgery?
A Cryoprecipitate
B Desmopressin
C Fresh frozen plasma
D Vitamin K
E Recombinant factor VIII concentrate
This woman has mild von Willebrand’s disease (vWD) which can be
treated with desmopressin (B). There are three types of vWD – type I is
a quantitative deficiency of von Willebrand Factor (vWF), type II is a
qualitative defect in vWF whereas type III results in profound deficiency
in vWF. There are four subtypes of type II vWF (2A, 2B, 2M and 2N).
vWF is important in two ways; first it acts as a bridge between platelets
and between platelets and subendothelial structures at the site of
injury; and second it carries factor VIII which is a key molecule in the
clotting cascade. Desmopressin acts to increase vWF and factor VIII
concentration by encouraging its release from endothelial cell storage
sites. Desmopressin is efficacious in type I and most type II disease but
not in type III. This woman is known to have ‘mild’ disease thus making
desmopressin a viable option
Interestingly, desmopressin in patients
with type 2B will lead to a transient worsening of their thrombocytopenia.
Patients with type 2B vWD have increased binding of the abnormal
vWF to platelets causing sequestration and clearance of platelets.
This is worsened for desmopressin, if only for a few hours. Despite this,
there have been reports of patients benefiting from desmopressin.
An 80-year-old man presents with tiredness and lethargy. After initial work-up,
a diagnosis of myelodysplastic syndrome is suspected. Which of the following is
true about this condition?
A A blood film will typically show neutrophil toxic granulation
B If there are 1 per cent blasts of the total white cell count, this represents
leukaemic transformation
C Cytotoxic chemotherapy is first line treatment
D Mortality is more likely to be from infection than leukaemic transformation
E Absence of the short arm of chromosome 5 is a subtype
The myelodysplastic syndromes are a heterogeneous group of conditions
characterized by an abnormal clone of stem cells with impaired proliferation
and differentiation. The result is a peripheral cytopenia, qualitative
abnormalities in erythroid, myeloid and megakaryocyte maturation,
as well as increased risk of leukaemic transformation. The abnormalities,
both quantitative and qualitative, in neutrophils mean susceptibility to
bacterial infection is high and thus a corresponding increased likelihood
of mortality (D). Skin infections are particularly common and resistant
to treatment.
An 80-year-old man presents with tiredness and lethargy. After initial work-up,
a diagnosis of myelodysplastic syndrome is suspected. Which of the following is
true about this condition?
A A blood film will typically show neutrophil toxic granulation
B If there are 1 per cent blasts of the total white cell count, this represents
leukaemic transformation
C Cytotoxic chemotherapy is first line treatment
D Mortality is more likely to be from infection than leukaemic transformation
E Absence of the short arm of chromosome 5 is a subtype
Absence of the long arm of chromosome 5 is a specific subtype of MDS.
There is an interstitial deletion and it most commonly affects elderly
women. It may respond quite dramatically to lenolidamide, a thalidomide
derivative. Deletion of the short arm of chromosome 5 is associated
with Cri du chat syndrome – a genetic disorder unrelated to MDS,
named due to the characteristic cat cry made by affected children
(‘cri du chat’ from French meaning ‘call of the cat’).
It affects children and teenagers and has a characteristic chromosomal
translocation (t11;22)(q24;q12). It is negative for alkaline phosphatase
and positive for CD99 (MIC2) immunostain. It is more commonly found
in the pelvis and diaphysis/metaphysis of long bones than around the
knee. Widespread metastases and bone marrow involvement are frequent.
Ewing’s sarcoma
usually affect older patients. The prognosis is variable
depending on the grade of tumour. They usually grow slowly and
not only affect long bones but also the ribs, spine and pelvis. The only
treatment is surgical
excision as both chemotherapy and radiotherapy are
ineffective.
Chondrosarcoma
are both spindle cell malignant tumours, arising from stromal cells and
collectively they make up the majority of soft tissue sarcomas
Fibrosarcomas and malignant fibrous histiocytomas
The most common presentation is pain and a mass, which occurs
near a joint such as the knee, with the distal femur and proximal tibia
being the most common sites. X-rays show a mixed sclerotic and lytic
lesion in the metaphysis that may permeate the bone causing a soft tissue
mass and a periosteal reaction. Bone formation within the tumour is characteristic
of osteosarcoma and is usually visible on X-rays. Bone alkaline
phosphatase has significant value in diagnosing
Osteosarcoma
is
a form of fibrosing lung disease that is chronic and progressive. It presents
with shortness of breath and cough and is more likely to be seen in males
over the age of 50. On histopathology, fibrosis and cyst formation are seen.
Cryptogenic fibrosing alveolitis
These tumours, if well-differentiated, show keratin
pearls and cell junctions (or desmosomes), which form the characteristic
intercellular ‘prickles’.
Squamous cell carcinoma
has a very close association with smoking
and paraneoplastic
syndromes and is very chemo-sensitive. They are poorly differentiated
and the mutations commonly involved are p53 and RB1.
SCLC
is a type of fibrosing lung disease or
‘dusty lung’ caused by inorganic dust inhalation. It commonly affects the
upper lobes, while asbestosis affects the lower lobes more severely. It is
an alteration of the lung structure rather than neoplastic differentiation of
cells and is therefore unlikely to be the diagnosis for this patient.
Pneumoconiosis
is a benign lesion that is rapidly growing and
dome-shaped. It arises from the pilosebaceous glands and often resembles
SCC. However, the growth of a keratoacanthoma retains its smooth
surface, unlike an SCC and a malignant melanoma.
Keratoacanthoma
presents as an enlarging well-demarcated erythematous plaque with an
irregular border but non-elevated.
Bowen’s disease
of the
skin begins as a small nodule that may become ulcerated and necrotic.
Bleeding is quite common and the clinical presentation is highly variable.
SCC
histopathology is spongiosis of epidermis and
perivascular chronic inflammatory infiltrate in the dermis. Acanthosis
(epidermal thickening) would develop if xx becomes chronic.
Eczema
will commonly present with
psoriatic nail lesions (pitting, onycholysis), dactylitis and tendinitis.
X-rays will show ‘new fluffy’ bone.
Psoriatic arthritis
a rheumatoid factor-seronegative, HLA B27-linked spondyloarthopathy
commonly affecting the larger joints (e.g. sacroiliac and
knee joints). Patients also sometimes develop circinate balanitis, keratoderma
blenorrhagica and enthesitis of the Achilles tendon
Reiter’s syndrome (Reactive arthritis)
Macroscopically, the
kidney is replaced by rounded masses of solid, fleshy, white lesions
with vast amounts of necrosis. Microscopically, it is composed of four
elements: immature-looking glomerular structures, primitive small cell
blastaematous tissue, epithelial tubules and stroma composed of spindle
cells and striated muscle.
Wilm’s
dWT1
is a benign epithelial tumour composed of large cells
with granular, eosinophilic cytoplasm filled with mitochondria. It has
little necrosis or haemorrhage. It is a variant of renal adenoma and is
often confused with renal cell carcinoma.
Oncocytoma
Only xx papillomas can present with nipple discharge that is blood
stained, while xxl papillomas can remain clinically silent.
Central
Peripheral
is a
benign sclerosing lesion characterized by a central zone of scarring surrounded
by a radiating zone of proliferating glandular tissue. They are
common and usually present as stellate masses on screening mammograms.
Radial scar
B1 to B5b grading
- B1 = normal breast tissue.
- B2 = benign abnormality (A)
- B3 = lesion of uncertain malignant potential (B)
- B4 = suspicious of malignancy (E)
- B5 = malignant
- B5a = ductal carcinoma in situ (C)
- B5b = invasive carcinoma
is a failure of
differentiation of metanephric tissues, it is typically asymptomatic and
it is not hereditary in nature but developmental, therefore often presenting
in childhood.
Cystic renal dysplasia
is occasionally a familial condition that
does not impair renal function and presents with renal stones predisposing
to renal colic and infections.
Medullary sponge disease
Meningitis in people with surgical shunts
Staph aureus and gram negative rods are the most comon cause